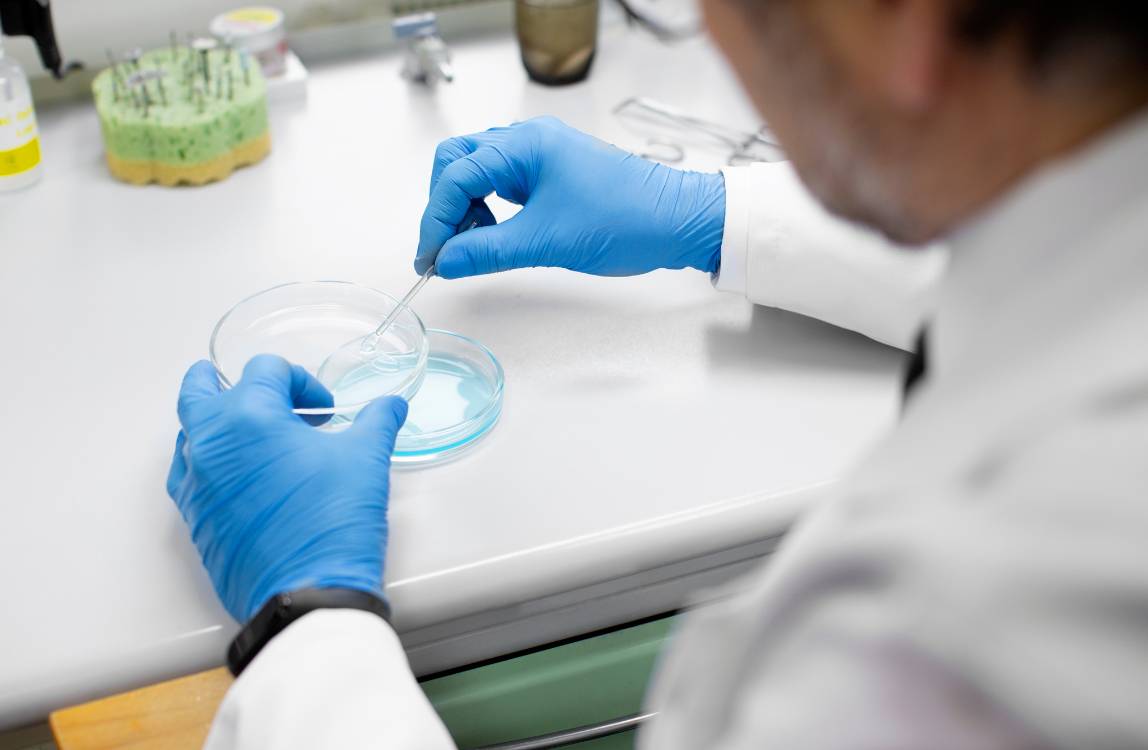

THE BASE
Nature's answer to itchy dogs - this revolutionary probiotic-enzyme spray brings immediate cooling relief while tackling surface irritants that trigger scratching.
Perfect for dogs with persistent itching or skin irritation, sensitive skin, seasonal allergies, or those prone to hot spots and skin irritations.
Couldn't load pickup availability
skinQR Anti-Itch Spray (30ml)
100% 30-day money-back guarantee. You and your dog will love it, or we refund your product purchase cost in full. You can even send back and empty pack and we’ll still refund you.
Shipped and delivered in 3-5 days



Itching and skin irritation in dogs can have various causes, such as allergies, insect bites, dry skin, or contact with irritants. It's important to soothe the skin and support its recovery to prevent further damage and discomfort.
Our Anti-Itch Spray is specially formulated to provide fast relief from itching and skin irritation. The natural ingredients hydrate, soothe, and protect the skin.
Primary skin conditions this spray helps:
Conditions it can support (but won't cure):

The spray delivers a triple-action approach to itch relief:
Think of it as giving your dog's skin a protective army of good bacteria while washing away the irritants causing the itch.
Expect the following results:
This spray provides symptomatic relief from itching and supports sensitive skin but doesn't treat underlying root causes, such as disturbed gut health and weakened immune system.

Which conditions won't the Anti-itch Spray help?
This spray won't treat:
How to use the Anti-itch Spray?
Is the Anti-itch Spray natural?
Yes! This spray is 100% natural with just three ingredients: water, beneficial bacteria with their natural enzymes, and hydrolyzed protein. No chemicals, fragrances, or synthetic additives - just nature's own skin soothers.
Is Anti-Itch Spray safe for my pet and for people?
Yes, Anti-Itch Spray is completely safe for both pets and people. It can even be sprayed on open wounds without any harmful effects, and it's perfectly fine if your pet licks it.
How often should I use Anti-Itch Spray?
The frequency of use depends on the severity of the problem. For persistent odors or severe itching, you can use Anti-Itch Spray daily. For maintenance, a few times a week is sufficient.
Does Anti-Itch Spray also work against fleas?
Anti-Itch Spray can help reduce the itching caused by flea bites, but it doesn't eliminate the fleas themselves. Use Anti-Itch Spray in combination with a flea control product for best results.
What are the exact ingredients of the anti-itch spray?
95% Water, 4% Bacterial Complex with Amylase and Protease, 1% Hydrolyzed Protein
Ihr Hund erfährt schnelle Erleichterung, während die tiefere Heilung beginnt
Wenn Sie Ihrem Hund zum ersten Mal gutQR Anti-Itch geben, beginnt das schnell wirkende Trio aus PEA, Boswellia und MSM sofort zu wirken. PEA (eine natürliche Verbindung, die der Körper Ihres Hundes bereits selbst produziert) blockiert diese dringenden "Juckreizsignale" direkt an der Quelle – wie das Herunterdrehen der Lautstärke eines Alarms. Gleichzeitig reduzieren Boswellia und MSM schnell die Entzündung, die die Haut Ihres Hundes heiß, gereizt und verzweifelt juckend fühlen lässt.
Was Sie bemerken werden: Weniger verzweifeltes Kratzen, reduziertes Pfotenlecken und ein ruhigerer, entspannterer Hund – normalerweise innerhalb der ersten 2 Wochen (unter Berücksichtigung der kleineren Einführungsdosis von gutQR Anti-Itch für die erste Anwendungswoche)
Die echte Arbeit geschieht von innen nach außen
Während Ihr Hund die erste Linderung genießt, bekämpft die kraftvolle Mischung von gutQR die zugrundeliegenden Probleme, die chronischen Juckreiz verursachen:
Wiederherstellung der Darmgesundheit: Unsere 10 Milliarden KBE Probiotika (einschließlich deutsches Biosprint® und japanisches Calsporin®) bringen das Darmmikrobiom Ihres Hundes wieder ins Gleichgewicht. Da 70% des Immunsystems im Darm sitzen, stoppt die Behebung von Darmproblemen oft Hautprobleme an der Quelle.
Beruhigung des Immunsystems: Premium deutsches Kolostrum (B.I.O.Ig mit 20% IgG) hilft, das Immunsystem Ihres Hundes zu trainieren, nicht mehr auf alltägliche Auslöser wie Pollen, Staub oder bestimmte Nahrungsmittel überzureagieren – und durchbricht so den Allergie-Juckreiz-Kreislauf.
Entzündungskontrolle: DHA aus Algen und GLA aus Nachtkerze wirken im ganzen Körper Ihres Hundes, um die systemische Entzündung zu reduzieren, die sich als rote, juckende Haut zeigt.
Verbesserte Darmunterstützung: Präbiotika nähren die guten Bakterien, während Postbiotika fertige Immunverbindungen liefern und den inneren Heilungsprozess Ihres Hundes beschleunigen.
Was Sie bemerken werden: Allmählich weniger Kratzen insgesamt, weniger Schübe, verbesserte Verdauung, festere Kotkonsistenz und ein glücklicherer, energiegeladenerer Hund.
Langfristiger Schutz von innen heraus
Während die Ursachen behoben werden, bauen die hautpflegenden Inhaltsstoffe von gutQR die natürlichen Abwehrkräfte Ihres Hundes wieder auf:
Barriere-Reparatur: Bioverfügbares Zinpro® Zink, Biotin und B-Vitamine stärken die schützende Hautbarriere und machen sie widerstandsfähiger gegen Reizstoffe und Allergene.
Tiefe Nährstoffversorgung: Vitamin E und Heidelbeer-Antioxidantien schützen Hautzellen vor Schäden und fördern gleichzeitig Heilung und Regeneration.
Sichtbare Transformation: Die Kombination aus reduzierter Entzündung, besserer Nährstoffaufnahme und direkter Hautunterstützung führt zu gesünderer Haut und einem sichtbar glänzenderen, weicheren Fell.
Was Sie bemerken werden: Das Fell Ihres Hundes wird glänzend und voll, die Haut sieht gesund aus (nicht rot oder schuppig), saisonale Allergien werden weniger schwer, und am wichtigsten – Ihr Hund kann endlich das Leben ohne ständigen Juckreiz genießen.
Ihr Hund erfährt schnelle Erleichterung, während die tiefere Heilung beginnt
Wenn Sie Ihrem Hund zum ersten Mal gutQR Anti-Itch geben, beginnt das schnell wirkende Trio aus PEA, Boswellia und MSM sofort zu wirken. PEA (eine natürliche Verbindung, die der Körper Ihres Hundes bereits selbst produziert) blockiert diese dringenden "Juckreizsignale" direkt an der Quelle – wie das Herunterdrehen der Lautstärke eines Alarms. Gleichzeitig reduzieren Boswellia und MSM schnell die Entzündung, die die Haut Ihres Hundes heiß, gereizt und verzweifelt juckend fühlen lässt.
Was Sie bemerken werden: Weniger verzweifeltes Kratzen, reduziertes Pfotenlecken und ein ruhigerer, entspannterer Hund – normalerweise innerhalb der ersten 2 Wochen (unter Berücksichtigung der kleineren Einführungsdosis von gutQR Anti-Itch für die erste Anwendungswoche)
Die echte Arbeit geschieht von innen nach außen
Während Ihr Hund die erste Linderung genießt, bekämpft die kraftvolle Mischung von gutQR die zugrundeliegenden Probleme, die chronischen Juckreiz verursachen:
Wiederherstellung der Darmgesundheit: Unsere 10 Milliarden KBE Probiotika (einschließlich deutsches Biosprint® und japanisches Calsporin®) bringen das Darmmikrobiom Ihres Hundes wieder ins Gleichgewicht. Da 70% des Immunsystems im Darm sitzen, stoppt die Behebung von Darmproblemen oft Hautprobleme an der Quelle.
Beruhigung des Immunsystems: Premium deutsches Kolostrum (B.I.O.Ig mit 20% IgG) hilft, das Immunsystem Ihres Hundes zu trainieren, nicht mehr auf alltägliche Auslöser wie Pollen, Staub oder bestimmte Nahrungsmittel überzureagieren – und durchbricht so den Allergie-Juckreiz-Kreislauf.
Entzündungskontrolle: DHA aus Algen und GLA aus Nachtkerze wirken im ganzen Körper Ihres Hundes, um die systemische Entzündung zu reduzieren, die sich als rote, juckende Haut zeigt.
Verbesserte Darmunterstützung: Präbiotika nähren die guten Bakterien, während Postbiotika fertige Immunverbindungen liefern und den inneren Heilungsprozess Ihres Hundes beschleunigen.
Was Sie bemerken werden: Allmählich weniger Kratzen insgesamt, weniger Schübe, verbesserte Verdauung, festere Kotkonsistenz und ein glücklicherer, energiegeladenerer Hund.
Langfristiger Schutz von innen heraus
Während die Ursachen behoben werden, bauen die hautpflegenden Inhaltsstoffe von gutQR die natürlichen Abwehrkräfte Ihres Hundes wieder auf:
Barriere-Reparatur: Bioverfügbares Zinpro® Zink, Biotin und B-Vitamine stärken die schützende Hautbarriere und machen sie widerstandsfähiger gegen Reizstoffe und Allergene.
Tiefe Nährstoffversorgung: Vitamin E und Heidelbeer-Antioxidantien schützen Hautzellen vor Schäden und fördern gleichzeitig Heilung und Regeneration.
Sichtbare Transformation: Die Kombination aus reduzierter Entzündung, besserer Nährstoffaufnahme und direkter Hautunterstützung führt zu gesünderer Haut und einem sichtbar glänzenderen, weicheren Fell.
Was Sie bemerken werden: Das Fell Ihres Hundes wird glänzend und voll, die Haut sieht gesund aus (nicht rot oder schuppig), saisonale Allergien werden weniger schwer, und am wichtigsten – Ihr Hund kann endlich das Leben ohne ständigen Juckreiz genießen.
Ihr Hund erfährt schnelle Erleichterung, während die tiefere Heilung beginnt
Wenn Sie Ihrem Hund zum ersten Mal gutQR Anti-Itch geben, beginnt das schnell wirkende Trio aus PEA, Boswellia und MSM sofort zu wirken. PEA (eine natürliche Verbindung, die der Körper Ihres Hundes bereits selbst produziert) blockiert diese dringenden "Juckreizsignale" direkt an der Quelle – wie das Herunterdrehen der Lautstärke eines Alarms. Gleichzeitig reduzieren Boswellia und MSM schnell die Entzündung, die die Haut Ihres Hundes heiß, gereizt und verzweifelt juckend fühlen lässt.
Was Sie bemerken werden: Weniger verzweifeltes Kratzen, reduziertes Pfotenlecken und ein ruhigerer, entspannterer Hund – normalerweise innerhalb der ersten 2 Wochen (unter Berücksichtigung der kleineren Einführungsdosis von gutQR Anti-Itch für die erste Anwendungswoche)
Die echte Arbeit geschieht von innen nach außen
Während Ihr Hund die erste Linderung genießt, bekämpft die kraftvolle Mischung von gutQR die zugrundeliegenden Probleme, die chronischen Juckreiz verursachen:
Wiederherstellung der Darmgesundheit: Unsere 10 Milliarden KBE Probiotika (einschließlich deutsches Biosprint® und japanisches Calsporin®) bringen das Darmmikrobiom Ihres Hundes wieder ins Gleichgewicht. Da 70% des Immunsystems im Darm sitzen, stoppt die Behebung von Darmproblemen oft Hautprobleme an der Quelle.
Beruhigung des Immunsystems: Premium deutsches Kolostrum (B.I.O.Ig mit 20% IgG) hilft, das Immunsystem Ihres Hundes zu trainieren, nicht mehr auf alltägliche Auslöser wie Pollen, Staub oder bestimmte Nahrungsmittel überzureagieren – und durchbricht so den Allergie-Juckreiz-Kreislauf.
Entzündungskontrolle: DHA aus Algen und GLA aus Nachtkerze wirken im ganzen Körper Ihres Hundes, um die systemische Entzündung zu reduzieren, die sich als rote, juckende Haut zeigt.
Verbesserte Darmunterstützung: Präbiotika nähren die guten Bakterien, während Postbiotika fertige Immunverbindungen liefern und den inneren Heilungsprozess Ihres Hundes beschleunigen.
Was Sie bemerken werden: Allmählich weniger Kratzen insgesamt, weniger Schübe, verbesserte Verdauung, festere Kotkonsistenz und ein glücklicherer, energiegeladenerer Hund.
Langfristiger Schutz von innen heraus
Während die Ursachen behoben werden, bauen die hautpflegenden Inhaltsstoffe von gutQR die natürlichen Abwehrkräfte Ihres Hundes wieder auf:
Barriere-Reparatur: Bioverfügbares Zinpro® Zink, Biotin und B-Vitamine stärken die schützende Hautbarriere und machen sie widerstandsfähiger gegen Reizstoffe und Allergene.
Tiefe Nährstoffversorgung: Vitamin E und Heidelbeer-Antioxidantien schützen Hautzellen vor Schäden und fördern gleichzeitig Heilung und Regeneration.
Sichtbare Transformation: Die Kombination aus reduzierter Entzündung, besserer Nährstoffaufnahme und direkter Hautunterstützung führt zu gesünderer Haut und einem sichtbar glänzenderen, weicheren Fell.
Was Sie bemerken werden: Das Fell Ihres Hundes wird glänzend und voll, die Haut sieht gesund aus (nicht rot oder schuppig), saisonale Allergien werden weniger schwer, und am wichtigsten – Ihr Hund kann endlich das Leben ohne ständigen Juckreiz genießen.
Il tuo cane ottiene un rapido comfort mentre inizia la guarigione profonda
Quando dai per la prima volta gutQR Anti-Itch al tuo cane, il trio ad azione rapida di PEA, Boswellia e MSM inizia immediatamente a lavorare. Il PEA (un composto naturale che il corpo del tuo cane già produce) blocca quei "segnali di prurito" urgenti alla fonte—come abbassare il volume di un allarme. Nel frattempo, Boswellia e MSM riducono rapidamente l'infiammazione che fa sentire la pelle del tuo cane calda, irritata e disperatamente pruriginosa.
Cosa noterai: Meno grattamento frenetico, ridotto leccamento delle zampe e un cane più calmo e confortevole — di solito entro le prime 2 settimane (considerando la dose introduttiva più piccola di gutQR Anti-Itch per la prima settimana d'uso)
Il vero lavoro avviene dall'interno verso l'esterno
Mentre il tuo cane gode del sollievo iniziale, la potente miscela di gutQR affronta i problemi sottostanti che causano il prurito cronico:
Ripristino della salute intestinale: I nostri 10 miliardi di UFC di probiotici (inclusi Biosprint® tedesco e Calsporin® giapponese) riequilibrano il microbioma intestinale del tuo cane. Poiché il 70% del sistema immunitario risiede nell'intestino, risolvere i problemi intestinali spesso ferma i problemi cutanei alla fonte.
Calmare il sistema immunitario: Il colostro tedesco premium (B.I.O.Ig con 20% IgG) aiuta ad allenare il sistema immunitario del tuo cane a smettere di reagire eccessivamente ai trigger quotidiani come polline, polvere o certi alimenti—spezzando il ciclo allergia-prurito.
Controllo dell'infiammazione: DHA da alghe e GLA da enotera agiscono in tutto il corpo del tuo cane per ridurre l'infiammazione sistemica che si manifesta come pelle rossa e pruriginosa.
Supporto intestinale potenziato: I prebiotici nutrono i batteri buoni mentre i postbiotici forniscono composti immunitari già pronti, accelerando il processo di guarigione interno del tuo cane.
Cosa noterai: Gradualmente meno grattamento generale, meno episodi acuti, digestione migliorata, feci più regolari e un cane più felice e pieno di energia.
Protezione a lungo termine dall'interno verso l'esterno
Man mano che le cause alla radice si risolvono, gli ingredienti nutrienti per la pelle di gutQR ricostruiscono le difese naturali del tuo cane:
Riparazione della barriera: Zinco biodisponibile Zinpro®, biotina e vitamine del gruppo B rafforzano la barriera protettiva della pelle, rendendola più resistente a irritanti e allergeni.
Nutrimento profondo: Vitamina E e antiossidanti del mirtillo proteggono le cellule cutanee dai danni mentre promuovono guarigione e rigenerazione.
Trasformazione visibile: La combinazione di infiammazione ridotta, migliore assorbimento dei nutrienti e supporto diretto alla pelle porta a una pelle più sana e un pelo visibilmente più lucido e morbido.
Cosa noterai: Il pelo del tuo cane diventa lucido e folto, la pelle appare sana (non rossa o con forfora), le allergie stagionali diventano meno gravi, e soprattutto — il tuo cane può finalmente godersi la vita senza prurito costante.
Il tuo cane ottiene un rapido comfort mentre inizia la guarigione profonda
Quando dai per la prima volta gutQR Anti-Itch al tuo cane, il trio ad azione rapida di PEA, Boswellia e MSM inizia immediatamente a lavorare. Il PEA (un composto naturale che il corpo del tuo cane già produce) blocca quei "segnali di prurito" urgenti alla fonte—come abbassare il volume di un allarme. Nel frattempo, Boswellia e MSM riducono rapidamente l'infiammazione che fa sentire la pelle del tuo cane calda, irritata e disperatamente pruriginosa.
Cosa noterai: Meno grattamento frenetico, ridotto leccamento delle zampe e un cane più calmo e confortevole — di solito entro le prime 2 settimane (considerando la dose introduttiva più piccola di gutQR Anti-Itch per la prima settimana d'uso)
Il vero lavoro avviene dall'interno verso l'esterno
Mentre il tuo cane gode del sollievo iniziale, la potente miscela di gutQR affronta i problemi sottostanti che causano il prurito cronico:
Ripristino della salute intestinale: I nostri 10 miliardi di UFC di probiotici (inclusi Biosprint® tedesco e Calsporin® giapponese) riequilibrano il microbioma intestinale del tuo cane. Poiché il 70% del sistema immunitario risiede nell'intestino, risolvere i problemi intestinali spesso ferma i problemi cutanei alla fonte.
Calmare il sistema immunitario: Il colostro tedesco premium (B.I.O.Ig con 20% IgG) aiuta ad allenare il sistema immunitario del tuo cane a smettere di reagire eccessivamente ai trigger quotidiani come polline, polvere o certi alimenti—spezzando il ciclo allergia-prurito.
Controllo dell'infiammazione: DHA da alghe e GLA da enotera agiscono in tutto il corpo del tuo cane per ridurre l'infiammazione sistemica che si manifesta come pelle rossa e pruriginosa.
Supporto intestinale potenziato: I prebiotici nutrono i batteri buoni mentre i postbiotici forniscono composti immunitari già pronti, accelerando il processo di guarigione interno del tuo cane.
Cosa noterai: Gradualmente meno grattamento generale, meno episodi acuti, digestione migliorata, feci più regolari e un cane più felice e pieno di energia.
Protezione a lungo termine dall'interno verso l'esterno
Man mano che le cause alla radice si risolvono, gli ingredienti nutrienti per la pelle di gutQR ricostruiscono le difese naturali del tuo cane:
Riparazione della barriera: Zinco biodisponibile Zinpro®, biotina e vitamine del gruppo B rafforzano la barriera protettiva della pelle, rendendola più resistente a irritanti e allergeni.
Nutrimento profondo: Vitamina E e antiossidanti del mirtillo proteggono le cellule cutanee dai danni mentre promuovono guarigione e rigenerazione.
Trasformazione visibile: La combinazione di infiammazione ridotta, migliore assorbimento dei nutrienti e supporto diretto alla pelle porta a una pelle più sana e un pelo visibilmente più lucido e morbido.
Cosa noterai: Il pelo del tuo cane diventa lucido e folto, la pelle appare sana (non rossa o con forfora), le allergie stagionali diventano meno gravi, e soprattutto — il tuo cane può finalmente godersi la vita senza prurito costante.
Il tuo cane ottiene un rapido comfort mentre inizia la guarigione profonda
Quando dai per la prima volta gutQR Anti-Itch al tuo cane, il trio ad azione rapida di PEA, Boswellia e MSM inizia immediatamente a lavorare. Il PEA (un composto naturale che il corpo del tuo cane già produce) blocca quei "segnali di prurito" urgenti alla fonte—come abbassare il volume di un allarme. Nel frattempo, Boswellia e MSM riducono rapidamente l'infiammazione che fa sentire la pelle del tuo cane calda, irritata e disperatamente pruriginosa.
Cosa noterai: Meno grattamento frenetico, ridotto leccamento delle zampe e un cane più calmo e confortevole — di solito entro le prime 2 settimane (considerando la dose introduttiva più piccola di gutQR Anti-Itch per la prima settimana d'uso)
Il vero lavoro avviene dall'interno verso l'esterno
Mentre il tuo cane gode del sollievo iniziale, la potente miscela di gutQR affronta i problemi sottostanti che causano il prurito cronico:
Ripristino della salute intestinale: I nostri 10 miliardi di UFC di probiotici (inclusi Biosprint® tedesco e Calsporin® giapponese) riequilibrano il microbioma intestinale del tuo cane. Poiché il 70% del sistema immunitario risiede nell'intestino, risolvere i problemi intestinali spesso ferma i problemi cutanei alla fonte.
Calmare il sistema immunitario: Il colostro tedesco premium (B.I.O.Ig con 20% IgG) aiuta ad allenare il sistema immunitario del tuo cane a smettere di reagire eccessivamente ai trigger quotidiani come polline, polvere o certi alimenti—spezzando il ciclo allergia-prurito.
Controllo dell'infiammazione: DHA da alghe e GLA da enotera agiscono in tutto il corpo del tuo cane per ridurre l'infiammazione sistemica che si manifesta come pelle rossa e pruriginosa.
Supporto intestinale potenziato: I prebiotici nutrono i batteri buoni mentre i postbiotici forniscono composti immunitari già pronti, accelerando il processo di guarigione interno del tuo cane.
Cosa noterai: Gradualmente meno grattamento generale, meno episodi acuti, digestione migliorata, feci più regolari e un cane più felice e pieno di energia.
Protezione a lungo termine dall'interno verso l'esterno
Man mano che le cause alla radice si risolvono, gli ingredienti nutrienti per la pelle di gutQR ricostruiscono le difese naturali del tuo cane:
Riparazione della barriera: Zinco biodisponibile Zinpro®, biotina e vitamine del gruppo B rafforzano la barriera protettiva della pelle, rendendola più resistente a irritanti e allergeni.
Nutrimento profondo: Vitamina E e antiossidanti del mirtillo proteggono le cellule cutanee dai danni mentre promuovono guarigione e rigenerazione.
Trasformazione visibile: La combinazione di infiammazione ridotta, migliore assorbimento dei nutrienti e supporto diretto alla pelle porta a una pelle più sana e un pelo visibilmente più lucido e morbido.
Cosa noterai: Il pelo del tuo cane diventa lucido e folto, la pelle appare sana (non rossa o con forfora), le allergie stagionali diventano meno gravi, e soprattutto — il tuo cane può finalmente godersi la vita senza prurito costante.
Your dog gets quick comfort while deeper healing begins
When you first give gutQR Anti-Itch to your dog, the fast-acting trio of PEA, Boswellia, and MSM immediately goes to work. PEA (a natural compound your dog's body already produces) blocks those urgent "itch signals" at their source—like turning down the volume on an alarm. Meanwhile, Boswellia and MSM quickly reduce the inflammation that makes your dog's skin feel hot, irritated, and desperately itchy.
What you'll notice: Less frantic scratching, reduced paw licking, and a calmer, more comfortable dog — usually within the first 2 weeks (considering the smaller introductory dose of gutQR Anti-Itch for the first week of usage)
The real work happens from the inside out
While your dog enjoys initial relief, gutQR's powerful blend addresses the underlying problems that cause chronic itching:
Gut Health Restoration: Our 10 billion CFU probiotics (including German Biosprint® and Japanese Calsporin®) rebalance your dog's gut microbiome. Since 70% of the immune system lives in the gut, fixing gut problems often stops skin problems at their source.
Immune System Calming: Premium German colostrum (B.I.O.Ig with 20% IgG) helps train your dog's immune system to stop overreacting to everyday triggers like pollen, dust, or certain foods—breaking the allergy-itch cycle.
Inflammation Control: Algae-sourced DHA and evening primrose GLA work throughout your dog's body to reduce the systemic inflammation that shows up as red, itchy skin.
Enhanced Gut Support: Prebiotics feed the good bacteria while postbiotics provide ready-made immune compounds, accelerating your dog's internal healing process.
What you'll notice: Gradually less scratching overall, fewer flare-ups, improved digestion, firmer stools, and a happier, more energetic dog.
Long-term protection from the inside out
As the root causes resolve, gutQR's skin-nourishing ingredients rebuild your dog's natural defenses:
Barrier Repair: Bioavailable Zinpro® zinc, biotin, and B-vitamins strengthen the skin's protective barrier, making it more resistant to irritants and allergens.
Deep Nourishment: Vitamin E and blueberry antioxidants protect skin cells from damage while promoting healing and regeneration.
Visible Transformation: The combination of reduced inflammation, better nutrition absorption, and direct skin support results in healthier skin and a noticeably shinier, softer coat.
What you'll notice: Your dog's coat becomes lustrous and full, skin looks healthy (not red or flaky), seasonal allergies become less severe, and most importantly — your dog can finally enjoy life without constant itching.
Your dog gets quick comfort while deeper healing begins
When you first give gutQR Anti-Itch to your dog, the fast-acting trio of PEA, Boswellia, and MSM immediately goes to work. PEA (a natural compound your dog's body already produces) blocks those urgent "itch signals" at their source—like turning down the volume on an alarm. Meanwhile, Boswellia and MSM quickly reduce the inflammation that makes your dog's skin feel hot, irritated, and desperately itchy.
What you'll notice: Less frantic scratching, reduced paw licking, and a calmer, more comfortable dog — usually within the first 2 weeks (considering the smaller introductory dose of gutQR Anti-Itch for the first week of usage)
The real work happens from the inside out
While your dog enjoys initial relief, gutQR's powerful blend addresses the underlying problems that cause chronic itching:
Gut Health Restoration: Our 10 billion CFU probiotics (including German Biosprint® and Japanese Calsporin®) rebalance your dog's gut microbiome. Since 70% of the immune system lives in the gut, fixing gut problems often stops skin problems at their source.
Immune System Calming: Premium German colostrum (B.I.O.Ig with 20% IgG) helps train your dog's immune system to stop overreacting to everyday triggers like pollen, dust, or certain foods—breaking the allergy-itch cycle.
Inflammation Control: Algae-sourced DHA and evening primrose GLA work throughout your dog's body to reduce the systemic inflammation that shows up as red, itchy skin.
Enhanced Gut Support: Prebiotics feed the good bacteria while postbiotics provide ready-made immune compounds, accelerating your dog's internal healing process.
What you'll notice: Gradually less scratching overall, fewer flare-ups, improved digestion, firmer stools, and a happier, more energetic dog.
Long-term protection from the inside out
As the root causes resolve, gutQR's skin-nourishing ingredients rebuild your dog's natural defenses:
Barrier Repair: Bioavailable Zinpro® zinc, biotin, and B-vitamins strengthen the skin's protective barrier, making it more resistant to irritants and allergens.
Deep Nourishment: Vitamin E and blueberry antioxidants protect skin cells from damage while promoting healing and regeneration.
Visible Transformation: The combination of reduced inflammation, better nutrition absorption, and direct skin support results in healthier skin and a noticeably shinier, softer coat.
What you'll notice: Your dog's coat becomes lustrous and full, skin looks healthy (not red or flaky), seasonal allergies become less severe, and most importantly — your dog can finally enjoy life without constant itching.
Your dog gets quick comfort while deeper healing begins
When you first give gutQR Anti-Itch to your dog, the fast-acting trio of PEA, Boswellia, and MSM immediately goes to work. PEA (a natural compound your dog's body already produces) blocks those urgent "itch signals" at their source—like turning down the volume on an alarm. Meanwhile, Boswellia and MSM quickly reduce the inflammation that makes your dog's skin feel hot, irritated, and desperately itchy.
What you'll notice: Less frantic scratching, reduced paw licking, and a calmer, more comfortable dog — usually within the first 2 weeks (considering the smaller introductory dose of gutQR Anti-Itch for the first week of usage)
The real work happens from the inside out
While your dog enjoys initial relief, gutQR's powerful blend addresses the underlying problems that cause chronic itching:
Gut Health Restoration: Our 10 billion CFU probiotics (including German Biosprint® and Japanese Calsporin®) rebalance your dog's gut microbiome. Since 70% of the immune system lives in the gut, fixing gut problems often stops skin problems at their source.
Immune System Calming: Premium German colostrum (B.I.O.Ig with 20% IgG) helps train your dog's immune system to stop overreacting to everyday triggers like pollen, dust, or certain foods—breaking the allergy-itch cycle.
Inflammation Control: Algae-sourced DHA and evening primrose GLA work throughout your dog's body to reduce the systemic inflammation that shows up as red, itchy skin.
Enhanced Gut Support: Prebiotics feed the good bacteria while postbiotics provide ready-made immune compounds, accelerating your dog's internal healing process.
What you'll notice: Gradually less scratching overall, fewer flare-ups, improved digestion, firmer stools, and a happier, more energetic dog.
Long-term protection from the inside out
As the root causes resolve, gutQR's skin-nourishing ingredients rebuild your dog's natural defenses:
Barrier Repair: Bioavailable Zinpro® zinc, biotin, and B-vitamins strengthen the skin's protective barrier, making it more resistant to irritants and allergens.
Deep Nourishment: Vitamin E and blueberry antioxidants protect skin cells from damage while promoting healing and regeneration.
Visible Transformation: The combination of reduced inflammation, better nutrition absorption, and direct skin support results in healthier skin and a noticeably shinier, softer coat.
What you'll notice: Your dog's coat becomes lustrous and full, skin looks healthy (not red or flaky), seasonal allergies become less severe, and most importantly — your dog can finally enjoy life without constant itching.
| Ingredienti | mg per porzione |
| Lievito (essiccato) TECHNO YEAST Idrolizzato | 680 |
| MOS (Mannooligosaccaridi) TECHNO MOS | 195,9 |
| Colostro in polvere B.I.O.lg 20% | 250 |
| BIOSPRINT Probiotico Saccharomyces cerevisiae MUCL 39885 (8,4 Miliardi di UFC) | 560 |
| Bacillus velezensis (Calsporin) (1 Miliardo di UFC) | 33,3 |
| Enterococcus faecium (1 Miliardo di UFC) | 28,6 |
| EpiCor Pets postbiotico | 70 |
| PEA (Palmitoiletanolamide) | 200 |
| Melissa (materia prima per mangimi) | 28,9 |
| Ortica (materia prima per mangimi) | 53,7 |
| FOS Estratto di radice di cicoria | 122 |
| Niacinamide (B3) | 17,3 |
| Vitamina B1 | 1,06 |
| Vitamina B2 | 0,532 |
| Vitamina B5 | 0,532 |
| Vitamina B6 | 0,532 |
| Vitamina B12 | 0,009 |
| Vitamina C | 0,178 |
| Biotina | 3,37 |
| Acido folico | 0,106 |
| Vitamina E (acetato in polvere) 50% Vit E | 31,1 |
| Polifenoli di mirtillo | 45,5 |
| DHA Gold (DHA da alghe) | 14,25 |
| HuvePure DHA 20% (DHA da alghe) | 119,8 |
| HA108 postbiotico | 6,73 |
| HA122 postbiotico | 6,61 |
| Olio di enotera in polvere | 41,3 |
| Boswellia | 95 |
| MSM | 62 |
| Zinco (Zinpro Availa) | 11,34 |
| Tocoferoli naturali (antiossidante) | 9,45 |
| Ingredienti | mg per porzione |
| Lievito (essiccato) TECHNO YEAST Idrolizzato | 680 |
| MOS (Mannooligosaccaridi) TECHNO MOS | 195,9 |
| Colostro in polvere B.I.O.lg 20% | 250 |
| BIOSPRINT Probiotico Saccharomyces cerevisiae MUCL 39885 (8,4 Miliardi di UFC) | 560 |
| Bacillus velezensis (Calsporin) (1 Miliardo di UFC) | 33,3 |
| Enterococcus faecium (1 Miliardo di UFC) | 28,6 |
| EpiCor Pets postbiotico | 70 |
| PEA (Palmitoiletanolamide) | 200 |
| Melissa (materia prima per mangimi) | 28,9 |
| Ortica (materia prima per mangimi) | 53,7 |
| FOS Estratto di radice di cicoria | 122 |
| Niacinamide (B3) | 17,3 |
| Vitamina B1 | 1,06 |
| Vitamina B2 | 0,532 |
| Vitamina B5 | 0,532 |
| Vitamina B6 | 0,532 |
| Vitamina B12 | 0,009 |
| Vitamina C | 0,178 |
| Biotina | 3,37 |
| Acido folico | 0,106 |
| Vitamina E (acetato in polvere) 50% Vit E | 31,1 |
| Polifenoli di mirtillo | 45,5 |
| DHA Gold (DHA da alghe) | 14,25 |
| HuvePure DHA 20% (DHA da alghe) | 119,8 |
| HA108 postbiotico | 6,73 |
| HA122 postbiotico | 6,61 |
| Olio di enotera in polvere | 41,3 |
| Boswellia | 95 |
| MSM | 62 |
| Zinco (Zinpro Availa) | 11,34 |
| Tocoferoli naturali (antiossidante) | 9,45 |
| Ingredienti | mg per porzione |
| Lievito (essiccato) TECHNO YEAST Idrolizzato | 680 |
| MOS (Mannooligosaccaridi) TECHNO MOS | 195,9 |
| Colostro in polvere B.I.O.lg 20% | 250 |
| BIOSPRINT Probiotico Saccharomyces cerevisiae MUCL 39885 (8,4 Miliardi di UFC) | 560 |
| Bacillus velezensis (Calsporin) (1 Miliardo di UFC) | 33,3 |
| Enterococcus faecium (1 Miliardo di UFC) | 28,6 |
| EpiCor Pets postbiotico | 70 |
| PEA (Palmitoiletanolamide) | 200 |
| Melissa (materia prima per mangimi) | 28,9 |
| Ortica (materia prima per mangimi) | 53,7 |
| FOS Estratto di radice di cicoria | 122 |
| Niacinamide (B3) | 17,3 |
| Vitamina B1 | 1,06 |
| Vitamina B2 | 0,532 |
| Vitamina B5 | 0,532 |
| Vitamina B6 | 0,532 |
| Vitamina B12 | 0,009 |
| Vitamina C | 0,178 |
| Biotina | 3,37 |
| Acido folico | 0,106 |
| Vitamina E (acetato in polvere) 50% Vit E | 31,1 |
| Polifenoli di mirtillo | 45,5 |
| DHA Gold (DHA da alghe) | 14,25 |
| HuvePure DHA 20% (DHA da alghe) | 119,8 |
| HA108 postbiotico | 6,73 |
| HA122 postbiotico | 6,61 |
| Olio di enotera in polvere | 41,3 |
| Boswellia | 95 |
| MSM | 62 |
| Zinco (Zinpro Availa) | 11,34 |
| Tocoferoli naturali (antiossidante) | 9,45 |
| Inhaltsstoffe | mg pro Portion |
| Hefe (getrocknet) TECHNO YEAST Hydrolysiert | 680 |
| MOS (Mannooligosaccharide) TECHNO MOS | 195,9 |
| Kolostrum-Pulver B.I.O.lg 20% | 250 |
| BIOSPRINT Probiotikum Saccharomyces cerevisiae MUCL 39885 (8,4 Milliarden KBE) | 560 |
| Bacillus velezensis (Calsporin) (1 Milliarde KBE) | 33,3 |
| Enterococcus faecium (1 Milliarde KBE) | 28,6 |
| EpiCor Pets Postbiotikum | 70 |
| PEA (Palmitoylethanolamid) | 200 |
| Zitronenmelisse (Futtermittel) | 28,9 |
| Brennnessel (Futtermittel) | 53,7 |
| FOS Zichorienwurzel-Extrakt | 122 |
| Niacinamid (B3) | 17,3 |
| Vitamin B1 | 1,06 |
| Vitamin B2 | 0,532 |
| Vitamin B5 | 0,532 |
| Vitamin B6 | 0,532 |
| Vitamin B12 | 0,009 |
| Vitamin C | 0,178 |
| Biotin | 3,37 |
| Folsäure | 0,106 |
| Vitamin E (Acetat-Pulver) 50% Vit E | 31,1 |
| Heidelbeer-Polyphenole | 45,5 |
| DHA Gold (Algen-DHA) | 14,25 |
| HuvePure DHA 20% (Algen-DHA) | 119,8 |
| HA108 Postbiotikum | 6,73 |
| HA122 Postbiotikum | 6,61 |
| Nachtkerzenöl-Pulver | 41,3 |
| Boswellia | 95 |
| MSM | 62 |
| Zink (Zinpro Availa) | 11,34 |
| Natürliche Tocopherole (Antioxidans) | 9,45 |
| Inhaltsstoffe | mg pro Portion |
| Hefe (getrocknet) TECHNO YEAST Hydrolysiert | 680 |
| MOS (Mannooligosaccharide) TECHNO MOS | 195,9 |
| Kolostrum-Pulver B.I.O.lg 20% | 250 |
| BIOSPRINT Probiotikum Saccharomyces cerevisiae MUCL 39885 (8,4 Milliarden KBE) | 560 |
| Bacillus velezensis (Calsporin) (1 Milliarde KBE) | 33,3 |
| Enterococcus faecium (1 Milliarde KBE) | 28,6 |
| EpiCor Pets Postbiotikum | 70 |
| PEA (Palmitoylethanolamid) | 200 |
| Zitronenmelisse (Futtermittel) | 28,9 |
| Brennnessel (Futtermittel) | 53,7 |
| FOS Zichorienwurzel-Extrakt | 122 |
| Niacinamid (B3) | 17,3 |
| Vitamin B1 | 1,06 |
| Vitamin B2 | 0,532 |
| Vitamin B5 | 0,532 |
| Vitamin B6 | 0,532 |
| Vitamin B12 | 0,009 |
| Vitamin C | 0,178 |
| Biotin | 3,37 |
| Folsäure | 0,106 |
| Vitamin E (Acetat-Pulver) 50% Vit E | 31,1 |
| Heidelbeer-Polyphenole | 45,5 |
| DHA Gold (Algen-DHA) | 14,25 |
| HuvePure DHA 20% (Algen-DHA) | 119,8 |
| HA108 Postbiotikum | 6,73 |
| HA122 Postbiotikum | 6,61 |
| Nachtkerzenöl-Pulver | 41,3 |
| Boswellia | 95 |
| MSM | 62 |
| Zink (Zinpro Availa) | 11,34 |
| Natürliche Tocopherole (Antioxidans) | 9,45 |
| Inhaltsstoffe | mg pro Portion |
| Hefe (getrocknet) TECHNO YEAST Hydrolysiert | 680 |
| MOS (Mannooligosaccharide) TECHNO MOS | 195,9 |
| Kolostrum-Pulver B.I.O.lg 20% | 250 |
| BIOSPRINT Probiotikum Saccharomyces cerevisiae MUCL 39885 (8,4 Milliarden KBE) | 560 |
| Bacillus velezensis (Calsporin) (1 Milliarde KBE) | 33,3 |
| Enterococcus faecium (1 Milliarde KBE) | 28,6 |
| EpiCor Pets Postbiotikum | 70 |
| PEA (Palmitoylethanolamid) | 200 |
| Zitronenmelisse (Futtermittel) | 28,9 |
| Brennnessel (Futtermittel) | 53,7 |
| FOS Zichorienwurzel-Extrakt | 122 |
| Niacinamid (B3) | 17,3 |
| Vitamin B1 | 1,06 |
| Vitamin B2 | 0,532 |
| Vitamin B5 | 0,532 |
| Vitamin B6 | 0,532 |
| Vitamin B12 | 0,009 |
| Vitamin C | 0,178 |
| Biotin | 3,37 |
| Folsäure | 0,106 |
| Vitamin E (Acetat-Pulver) 50% Vit E | 31,1 |
| Heidelbeer-Polyphenole | 45,5 |
| DHA Gold (Algen-DHA) | 14,25 |
| HuvePure DHA 20% (Algen-DHA) | 119,8 |
| HA108 Postbiotikum | 6,73 |
| HA122 Postbiotikum | 6,61 |
| Nachtkerzenöl-Pulver | 41,3 |
| Boswellia | 95 |
| MSM | 62 |
| Zink (Zinpro Availa) | 11,34 |
| Natürliche Tocopherole (Antioxidans) | 9,45 |
Pasje srbenje, praskanje, lizanje tačk in prebavne težave pogosto izvirajo iz nezdravega črevesja, kjer škodljive bakterije prevladajo nad dobrimi. To sproži vnetje, ki vpliva na kožo in oslabi imunski sistem.
Belly Biotics ponujajo celovito rešitev s 3 dokazanimi koraki:
1 - Obnavlja zdravje črevesja
a) Prebiotiki hranijo dobre bakterije v črevesju, jim pomagajo uspevati in ustvariti uravnoteženo okolje.
b) Probiotiki dodajajo žive koristne bakterije za obnovitev zdravja črevesja.
c) Postbiotiki zagotavljajo že pripravljene koristne spojine (metabolite), ki izboljšajo delovanje črevesja in zmanjšajo vnetje.
2 - Popravlja oslabljen imunski sistem
Prebiotiki, probiotiki in postbiotiki skupaj, s podporo kurkume, krepijo imunski sistem. To pomaga imunskemu sistemu vašega psa v boju proti okužbam in pri naravnem zdravljenju poškodovane kože.
3 - Neposredno hrani kožo in dlako
Mešanica biotina, kurkume, cinka in alginega olja za neposredno podporo zdravju kože vašega psa, pomirjanje srbenja in podporo zdravi dlaki. Poleg tega vidni rezultati: manj izpadanja dlake, več sijaja in srečnejši, bolj zdrav pes.
Pasje srbenje, praskanje, lizanje tačk in prebavne težave pogosto izvirajo iz nezdravega črevesja, kjer škodljive bakterije prevladajo nad dobrimi. To sproži vnetje, ki vpliva na kožo in oslabi imunski sistem.
Belly Biotics ponujajo celovito rešitev s 3 dokazanimi koraki:
1 - Obnavlja zdravje črevesja
a) Prebiotiki hranijo dobre bakterije v črevesju, jim pomagajo uspevati in ustvariti uravnoteženo okolje.
b) Probiotiki dodajajo žive koristne bakterije za obnovitev zdravja črevesja.
c) Postbiotiki zagotavljajo že pripravljene koristne spojine (metabolite), ki izboljšajo delovanje črevesja in zmanjšajo vnetje.
2 - Popravlja oslabljen imunski sistem
Prebiotiki, probiotiki in postbiotiki skupaj, s podporo kurkume, krepijo imunski sistem. To pomaga imunskemu sistemu vašega psa v boju proti okužbam in pri naravnem zdravljenju poškodovane kože.
3 - Neposredno hrani kožo in dlako
Mešanica biotina, kurkume, cinka in alginega olja za neposredno podporo zdravju kože vašega psa, pomirjanje srbenja in podporo zdravi dlaki. Poleg tega vidni rezultati: manj izpadanja dlake, več sijaja in srečnejši, bolj zdrav pes.
Pasje srbenje, praskanje, lizanje tačk in prebavne težave pogosto izvirajo iz nezdravega črevesja, kjer škodljive bakterije prevladajo nad dobrimi. To sproži vnetje, ki vpliva na kožo in oslabi imunski sistem.
Belly Biotics ponujajo celovito rešitev s 3 dokazanimi koraki:
1 - Obnavlja zdravje črevesja
a) Prebiotiki hranijo dobre bakterije v črevesju, jim pomagajo uspevati in ustvariti uravnoteženo okolje.
b) Probiotiki dodajajo žive koristne bakterije za obnovitev zdravja črevesja.
c) Postbiotiki zagotavljajo že pripravljene koristne spojine (metabolite), ki izboljšajo delovanje črevesja in zmanjšajo vnetje.
2 - Popravlja oslabljen imunski sistem
Prebiotiki, probiotiki in postbiotiki skupaj, s podporo kurkume, krepijo imunski sistem. To pomaga imunskemu sistemu vašega psa v boju proti okužbam in pri naravnem zdravljenju poškodovane kože.
3 - Neposredno hrani kožo in dlako
Mešanica biotina, kurkume, cinka in alginega olja za neposredno podporo zdravju kože vašega psa, pomirjanje srbenja in podporo zdravi dlaki. Poleg tega vidni rezultati: manj izpadanja dlake, več sijaja in srečnejši, bolj zdrav pes.
Sestava
Dehidrirane piščančje beljakovine (30 %), grahov škrob, mleti grah, svinjska mast, perutninska mast, mleto laneno seme (2 %), posušen pivski kvas (2 %), posušena cikorija (2 %, vir FOS in inulina), hidrolizirane piščančje beljakovine (jetra), olje alg (1 %) (vir EPA in DHA), kurkuma (1 %), lignoceluloza, kvasna celična stena (0.5 %, vir MOS in beta glukanov), dehidrirane piščančje beljakovine (jetra), lupina indijskega trpotca, minerali, deaktiviran Laktobacilus Helveticus HA-122 (1000 mg/kg)
Analitske sestavine
Surove beljakovine 30 %, vsebnost maščob 20 %, surova vlaknina 2,8 %, anorganske snovi 6,5 %
Prehranski dodatki (per kg)
Vitamini: Biotin 80 mg
Elementi v sledeh: Zn (cinkov kelat beljakovinskih hidrolizatov) 100 mg
Antioksidanti: Tokoferolni izvlečki iz rastlinskih olj (1b306(i))
Stabilizatorji črevesne flore: Bacillus velezensis DSM 15544 (4b1820) 3,63x10^11 CFU/kg
Dodatek k prahrani za odrasle pse. Psi morajo biti med hranjenjem ves čas pod nadzorom. Ne dajejte, če ima vaš hišni ljubljenček znano alergijo na piščanca. Zagotovite, da ima vaš hišni ljubljenček ves čas na voljo svežo pitno vodo. Hranite v hladnem in suhem prostoru. Po odprtju embalažo ponovno zaprite, da ohranite svežino.
Sestava
Dehidrirane piščančje beljakovine (30 %), grahov škrob, mleti grah, svinjska mast, perutninska mast, mleto laneno seme (2 %), posušen pivski kvas (2 %), posušena cikorija (2 %, vir FOS in inulina), hidrolizirane piščančje beljakovine (jetra), olje alg (1 %) (vir EPA in DHA), kurkuma (1 %), lignoceluloza, kvasna celična stena (0.5 %, vir MOS in beta glukanov), dehidrirane piščančje beljakovine (jetra), lupina indijskega trpotca, minerali, deaktiviran Laktobacilus Helveticus HA-122 (1000 mg/kg)
Analitske sestavine
Surove beljakovine 30 %, vsebnost maščob 20 %, surova vlaknina 2,8 %, anorganske snovi 6,5 %
Prehranski dodatki (per kg)
Vitamini: Biotin 80 mg
Elementi v sledeh: Zn (cinkov kelat beljakovinskih hidrolizatov) 100 mg
Antioksidanti: Tokoferolni izvlečki iz rastlinskih olj (1b306(i))
Stabilizatorji črevesne flore: Bacillus velezensis DSM 15544 (4b1820) 3,63x10^11 CFU/kg
Dodatek k prahrani za odrasle pse. Psi morajo biti med hranjenjem ves čas pod nadzorom. Ne dajejte, če ima vaš hišni ljubljenček znano alergijo na piščanca. Zagotovite, da ima vaš hišni ljubljenček ves čas na voljo svežo pitno vodo. Hranite v hladnem in suhem prostoru. Po odprtju embalažo ponovno zaprite, da ohranite svežino.
Sestava
Dehidrirane piščančje beljakovine (30 %), grahov škrob, mleti grah, svinjska mast, perutninska mast, mleto laneno seme (2 %), posušen pivski kvas (2 %), posušena cikorija (2 %, vir FOS in inulina), hidrolizirane piščančje beljakovine (jetra), olje alg (1 %) (vir EPA in DHA), kurkuma (1 %), lignoceluloza, kvasna celična stena (0.5 %, vir MOS in beta glukanov), dehidrirane piščančje beljakovine (jetra), lupina indijskega trpotca, minerali, deaktiviran Laktobacilus Helveticus HA-122 (1000 mg/kg)
Analitske sestavine
Surove beljakovine 30 %, vsebnost maščob 20 %, surova vlaknina 2,8 %, anorganske snovi 6,5 %
Prehranski dodatki (per kg)
Vitamini: Biotin 80 mg
Elementi v sledeh: Zn (cinkov kelat beljakovinskih hidrolizatov) 100 mg
Antioksidanti: Tokoferolni izvlečki iz rastlinskih olj (1b306(i))
Stabilizatorji črevesne flore: Bacillus velezensis DSM 15544 (4b1820) 3,63x10^11 CFU/kg
Dodatek k prahrani za odrasle pse. Psi morajo biti med hranjenjem ves čas pod nadzorom. Ne dajejte, če ima vaš hišni ljubljenček znano alergijo na piščanca. Zagotovite, da ima vaš hišni ljubljenček ves čas na voljo svežo pitno vodo. Hranite v hladnem in suhem prostoru. Po odprtju embalažo ponovno zaprite, da ohranite svežino.
gutQR je prehranski dodatek v prahu
Prah je boljši za vašega psa!
1. 100% čista formula brez polnil, dodatkov ali umetnih arom. Vsaka posamezna sestavina v gutQR ima koristno zdravstveno vlogo. 100% samo sestavine, ki pomagajo vašemu psu.
2. Ohranja probiotike žive. Agresivni proizvodni procesi pasjih priboljškov uničijo večino živih probiotikov. Dostava probiotikov v obliki prahu jih ohranja žive.
3. Omogoča formulo visoke učinkovitosti. Samo prah lahko dostavi toliko aktivnih surovin.
4. Stane vas manj, za boljši rezultat. Prihranke prenašamo na vas. Plačate samo za aktivne sestavine, ne pa za "polnila", ki ne naredijo ničesar za zdravje vašega psa.
5. Še vedno ima odličen okus! Psi obožujejo 100% naravni kvasec TechnoYEAST, zaradi katerega ima odličen okus.
6. Kaj če vašemu psu ni všeč? Ni problema! V celoti vam bomo povrnili denar, zato ni absolutno nobenega tveganja.
gutQR je prehranski dodatek v prahu
Prah je boljši za vašega psa!
1. 100% čista formula brez polnil, dodatkov ali umetnih arom. Vsaka posamezna sestavina v gutQR ima koristno zdravstveno vlogo. 100% samo sestavine, ki pomagajo vašemu psu.
2. Ohranja probiotike žive. Agresivni proizvodni procesi pasjih priboljškov uničijo večino živih probiotikov. Dostava probiotikov v obliki prahu jih ohranja žive.
3. Omogoča formulo visoke učinkovitosti. Samo prah lahko dostavi toliko aktivnih surovin.
4. Stane vas manj, za boljši rezultat. Prihranke prenašamo na vas. Plačate samo za aktivne sestavine, ne pa za "polnila", ki ne naredijo ničesar za zdravje vašega psa.
5. Še vedno ima odličen okus! Psi obožujejo 100% naravni kvasec TechnoYEAST, zaradi katerega ima odličen okus.
6. Kaj če vašemu psu ni všeč? Ni problema! V celoti vam bomo povrnili denar, zato ni absolutno nobenega tveganja.
gutQR je prehranski dodatek v prahu
Prah je boljši za vašega psa!
1. 100% čista formula brez polnil, dodatkov ali umetnih arom. Vsaka posamezna sestavina v gutQR ima koristno zdravstveno vlogo. 100% samo sestavine, ki pomagajo vašemu psu.
2. Ohranja probiotike žive. Agresivni proizvodni procesi pasjih priboljškov uničijo večino živih probiotikov. Dostava probiotikov v obliki prahu jih ohranja žive.
3. Omogoča formulo visoke učinkovitosti. Samo prah lahko dostavi toliko aktivnih surovin.
4. Stane vas manj, za boljši rezultat. Prihranke prenašamo na vas. Plačate samo za aktivne sestavine, ne pa za "polnila", ki ne naredijo ničesar za zdravje vašega psa.
5. Še vedno ima odličen okus! Psi obožujejo 100% naravni kvasec TechnoYEAST, zaradi katerega ima odličen okus.
6. Kaj če vašemu psu ni všeč? Ni problema! V celoti vam bomo povrnili denar, zato ni absolutno nobenega tveganja.
Pasje srbenje, praskanje, lizanje tačk in prebavne težave pogosto izvirajo iz nezdravega črevesja, kjer škodljive bakterije prevladajo nad dobrimi. To sproži vnetje, ki vpliva na kožo in oslabi imunski sistem.
Belly Biotics ponujajo celovito rešitev s 3 dokazanimi koraki:
1 - Obnavlja zdravje črevesja
a) Prebiotiki hranijo dobre bakterije v črevesju, jim pomagajo uspevati in ustvariti uravnoteženo okolje.
b) Probiotiki dodajajo žive koristne bakterije za obnovitev zdravja črevesja.
c) Postbiotiki zagotavljajo že pripravljene koristne spojine (metabolite), ki izboljšajo delovanje črevesja in zmanjšajo vnetje.
2 - Popravlja oslabljen imunski sistem
Prebiotiki, probiotiki in postbiotiki skupaj, s podporo kurkume, krepijo imunski sistem. To pomaga imunskemu sistemu vašega psa v boju proti okužbam in pri naravnem zdravljenju poškodovane kože.
3 - Neposredno hrani kožo in dlako
Mešanica biotina, kurkume, cinka in alginega olja za neposredno podporo zdravju kože vašega psa, pomirjanje srbenja in podporo zdravi dlaki. Poleg tega vidni rezultati: manj izpadanja dlake, več sijaja in srečnejši, bolj zdrav pes.
Pasje srbenje, praskanje, lizanje tačk in prebavne težave pogosto izvirajo iz nezdravega črevesja, kjer škodljive bakterije prevladajo nad dobrimi. To sproži vnetje, ki vpliva na kožo in oslabi imunski sistem.
Belly Biotics ponujajo celovito rešitev s 3 dokazanimi koraki:
1 - Obnavlja zdravje črevesja
a) Prebiotiki hranijo dobre bakterije v črevesju, jim pomagajo uspevati in ustvariti uravnoteženo okolje.
b) Probiotiki dodajajo žive koristne bakterije za obnovitev zdravja črevesja.
c) Postbiotiki zagotavljajo že pripravljene koristne spojine (metabolite), ki izboljšajo delovanje črevesja in zmanjšajo vnetje.
2 - Popravlja oslabljen imunski sistem
Prebiotiki, probiotiki in postbiotiki skupaj, s podporo kurkume, krepijo imunski sistem. To pomaga imunskemu sistemu vašega psa v boju proti okužbam in pri naravnem zdravljenju poškodovane kože.
3 - Neposredno hrani kožo in dlako
Mešanica biotina, kurkume, cinka in alginega olja za neposredno podporo zdravju kože vašega psa, pomirjanje srbenja in podporo zdravi dlaki. Poleg tega vidni rezultati: manj izpadanja dlake, več sijaja in srečnejši, bolj zdrav pes.
Pasje srbenje, praskanje, lizanje tačk in prebavne težave pogosto izvirajo iz nezdravega črevesja, kjer škodljive bakterije prevladajo nad dobrimi. To sproži vnetje, ki vpliva na kožo in oslabi imunski sistem.
Belly Biotics ponujajo celovito rešitev s 3 dokazanimi koraki:
1 - Obnavlja zdravje črevesja
a) Prebiotiki hranijo dobre bakterije v črevesju, jim pomagajo uspevati in ustvariti uravnoteženo okolje.
b) Probiotiki dodajajo žive koristne bakterije za obnovitev zdravja črevesja.
c) Postbiotiki zagotavljajo že pripravljene koristne spojine (metabolite), ki izboljšajo delovanje črevesja in zmanjšajo vnetje.
2 - Popravlja oslabljen imunski sistem
Prebiotiki, probiotiki in postbiotiki skupaj, s podporo kurkume, krepijo imunski sistem. To pomaga imunskemu sistemu vašega psa v boju proti okužbam in pri naravnem zdravljenju poškodovane kože.
3 - Neposredno hrani kožo in dlako
Mešanica biotina, kurkume, cinka in alginega olja za neposredno podporo zdravju kože vašega psa, pomirjanje srbenja in podporo zdravi dlaki. Poleg tega vidni rezultati: manj izpadanja dlake, več sijaja in srečnejši, bolj zdrav pes.
| mg na mero za 10kg psa | |
| Sestavine | |
| Sušene kvasovke TECHNO YEAST | 1058 |
| TECHNO MOS | 250 |
| Kolostrum v prahu B.I.O.lg 20% | 250 |
| BIOSPRINT probiotik (9 milijard CFU) | 560 |
| Bacillus velezensis DSM 15544 (Calsporin) | 33,3 |
| Enterococcus faecium DSM 10663 (Oralin) | 28,6 |
| EpiCor Pets postbiotik | 70 |
| HA108 postbiotik | 1 |
| FOS ekstrakt cikorije | 200 |
| Vitamin B1 | 2 |
| Vitamin B2 | 1 |
| Vitamin B5 | 1 |
| Vitamin B6 | 1 |
| Vitamin B12 | 0,01 |
| Vitamin C | 1,5 |
| Biotin | 4 |
| Folna kislina | 0,2 |
| Vitamin E (50% Vit E) | 18 |
| Borovničevi polifenoli | 35 |
| DHA Gold (DHA iz alg) | 120 |
| Cink (kelatni) | 12 |
| mg na mero za 10kg psa | |
| Sestavine | |
| Sušene kvasovke TECHNO YEAST | 1058 |
| TECHNO MOS | 250 |
| Kolostrum v prahu B.I.O.lg 20% | 250 |
| BIOSPRINT probiotik (9 milijard CFU) | 560 |
| Bacillus velezensis DSM 15544 (Calsporin) | 33,3 |
| Enterococcus faecium DSM 10663 (Oralin) | 28,6 |
| EpiCor Pets postbiotik | 70 |
| HA108 postbiotik | 1 |
| FOS ekstrakt cikorije | 200 |
| Vitamin B1 | 2 |
| Vitamin B2 | 1 |
| Vitamin B5 | 1 |
| Vitamin B6 | 1 |
| Vitamin B12 | 0,01 |
| Vitamin C | 1,5 |
| Biotin | 4 |
| Folna kislina | 0,2 |
| Vitamin E (50% Vit E) | 18 |
| Borovničevi polifenoli | 35 |
| DHA Gold (DHA iz alg) | 120 |
| Cink (kelatni) | 12 |
| mg na mero za 10kg psa | |
| Sestavine | |
| Sušene kvasovke TECHNO YEAST | 1058 |
| TECHNO MOS | 250 |
| Kolostrum v prahu B.I.O.lg 20% | 250 |
| BIOSPRINT probiotik (9 milijard CFU) | 560 |
| Bacillus velezensis DSM 15544 (Calsporin) | 33,3 |
| Enterococcus faecium DSM 10663 (Oralin) | 28,6 |
| EpiCor Pets postbiotik | 70 |
| HA108 postbiotik | 1 |
| FOS ekstrakt cikorije | 200 |
| Vitamin B1 | 2 |
| Vitamin B2 | 1 |
| Vitamin B5 | 1 |
| Vitamin B6 | 1 |
| Vitamin B12 | 0,01 |
| Vitamin C | 1,5 |
| Biotin | 4 |
| Folna kislina | 0,2 |
| Vitamin E (50% Vit E) | 18 |
| Borovničevi polifenoli | 35 |
| DHA Gold (DHA iz alg) | 120 |
| Cink (kelatni) | 12 |
Bestellen Sie das Produkt und testen Sie es.
Wenn Ihr Hund es nicht mag, schreiben Sie einfach an support@pawital.com, um eine Rückerstattung zu beantragen.
1. Wenn Sie nur eine einzelne Packung bestellt haben, können Sie diese kostenlos behalten.
2. Wenn Sie mehrere Packungen bestellt haben, bitten wir Sie lediglich, die ungeöffneten Packungen an uns zurückzusenden.
Wenn Sie nach 2 Monaten keine Ergebnisse sehen, schreiben Sie uns einfach und wir erstatten Ihnen den vollen Betrag zurück.
Bestellen Sie das Produkt und testen Sie es.
Wenn Ihr Hund es nicht mag, schreiben Sie einfach an support@pawital.com, um eine Rückerstattung zu beantragen.
1. Wenn Sie nur eine einzelne Packung bestellt haben, können Sie diese kostenlos behalten.
2. Wenn Sie mehrere Packungen bestellt haben, bitten wir Sie lediglich, die ungeöffneten Packungen an uns zurückzusenden.
Wenn Sie nach 2 Monaten keine Ergebnisse sehen, schreiben Sie uns einfach und wir erstatten Ihnen den vollen Betrag zurück.
Bestellen Sie das Produkt und testen Sie es.
Wenn Ihr Hund es nicht mag, schreiben Sie einfach an support@pawital.com, um eine Rückerstattung zu beantragen.
1. Wenn Sie nur eine einzelne Packung bestellt haben, können Sie diese kostenlos behalten.
2. Wenn Sie mehrere Packungen bestellt haben, bitten wir Sie lediglich, die ungeöffneten Packungen an uns zurückzusenden.
Wenn Sie nach 2 Monaten keine Ergebnisse sehen, schreiben Sie uns einfach und wir erstatten Ihnen den vollen Betrag zurück.
Sestava
Govedina (60%), sladki krompir, rastlinski glicerol, krompir, omega 3, pivski kvas, morska alga ascophyllum nodosum, hialuronska kislina, buča, jabolčni kis, laneno olje
Senzorični dodatki
Kurkuma
Zootehnični dodatki
Inaktivirane celice iz Bifidobacterium longum (ES1®) 1,25 x 10¹⁰ CFU/kg
Prehranski dodatki
Vitamin C, Vitamin E, Biotin
Analitske sestavine
Surove beljakovine 16,6%, surove maščobe 18,33%, surovi pepel 4,21%, surova vlakna 2,9%, vlaga 22,42%
Sestava
Govedina (60%), sladki krompir, rastlinski glicerol, krompir, omega 3, pivski kvas, morska alga ascophyllum nodosum, hialuronska kislina, buča, jabolčni kis, laneno olje
Senzorični dodatki
Kurkuma
Zootehnični dodatki
Inaktivirane celice iz Bifidobacterium longum (ES1®) 1,25 x 10¹⁰ CFU/kg
Prehranski dodatki
Vitamin C, Vitamin E, Biotin
Analitske sestavine
Surove beljakovine 16,6%, surove maščobe 18,33%, surovi pepel 4,21%, surova vlakna 2,9%, vlaga 22,42%
Sestava
Govedina (60%), sladki krompir, rastlinski glicerol, krompir, omega 3, pivski kvas, morska alga ascophyllum nodosum, hialuronska kislina, buča, jabolčni kis, laneno olje
Senzorični dodatki
Kurkuma
Zootehnični dodatki
Inaktivirane celice iz Bifidobacterium longum (ES1®) 1,25 x 10¹⁰ CFU/kg
Prehranski dodatki
Vitamin C, Vitamin E, Biotin
Analitske sestavine
Surove beljakovine 16,6%, surove maščobe 18,33%, surovi pepel 4,21%, surova vlakna 2,9%, vlaga 22,42%
Kako lahko zahtevam vračilo denarja? Če želite zahtevati vračilo denarja, preprosto pošljite elektronsko sporočilo na support@pawital.com in navedite razlog za vašo zahtevo. Vaše vračilo bomo obdelali v 3 delovnih dneh.
Pri Pawitalu stojimo za kakovostjo naših izdelkov in želimo, da sta vi in vaš kosmatinec popolnoma zadovoljna z nakupom. Razumemo, da je vsak pes edinstven in kar deluje za enega, morda ne bo delovalo za drugega. Zato ponujamo enostavno politiko vračila brez zapletov.
Za zahtevo vračila denarja sledite tem preprostim korakom:
1. Razlog za vračilo: Pošljite nam elektronsko sporočilo na support@pawital.com v 30 dneh od nakupa in navedite, zakaj niste zadovoljni. Razlogi so lahko:
a) Ni opaznega izboljšanja zdravja ali vedenja vašega psa.
b) Vašemu psu okus izdelka ni všeč.
c) Katerikoli drug razlog za nezadovoljstvo.
2. Vračilo izdelkov: Odprte in neporabljene izdelke vrnete na naš naslov v Sloveniji.
Vračila denarja se obdelajo v 3 delovnih dneh od datuma vaše zahteve, kar zagotavlja, da prejmete svoj denar nazaj brez zamude.
Kako lahko zahtevam vračilo denarja? Če želite zahtevati vračilo denarja, preprosto pošljite elektronsko sporočilo na support@pawital.com in navedite razlog za vašo zahtevo. Vaše vračilo bomo obdelali v 3 delovnih dneh.
Pri Pawitalu stojimo za kakovostjo naših izdelkov in želimo, da sta vi in vaš kosmatinec popolnoma zadovoljna z nakupom. Razumemo, da je vsak pes edinstven in kar deluje za enega, morda ne bo delovalo za drugega. Zato ponujamo enostavno politiko vračila brez zapletov.
Za zahtevo vračila denarja sledite tem preprostim korakom:
1. Razlog za vračilo: Pošljite nam elektronsko sporočilo na support@pawital.com v 30 dneh od nakupa in navedite, zakaj niste zadovoljni. Razlogi so lahko:
a) Ni opaznega izboljšanja zdravja ali vedenja vašega psa.
b) Vašemu psu okus izdelka ni všeč.
c) Katerikoli drug razlog za nezadovoljstvo.
2. Vračilo izdelkov: Odprte in neporabljene izdelke vrnete na naš naslov v Sloveniji.
Vračila denarja se obdelajo v 3 delovnih dneh od datuma vaše zahteve, kar zagotavlja, da prejmete svoj denar nazaj brez zamude.
Kako lahko zahtevam vračilo denarja? Če želite zahtevati vračilo denarja, preprosto pošljite elektronsko sporočilo na support@pawital.com in navedite razlog za vašo zahtevo. Vaše vračilo bomo obdelali v 3 delovnih dneh.
Pri Pawitalu stojimo za kakovostjo naših izdelkov in želimo, da sta vi in vaš kosmatinec popolnoma zadovoljna z nakupom. Razumemo, da je vsak pes edinstven in kar deluje za enega, morda ne bo delovalo za drugega. Zato ponujamo enostavno politiko vračila brez zapletov.
Za zahtevo vračila denarja sledite tem preprostim korakom:
1. Razlog za vračilo: Pošljite nam elektronsko sporočilo na support@pawital.com v 30 dneh od nakupa in navedite, zakaj niste zadovoljni. Razlogi so lahko:
a) Ni opaznega izboljšanja zdravja ali vedenja vašega psa.
b) Vašemu psu okus izdelka ni všeč.
c) Katerikoli drug razlog za nezadovoljstvo.
2. Vračilo izdelkov: Odprte in neporabljene izdelke vrnete na naš naslov v Sloveniji.
Vračila denarja se obdelajo v 3 delovnih dneh od datuma vaše zahteve, kar zagotavlja, da prejmete svoj denar nazaj brez zamude.
Das Kratzen, Pfotenlecken und die Verdauungsprobleme Ihres Hundes beginnen oft mit einem ungesunden Darm, wo schädliche Bakterien die guten überwiegen. Dies löst Entzündungen aus, die die Haut beeinflussen und das Immunsystem schwächen.
Belly Biotics bietet eine vollständige Lösung in 3 bewährten Schritten:
1 - Stellt die Darmgesundheit wieder her
2 - Repariert das geschwächte Immunsystem
Präbiotika, Probiotika und Postbiotika wirken zusammen mit Kurkuma und stärken das Immunsystem. So unterstützen sie die natürliche Abwehrkraft Ihres Hundes gegen Infektionen und fördern die Heilung geschädigter Haut.
3 - Nährt Haut & Fell direkt
Kombination aus Biotin, Kurkuma, Zink und Algenöl zur direkten Unterstützung der Hautgesundheit, Linderung von Juckreiz und für ein gesundes Fell.
Das Kratzen, Pfotenlecken und die Verdauungsprobleme Ihres Hundes beginnen oft mit einem ungesunden Darm, wo schädliche Bakterien die guten überwiegen. Dies löst Entzündungen aus, die die Haut beeinflussen und das Immunsystem schwächen.
Belly Biotics bietet eine vollständige Lösung in 3 bewährten Schritten:
1 - Stellt die Darmgesundheit wieder her
2 - Repariert das geschwächte Immunsystem
Präbiotika, Probiotika und Postbiotika wirken zusammen mit Kurkuma und stärken das Immunsystem. So unterstützen sie die natürliche Abwehrkraft Ihres Hundes gegen Infektionen und fördern die Heilung geschädigter Haut.
3 - Nährt Haut & Fell direkt
Kombination aus Biotin, Kurkuma, Zink und Algenöl zur direkten Unterstützung der Hautgesundheit, Linderung von Juckreiz und für ein gesundes Fell.
Das Kratzen, Pfotenlecken und die Verdauungsprobleme Ihres Hundes beginnen oft mit einem ungesunden Darm, wo schädliche Bakterien die guten überwiegen. Dies löst Entzündungen aus, die die Haut beeinflussen und das Immunsystem schwächen.
Belly Biotics bietet eine vollständige Lösung in 3 bewährten Schritten:
1 - Stellt die Darmgesundheit wieder her
2 - Repariert das geschwächte Immunsystem
Präbiotika, Probiotika und Postbiotika wirken zusammen mit Kurkuma und stärken das Immunsystem. So unterstützen sie die natürliche Abwehrkraft Ihres Hundes gegen Infektionen und fördern die Heilung geschädigter Haut.
3 - Nährt Haut & Fell direkt
Kombination aus Biotin, Kurkuma, Zink und Algenöl zur direkten Unterstützung der Hautgesundheit, Linderung von Juckreiz und für ein gesundes Fell.
Il grattamento, il leccamento delle zampe e i problemi digestivi del tuo cane spesso iniziano con un intestino non sano, dove i batteri nocivi sopraffanno quelli buoni. Questo innesca un'infiammazione che colpisce la pelle e indebolisce il sistema immunitario.
Belly Biotics fornisce una soluzione completa attraverso 3 fasi provate:
1 - Ripristina la salute intestinale
2 - Ripara il sistema immunitario indebolito
I prebiotici, i probiotici e i postbiotici, insieme alla curcuma, rafforzano il sistema immunitario. Questo aiuta le difese naturali del tuo cane a combattere le infezioni e guarire naturalmente la pelle danneggiata.
3 - Nutre direttamente pelle e pelo
Miscela di biotina, curcuma, zinco e olio di alghe per supportare direttamente la salute della pelle, alleviare il prurito e favorire un pelo sano.
Il grattamento, il leccamento delle zampe e i problemi digestivi del tuo cane spesso iniziano con un intestino non sano, dove i batteri nocivi sopraffanno quelli buoni. Questo innesca un'infiammazione che colpisce la pelle e indebolisce il sistema immunitario.
Belly Biotics fornisce una soluzione completa attraverso 3 fasi provate:
1 - Ripristina la salute intestinale
2 - Ripara il sistema immunitario indebolito
I prebiotici, i probiotici e i postbiotici, insieme alla curcuma, rafforzano il sistema immunitario. Questo aiuta le difese naturali del tuo cane a combattere le infezioni e guarire naturalmente la pelle danneggiata.
3 - Nutre direttamente pelle e pelo
Miscela di biotina, curcuma, zinco e olio di alghe per supportare direttamente la salute della pelle, alleviare il prurito e favorire un pelo sano.
Il grattamento, il leccamento delle zampe e i problemi digestivi del tuo cane spesso iniziano con un intestino non sano, dove i batteri nocivi sopraffanno quelli buoni. Questo innesca un'infiammazione che colpisce la pelle e indebolisce il sistema immunitario.
Belly Biotics fornisce una soluzione completa attraverso 3 fasi provate:
1 - Ripristina la salute intestinale
2 - Ripara il sistema immunitario indebolito
I prebiotici, i probiotici e i postbiotici, insieme alla curcuma, rafforzano il sistema immunitario. Questo aiuta le difese naturali del tuo cane a combattere le infezioni e guarire naturalmente la pelle danneggiata.
3 - Nutre direttamente pelle e pelo
Miscela di biotina, curcuma, zinco e olio di alghe per supportare direttamente la salute della pelle, alleviare il prurito e favorire un pelo sano.
Your dog's itching, scratching, paw licking, and digestive issues often start with an unhealthy gut, where harmful bacteria overwhelm the good ones. This triggers inflammation affecting the skin and weakens the immune system.
Belly Biotics provides a complete solution through 3 proven steps:
1 - Restores Gut Health
2 - Repairs Weakened Immune System
Prebiotics, probiotics and postbiotics together, with the support of curcuma, strengthen the immune system. This helps your dog's immune system to fight infections and heal damanged skin naturally.
3 - Directly Nourishes the Skin & Coat
Blend of biotin, curcuma, zinc and algae oil to directly support your dog’s skin health, soothe itching and healthy coat support. Plus these visible results: less shedding, more shine, and a happier, healthier dog.
Your dog's itching, scratching, paw licking, and digestive issues often start with an unhealthy gut, where harmful bacteria overwhelm the good ones. This triggers inflammation affecting the skin and weakens the immune system.
Belly Biotics provides a complete solution through 3 proven steps:
1 - Restores Gut Health
2 - Repairs Weakened Immune System
Prebiotics, probiotics and postbiotics together, with the support of curcuma, strengthen the immune system. This helps your dog's immune system to fight infections and heal damanged skin naturally.
3 - Directly Nourishes the Skin & Coat
Blend of biotin, curcuma, zinc and algae oil to directly support your dog’s skin health, soothe itching and healthy coat support. Plus these visible results: less shedding, more shine, and a happier, healthier dog.
Your dog's itching, scratching, paw licking, and digestive issues often start with an unhealthy gut, where harmful bacteria overwhelm the good ones. This triggers inflammation affecting the skin and weakens the immune system.
Belly Biotics provides a complete solution through 3 proven steps:
1 - Restores Gut Health
2 - Repairs Weakened Immune System
Prebiotics, probiotics and postbiotics together, with the support of curcuma, strengthen the immune system. This helps your dog's immune system to fight infections and heal damanged skin naturally.
3 - Directly Nourishes the Skin & Coat
Blend of biotin, curcuma, zinc and algae oil to directly support your dog’s skin health, soothe itching and healthy coat support. Plus these visible results: less shedding, more shine, and a happier, healthier dog.
Zusammensetzung
Dehydrierte Hühnerproteine (30 %), Erbsenstärke, gemahlene Erbsen, Schweinefett, Geflügelfett, gemahlene Leinsamen (2 %), getrocknete Bierhefe (2 %), getrockneter Chicorée (2 %) (Quelle für FOS und Inulin), hydrolysierte Hühnerproteine (Leber), Algenöl (1 %) (Quelle für EPA und DHA), Curcuma (1 %), Lignocellulose, Hefezellwand (0,5 %) (Quelle für MOS und Beta-Glucane), Flohsamenschalen, Mineralien, Lactobacillus Helveticus HA-122 inaktiviert (1000 mg/kg).
Analytische Bestandteile
Rohprotein 30 %, Fettgehalt 20 %, Rohfaser 2,8 %, anorganische Stoffe 6,5 %
ZUSATZSTOFFE (pro kg)
Vitamine: Biotin 80 mg
Spurenelemente: Zn (Zinkchelat von Proteinhydrolysaten) 100 mg
Antioxidantien: Tocopherol-Extrakte aus Pflanzenölen (1b306 (i))
Darmflorastabilisatoren: Bacillus velezensis DSM 15544 (4b1820) 3,63x10^11 KBE
Ergänzungsfuttermittel für erwachsene Hunde. Hunde sollten während der Fütterung jederzeit beaufsichtigt werden. Nicht füttern, wenn Ihr Haustier eine bekannte Hühnerallergie hat. Stellen Sie sicher, dass Ihr Haustier jederzeit frisches Trinkwasser zur Verfügung hat. Das Produkt an einem kühlen, trockenen Ort aufbewahren. Nach dem Öffnen wieder verschließen, um die Frische zu erhalten. Mindesthaltbarkeitsdatum und Chargennummer sind auf der Verpackung angegeben.
Zusammensetzung
Dehydrierte Hühnerproteine (30 %), Erbsenstärke, gemahlene Erbsen, Schweinefett, Geflügelfett, gemahlene Leinsamen (2 %), getrocknete Bierhefe (2 %), getrockneter Chicorée (2 %) (Quelle für FOS und Inulin), hydrolysierte Hühnerproteine (Leber), Algenöl (1 %) (Quelle für EPA und DHA), Curcuma (1 %), Lignocellulose, Hefezellwand (0,5 %) (Quelle für MOS und Beta-Glucane), Flohsamenschalen, Mineralien, Lactobacillus Helveticus HA-122 inaktiviert (1000 mg/kg).
Analytische Bestandteile
Rohprotein 30 %, Fettgehalt 20 %, Rohfaser 2,8 %, anorganische Stoffe 6,5 %
ZUSATZSTOFFE (pro kg)
Vitamine: Biotin 80 mg
Spurenelemente: Zn (Zinkchelat von Proteinhydrolysaten) 100 mg
Antioxidantien: Tocopherol-Extrakte aus Pflanzenölen (1b306 (i))
Darmflorastabilisatoren: Bacillus velezensis DSM 15544 (4b1820) 3,63x10^11 KBE
Ergänzungsfuttermittel für erwachsene Hunde. Hunde sollten während der Fütterung jederzeit beaufsichtigt werden. Nicht füttern, wenn Ihr Haustier eine bekannte Hühnerallergie hat. Stellen Sie sicher, dass Ihr Haustier jederzeit frisches Trinkwasser zur Verfügung hat. Das Produkt an einem kühlen, trockenen Ort aufbewahren. Nach dem Öffnen wieder verschließen, um die Frische zu erhalten. Mindesthaltbarkeitsdatum und Chargennummer sind auf der Verpackung angegeben.
Zusammensetzung
Dehydrierte Hühnerproteine (30 %), Erbsenstärke, gemahlene Erbsen, Schweinefett, Geflügelfett, gemahlene Leinsamen (2 %), getrocknete Bierhefe (2 %), getrockneter Chicorée (2 %) (Quelle für FOS und Inulin), hydrolysierte Hühnerproteine (Leber), Algenöl (1 %) (Quelle für EPA und DHA), Curcuma (1 %), Lignocellulose, Hefezellwand (0,5 %) (Quelle für MOS und Beta-Glucane), Flohsamenschalen, Mineralien, Lactobacillus Helveticus HA-122 inaktiviert (1000 mg/kg).
Analytische Bestandteile
Rohprotein 30 %, Fettgehalt 20 %, Rohfaser 2,8 %, anorganische Stoffe 6,5 %
ZUSATZSTOFFE (pro kg)
Vitamine: Biotin 80 mg
Spurenelemente: Zn (Zinkchelat von Proteinhydrolysaten) 100 mg
Antioxidantien: Tocopherol-Extrakte aus Pflanzenölen (1b306 (i))
Darmflorastabilisatoren: Bacillus velezensis DSM 15544 (4b1820) 3,63x10^11 KBE
Ergänzungsfuttermittel für erwachsene Hunde. Hunde sollten während der Fütterung jederzeit beaufsichtigt werden. Nicht füttern, wenn Ihr Haustier eine bekannte Hühnerallergie hat. Stellen Sie sicher, dass Ihr Haustier jederzeit frisches Trinkwasser zur Verfügung hat. Das Produkt an einem kühlen, trockenen Ort aufbewahren. Nach dem Öffnen wieder verschließen, um die Frische zu erhalten. Mindesthaltbarkeitsdatum und Chargennummer sind auf der Verpackung angegeben.
Ingredienti
Proteine di pollo disidratate (30%), amido di piselli, piselli macinati, grasso di maiale, grasso di volatili, semi di lino macinati (2%), lievito di birra essiccato (2%), cicoria essiccata (2%) (fonte di frutto-oligosaccaridi e inulina), proteine di pollo idrolizzate (fegato), olio di alghe (1%) (fonte di EPA e DHA), curcuma (1%), lignocellulosa, scorze di lieviti (0,5%) (fonte di mannano-oligosaccaridi e beta-glucani), buccia di psillio, minerali, Lactobacillus Helveticus HA-122 inattivato (1000 mg/kg).
Componenti analitici
Proteina grezza 30%, tenore di grasso 20%, fibra grezza 2,8%, materia inorganica 6,5%
ADDITIVI (per kg)
Vitamine: biotina 80 mg
Oligoelementi: Zn (chelato di zinco di idrolizzati di proteine) 100 mg
Antiossidanti: estratti di tocoferolo da oli vegetali (1b306(i))
Stabilizzatori della flora intestinale: Bacillus velezensis DSM 15544 (4b1820) 3,63x10^11 UFC
Alimento complementare per cani adulti. Supervisionare sempre i cani durante l’alimentazione. Non somministrare se il proprio animale domestico ha un’allergia nota al pollo. Assicurarsi che il proprio animale domestico abbia sempre a disposizione acqua potabile fresca. Conservare in luogo fresco e asciutto. Dopo l’apertura, richiudere per preservare la freschezza. Da consumarsi preferibilmente entro il e numero di lotto stampati sulla confezione.
Ingredienti
Proteine di pollo disidratate (30%), amido di piselli, piselli macinati, grasso di maiale, grasso di volatili, semi di lino macinati (2%), lievito di birra essiccato (2%), cicoria essiccata (2%) (fonte di frutto-oligosaccaridi e inulina), proteine di pollo idrolizzate (fegato), olio di alghe (1%) (fonte di EPA e DHA), curcuma (1%), lignocellulosa, scorze di lieviti (0,5%) (fonte di mannano-oligosaccaridi e beta-glucani), buccia di psillio, minerali, Lactobacillus Helveticus HA-122 inattivato (1000 mg/kg).
Componenti analitici
Proteina grezza 30%, tenore di grasso 20%, fibra grezza 2,8%, materia inorganica 6,5%
ADDITIVI (per kg)
Vitamine: biotina 80 mg
Oligoelementi: Zn (chelato di zinco di idrolizzati di proteine) 100 mg
Antiossidanti: estratti di tocoferolo da oli vegetali (1b306(i))
Stabilizzatori della flora intestinale: Bacillus velezensis DSM 15544 (4b1820) 3,63x10^11 UFC
Alimento complementare per cani adulti. Supervisionare sempre i cani durante l’alimentazione. Non somministrare se il proprio animale domestico ha un’allergia nota al pollo. Assicurarsi che il proprio animale domestico abbia sempre a disposizione acqua potabile fresca. Conservare in luogo fresco e asciutto. Dopo l’apertura, richiudere per preservare la freschezza. Da consumarsi preferibilmente entro il e numero di lotto stampati sulla confezione.
Ingredienti
Proteine di pollo disidratate (30%), amido di piselli, piselli macinati, grasso di maiale, grasso di volatili, semi di lino macinati (2%), lievito di birra essiccato (2%), cicoria essiccata (2%) (fonte di frutto-oligosaccaridi e inulina), proteine di pollo idrolizzate (fegato), olio di alghe (1%) (fonte di EPA e DHA), curcuma (1%), lignocellulosa, scorze di lieviti (0,5%) (fonte di mannano-oligosaccaridi e beta-glucani), buccia di psillio, minerali, Lactobacillus Helveticus HA-122 inattivato (1000 mg/kg).
Componenti analitici
Proteina grezza 30%, tenore di grasso 20%, fibra grezza 2,8%, materia inorganica 6,5%
ADDITIVI (per kg)
Vitamine: biotina 80 mg
Oligoelementi: Zn (chelato di zinco di idrolizzati di proteine) 100 mg
Antiossidanti: estratti di tocoferolo da oli vegetali (1b306(i))
Stabilizzatori della flora intestinale: Bacillus velezensis DSM 15544 (4b1820) 3,63x10^11 UFC
Alimento complementare per cani adulti. Supervisionare sempre i cani durante l’alimentazione. Non somministrare se il proprio animale domestico ha un’allergia nota al pollo. Assicurarsi che il proprio animale domestico abbia sempre a disposizione acqua potabile fresca. Conservare in luogo fresco e asciutto. Dopo l’apertura, richiudere per preservare la freschezza. Da consumarsi preferibilmente entro il e numero di lotto stampati sulla confezione.
Composition
Dehydrated chicken proteins (30%), pea starch, ground peas, pork fat, poultry fat, ground linseed (2%), dried brewers’ yeast (2%), dried chicory (2%) (source of FOS and inulin), hydrolyzed chicken proteins (liver), algae oil (1%) (source of EPA and DHA), Curcuma (1%), lignocellulose, yeast cell wall (0.5%) (source of MOS and beta-glucans), psyllium husk, minerals, Lactobacillus Helveticus HA-122 inactivated (1000 mg/kg).
Analytical constituents
Crude protein 30%, Fat content 20%, Crude fibre 2.8%, Inorganic matter 6.5%
ADDITIVES (per kg)
Vitamins: Biotin 80 mg
Trace elements: Zn (Zinc chelate of protein hydrolysates) 100 mg
Antioxidants: Tocopherol extracts from vegetable oils (1b306(i))
Gut flora stabilisers: Bacillus velezensis DSM 15544 (4b1820) 3,63x10^11 CFU
Complementary pet food for adult dogs. Dogs should be supervised at all times while feeding. Do not give if your pet has a known allergy to chicken. Ensure that your pet has available fresh drinking water at all times. Store in a cool, dry place. Once opened, reseal to maintain freshness. Best before date and batch number are printed on the packaging.
Composition
Dehydrated chicken proteins (30%), pea starch, ground peas, pork fat, poultry fat, ground linseed (2%), dried brewers’ yeast (2%), dried chicory (2%) (source of FOS and inulin), hydrolyzed chicken proteins (liver), algae oil (1%) (source of EPA and DHA), Curcuma (1%), lignocellulose, yeast cell wall (0.5%) (source of MOS and beta-glucans), psyllium husk, minerals, Lactobacillus Helveticus HA-122 inactivated (1000 mg/kg).
Analytical constituents
Crude protein 30%, Fat content 20%, Crude fibre 2.8%, Inorganic matter 6.5%
ADDITIVES (per kg)
Vitamins: Biotin 80 mg
Trace elements: Zn (Zinc chelate of protein hydrolysates) 100 mg
Antioxidants: Tocopherol extracts from vegetable oils (1b306(i))
Gut flora stabilisers: Bacillus velezensis DSM 15544 (4b1820) 3,63x10^11 CFU
Complementary pet food for adult dogs. Dogs should be supervised at all times while feeding. Do not give if your pet has a known allergy to chicken. Ensure that your pet has available fresh drinking water at all times. Store in a cool, dry place. Once opened, reseal to maintain freshness. Best before date and batch number are printed on the packaging.
Composition
Dehydrated chicken proteins (30%), pea starch, ground peas, pork fat, poultry fat, ground linseed (2%), dried brewers’ yeast (2%), dried chicory (2%) (source of FOS and inulin), hydrolyzed chicken proteins (liver), algae oil (1%) (source of EPA and DHA), Curcuma (1%), lignocellulose, yeast cell wall (0.5%) (source of MOS and beta-glucans), psyllium husk, minerals, Lactobacillus Helveticus HA-122 inactivated (1000 mg/kg).
Analytical constituents
Crude protein 30%, Fat content 20%, Crude fibre 2.8%, Inorganic matter 6.5%
ADDITIVES (per kg)
Vitamins: Biotin 80 mg
Trace elements: Zn (Zinc chelate of protein hydrolysates) 100 mg
Antioxidants: Tocopherol extracts from vegetable oils (1b306(i))
Gut flora stabilisers: Bacillus velezensis DSM 15544 (4b1820) 3,63x10^11 CFU
Complementary pet food for adult dogs. Dogs should be supervised at all times while feeding. Do not give if your pet has a known allergy to chicken. Ensure that your pet has available fresh drinking water at all times. Store in a cool, dry place. Once opened, reseal to maintain freshness. Best before date and batch number are printed on the packaging.
gutQR enthält eine Mischung aus 3 essentiellen Präbiotika zur Unterstützung der Darm- und Immungesundheit Ihres Hundes.
TechnoYEAST
TechnoYEAST wird aus dem einzigartigen Hefestamm Kluyveromyces fragilis hergestellt und liefert funktionelle und essentielle Aminosäuren, wertvolle Nukleotide und nützliche Zellwände (MOS und Beta-Glukane).
Dank seines einzigartigen Umami-Geschmacks lieben Hunde es.
TechnoMOS
TechnoMOS ist ein leistungsstarkes, multifunktionales Präbiotikum aus Saccharomyces cerevisiae Hefe, entwickelt zur Förderung der Darm- und Immungesundheit Ihres Hundes.
FOS Chicoréewurzelextrakt
FOS (Fructooligosaccharide) Chicoréewurzelextrakt ist ein präbiotischer Ballaststoff, der die Verdauungsgesundheit unterstützt, indem er nützliche Darmbakterien ernährt, die Verdauung verbessert und das Gleichgewicht im Darm fördert.
gutQR enthält eine Mischung aus 3 essentiellen Präbiotika zur Unterstützung der Darm- und Immungesundheit Ihres Hundes.
TechnoYEAST
TechnoYEAST wird aus dem einzigartigen Hefestamm Kluyveromyces fragilis hergestellt und liefert funktionelle und essentielle Aminosäuren, wertvolle Nukleotide und nützliche Zellwände (MOS und Beta-Glukane).
Dank seines einzigartigen Umami-Geschmacks lieben Hunde es.
TechnoMOS
TechnoMOS ist ein leistungsstarkes, multifunktionales Präbiotikum aus Saccharomyces cerevisiae Hefe, entwickelt zur Förderung der Darm- und Immungesundheit Ihres Hundes.
FOS Chicoréewurzelextrakt
FOS (Fructooligosaccharide) Chicoréewurzelextrakt ist ein präbiotischer Ballaststoff, der die Verdauungsgesundheit unterstützt, indem er nützliche Darmbakterien ernährt, die Verdauung verbessert und das Gleichgewicht im Darm fördert.
gutQR enthält eine Mischung aus 3 essentiellen Präbiotika zur Unterstützung der Darm- und Immungesundheit Ihres Hundes.
TechnoYEAST
TechnoYEAST wird aus dem einzigartigen Hefestamm Kluyveromyces fragilis hergestellt und liefert funktionelle und essentielle Aminosäuren, wertvolle Nukleotide und nützliche Zellwände (MOS und Beta-Glukane).
Dank seines einzigartigen Umami-Geschmacks lieben Hunde es.
TechnoMOS
TechnoMOS ist ein leistungsstarkes, multifunktionales Präbiotikum aus Saccharomyces cerevisiae Hefe, entwickelt zur Förderung der Darm- und Immungesundheit Ihres Hundes.
FOS Chicoréewurzelextrakt
FOS (Fructooligosaccharide) Chicoréewurzelextrakt ist ein präbiotischer Ballaststoff, der die Verdauungsgesundheit unterstützt, indem er nützliche Darmbakterien ernährt, die Verdauung verbessert und das Gleichgewicht im Darm fördert.
gutQR contiene una miscela di 3 prebiotici essenziali per supportare la salute intestinale e immunitaria del tuo cane.
TechnoYEAST
TechnoYEAST è prodotto dal ceppo unico di lievito Kluyveromyces fragilis e fornisce aminoacidi funzionali ed essenziali, preziosi nucleotidi e benefiche pareti cellulari (MOS e beta-glucani).
Grazie al suo sapore umami unico, i cani lo adorano.
TechnoMOS
TechnoMOS è un prebiotico potente e multifunzionale derivato dal lievito Saccharomyces cerevisiae, progettato per potenziare la salute intestinale e immunitaria del tuo cane.
FOS Estratto di Radice di Cicoria
L'estratto di radice di cicoria FOS (Fruttooligosaccaridi) è una fibra prebiotica che supporta la salute digestiva nutrendo i batteri intestinali benefici, migliorando la digestione e promuovendo l'equilibrio intestinale generale.
gutQR contiene una miscela di 3 prebiotici essenziali per supportare la salute intestinale e immunitaria del tuo cane.
TechnoYEAST
TechnoYEAST è prodotto dal ceppo unico di lievito Kluyveromyces fragilis e fornisce aminoacidi funzionali ed essenziali, preziosi nucleotidi e benefiche pareti cellulari (MOS e beta-glucani).
Grazie al suo sapore umami unico, i cani lo adorano.
TechnoMOS
TechnoMOS è un prebiotico potente e multifunzionale derivato dal lievito Saccharomyces cerevisiae, progettato per potenziare la salute intestinale e immunitaria del tuo cane.
FOS Estratto di Radice di Cicoria
L'estratto di radice di cicoria FOS (Fruttooligosaccaridi) è una fibra prebiotica che supporta la salute digestiva nutrendo i batteri intestinali benefici, migliorando la digestione e promuovendo l'equilibrio intestinale generale.
gutQR contiene una miscela di 3 prebiotici essenziali per supportare la salute intestinale e immunitaria del tuo cane.
TechnoYEAST
TechnoYEAST è prodotto dal ceppo unico di lievito Kluyveromyces fragilis e fornisce aminoacidi funzionali ed essenziali, preziosi nucleotidi e benefiche pareti cellulari (MOS e beta-glucani).
Grazie al suo sapore umami unico, i cani lo adorano.
TechnoMOS
TechnoMOS è un prebiotico potente e multifunzionale derivato dal lievito Saccharomyces cerevisiae, progettato per potenziare la salute intestinale e immunitaria del tuo cane.
FOS Estratto di Radice di Cicoria
L'estratto di radice di cicoria FOS (Fruttooligosaccaridi) è una fibra prebiotica che supporta la salute digestiva nutrendo i batteri intestinali benefici, migliorando la digestione e promuovendo l'equilibrio intestinale generale.
gutQR contains a blend of 3 essential prebiotics to support your dog's gut and immune health.
TechnoYEAST
TechnoYEAST is made from the unique yeast strain Kluyveromyces fragilis and provides functional and essential amino acids, valuable nucleodites and beneficial cell walls (MOS and beta-glucans).
Due to its unique umami-like flavor, dogs love it.
TechnoMOS
TechnoMos is a powerful, multi-functional prebiotic derived from Saccharomyces cerevisiae yeast, designed to boost your dog's gut health and immune system.
FOS Chicory Root Extract
FOS (Fructooligosaccharides) Chicory Root Extract is a prebiotic fiber that supports digestive health by feeding beneficial gut bacteria, improving digestion, and promoting overall gut balance.
gutQR contains a blend of 3 essential prebiotics to support your dog's gut and immune health.
TechnoYEAST
TechnoYEAST is made from the unique yeast strain Kluyveromyces fragilis and provides functional and essential amino acids, valuable nucleodites and beneficial cell walls (MOS and beta-glucans).
Due to its unique umami-like flavor, dogs love it.
TechnoMOS
TechnoMos is a powerful, multi-functional prebiotic derived from Saccharomyces cerevisiae yeast, designed to boost your dog's gut health and immune system.
FOS Chicory Root Extract
FOS (Fructooligosaccharides) Chicory Root Extract is a prebiotic fiber that supports digestive health by feeding beneficial gut bacteria, improving digestion, and promoting overall gut balance.
gutQR contains a blend of 3 essential prebiotics to support your dog's gut and immune health.
TechnoYEAST
TechnoYEAST is made from the unique yeast strain Kluyveromyces fragilis and provides functional and essential amino acids, valuable nucleodites and beneficial cell walls (MOS and beta-glucans).
Due to its unique umami-like flavor, dogs love it.
TechnoMOS
TechnoMos is a powerful, multi-functional prebiotic derived from Saccharomyces cerevisiae yeast, designed to boost your dog's gut health and immune system.
FOS Chicory Root Extract
FOS (Fructooligosaccharides) Chicory Root Extract is a prebiotic fiber that supports digestive health by feeding beneficial gut bacteria, improving digestion, and promoting overall gut balance.
Wenn Ihr Hund sich übermäßig kratzt und seine Pfoten leckt, funktioniert sein Immunsystem nicht richtig.
Kolostrum B.I.O.Ig ist die natürliche Lösung dafür. Es ist die gleiche kraftvolle erste Milch, die Mutterkühe ihren Neugeborenen zum Schutz geben.
Wenn Ihr Hund sich übermäßig kratzt und seine Pfoten leckt, funktioniert sein Immunsystem nicht richtig.
Kolostrum B.I.O.Ig ist die natürliche Lösung dafür. Es ist die gleiche kraftvolle erste Milch, die Mutterkühe ihren Neugeborenen zum Schutz geben.
Wenn Ihr Hund sich übermäßig kratzt und seine Pfoten leckt, funktioniert sein Immunsystem nicht richtig.
Kolostrum B.I.O.Ig ist die natürliche Lösung dafür. Es ist die gleiche kraftvolle erste Milch, die Mutterkühe ihren Neugeborenen zum Schutz geben.
Quando il tuo cane si gratta eccessivamente e si lecca le zampe, il suo sistema immunitario non funziona correttamente.
Il Colostro B.I.O.Ig è il modo naturale per risolvere questo problema. È lo stesso potente primo latte che le mucche madri danno ai loro neonati per proteggerli.
Quando il tuo cane si gratta eccessivamente e si lecca le zampe, il suo sistema immunitario non funziona correttamente.
Il Colostro B.I.O.Ig è il modo naturale per risolvere questo problema. È lo stesso potente primo latte che le mucche madri danno ai loro neonati per proteggerli.
Quando il tuo cane si gratta eccessivamente e si lecca le zampe, il suo sistema immunitario non funziona correttamente.
Il Colostro B.I.O.Ig è il modo naturale per risolvere questo problema. È lo stesso potente primo latte che le mucche madri danno ai loro neonati per proteggerli.
When your dog scratches and licks their paws too much, their immune system isn't working right.
Colostrum B.I.O.Ig is nature's way to fix this. It's the same powerful first milk that mother cows give their newborns for protection.
When your dog scratches and licks their paws too much, their immune system isn't working right.
Colostrum B.I.O.Ig is nature's way to fix this. It's the same powerful first milk that mother cows give their newborns for protection.
When your dog scratches and licks their paws too much, their immune system isn't working right.
Colostrum B.I.O.Ig is nature's way to fix this. It's the same powerful first milk that mother cows give their newborns for protection.
Das Kratzen, Pfotenlecken und die Verdauungsprobleme Ihres Hundes beginnen oft mit einem ungesunden Darm, wo schädliche Bakterien die guten überwiegen. Dies löst Entzündungen aus, die die Haut beeinflussen und das Immunsystem schwächen.
gutQR bietet eine vollständige Lösung in 3 bewährten Schritten:
1 - Stellt die Darmgesundheit wieder her
2 - Repariert das geschwächte Immunsystem
Kolostrum B.I.O.Ig repariert das Immunsystem Ihres Hundes, um Infektionen zu bekämpfen und geschädigte Haut auf natürliche Weise zu heilen.
3 - Nährt Haut & Fell direkt
Biotin, Folsäure, Heidelbeer-Polyphenole, Omega-Fettsäuren und essentielle Vitamine nähren die Haut Ihres Hundes direkt und helfen bei der Reparatur. Plus diese sichtbaren Ergebnisse: weniger Haarausfall, mehr Glanz und ein glücklicherer, gesünderer Hund.
Das Kratzen, Pfotenlecken und die Verdauungsprobleme Ihres Hundes beginnen oft mit einem ungesunden Darm, wo schädliche Bakterien die guten überwiegen. Dies löst Entzündungen aus, die die Haut beeinflussen und das Immunsystem schwächen.
gutQR bietet eine vollständige Lösung in 3 bewährten Schritten:
1 - Stellt die Darmgesundheit wieder her
2 - Repariert das geschwächte Immunsystem
Kolostrum B.I.O.Ig repariert das Immunsystem Ihres Hundes, um Infektionen zu bekämpfen und geschädigte Haut auf natürliche Weise zu heilen.
3 - Nährt Haut & Fell direkt
Biotin, Folsäure, Heidelbeer-Polyphenole, Omega-Fettsäuren und essentielle Vitamine nähren die Haut Ihres Hundes direkt und helfen bei der Reparatur. Plus diese sichtbaren Ergebnisse: weniger Haarausfall, mehr Glanz und ein glücklicherer, gesünderer Hund.
Das Kratzen, Pfotenlecken und die Verdauungsprobleme Ihres Hundes beginnen oft mit einem ungesunden Darm, wo schädliche Bakterien die guten überwiegen. Dies löst Entzündungen aus, die die Haut beeinflussen und das Immunsystem schwächen.
gutQR bietet eine vollständige Lösung in 3 bewährten Schritten:
1 - Stellt die Darmgesundheit wieder her
2 - Repariert das geschwächte Immunsystem
Kolostrum B.I.O.Ig repariert das Immunsystem Ihres Hundes, um Infektionen zu bekämpfen und geschädigte Haut auf natürliche Weise zu heilen.
3 - Nährt Haut & Fell direkt
Biotin, Folsäure, Heidelbeer-Polyphenole, Omega-Fettsäuren und essentielle Vitamine nähren die Haut Ihres Hundes direkt und helfen bei der Reparatur. Plus diese sichtbaren Ergebnisse: weniger Haarausfall, mehr Glanz und ein glücklicherer, gesünderer Hund.
Il grattamento, il leccamento delle zampe e i problemi digestivi del tuo cane spesso iniziano con un intestino non sano, dove i batteri nocivi sopraffanno quelli buoni. Questo innesca un'infiammazione che colpisce la pelle e indebolisce il sistema immunitario.
gutQR fornisce una soluzione completa attraverso 3 fasi provate:
1 - Ripristina la salute intestinale
2 - Ripara il sistema immunitario indebolito
Il Colostro B.I.O.Ig ripara il sistema immunitario del tuo cane per combattere le infezioni e guarire naturalmente la pelle danneggiata.
3 - Nutre direttamente pelle e pelo
Biotina, acido folico, polifenoli del mirtillo, omega e vitamine essenziali nutrono direttamente la pelle del tuo cane per aiutare la riparazione. Più questi risultati visibili: meno perdita di pelo, più lucentezza e un cane più felice e sano.
Il grattamento, il leccamento delle zampe e i problemi digestivi del tuo cane spesso iniziano con un intestino non sano, dove i batteri nocivi sopraffanno quelli buoni. Questo innesca un'infiammazione che colpisce la pelle e indebolisce il sistema immunitario.
gutQR fornisce una soluzione completa attraverso 3 fasi provate:
1 - Ripristina la salute intestinale
2 - Ripara il sistema immunitario indebolito
Il Colostro B.I.O.Ig ripara il sistema immunitario del tuo cane per combattere le infezioni e guarire naturalmente la pelle danneggiata.
3 - Nutre direttamente pelle e pelo
Biotina, acido folico, polifenoli del mirtillo, omega e vitamine essenziali nutrono direttamente la pelle del tuo cane per aiutare la riparazione. Più questi risultati visibili: meno perdita di pelo, più lucentezza e un cane più felice e sano.
Il grattamento, il leccamento delle zampe e i problemi digestivi del tuo cane spesso iniziano con un intestino non sano, dove i batteri nocivi sopraffanno quelli buoni. Questo innesca un'infiammazione che colpisce la pelle e indebolisce il sistema immunitario.
gutQR fornisce una soluzione completa attraverso 3 fasi provate:
1 - Ripristina la salute intestinale
2 - Ripara il sistema immunitario indebolito
Il Colostro B.I.O.Ig ripara il sistema immunitario del tuo cane per combattere le infezioni e guarire naturalmente la pelle danneggiata.
3 - Nutre direttamente pelle e pelo
Biotina, acido folico, polifenoli del mirtillo, omega e vitamine essenziali nutrono direttamente la pelle del tuo cane per aiutare la riparazione. Più questi risultati visibili: meno perdita di pelo, più lucentezza e un cane più felice e sano.
Your dog's itching, scratching, paw licking, and digestive issues often start with an unhealthy gut, where harmful bacteria overwhelm the good ones. This triggers inflammation affecting the skin and weakens the immune system.
gutQR provides a complete solution through 3 proven steps:
1 - Restores Gut Health
2 - Repairs Weakened Immune System
Colostrum B.I.O.Ig repairs your dog's immune system to fight infections and heal damaged skin naturally.
3 - Directly Nourishes the Skin & Coat
Biotin, folic acid, blueberry polyphenols, omegas and essential vitamins directly nourish your dog's skin to help repair the damage. Plus these visible results: less shedding, more shine, and a happier, healthier dog.
Your dog's itching, scratching, paw licking, and digestive issues often start with an unhealthy gut, where harmful bacteria overwhelm the good ones. This triggers inflammation affecting the skin and weakens the immune system.
gutQR provides a complete solution through 3 proven steps:
1 - Restores Gut Health
2 - Repairs Weakened Immune System
Colostrum B.I.O.Ig repairs your dog's immune system to fight infections and heal damaged skin naturally.
3 - Directly Nourishes the Skin & Coat
Biotin, folic acid, blueberry polyphenols, omegas and essential vitamins directly nourish your dog's skin to help repair the damage. Plus these visible results: less shedding, more shine, and a happier, healthier dog.
Your dog's itching, scratching, paw licking, and digestive issues often start with an unhealthy gut, where harmful bacteria overwhelm the good ones. This triggers inflammation affecting the skin and weakens the immune system.
gutQR provides a complete solution through 3 proven steps:
1 - Restores Gut Health
2 - Repairs Weakened Immune System
Colostrum B.I.O.Ig repairs your dog's immune system to fight infections and heal damaged skin naturally.
3 - Directly Nourishes the Skin & Coat
Biotin, folic acid, blueberry polyphenols, omegas and essential vitamins directly nourish your dog's skin to help repair the damage. Plus these visible results: less shedding, more shine, and a happier, healthier dog.
| mg pro Portion | |
| Zutaten | |
| TechnoYEAST Hefe | 1058 |
| TechnoMOS Präbiotikum | 250 |
| B.I.O.Ig 20% Kolostrum | 250 |
| Biosprint Probiotikum | 560 |
| Calsporin Probiotikum | 33,3 |
| Enterococcus faecium DSM 10663 (Oralin) | 28,6 |
| HA108 Postbiotikum | 1 |
| EpiCor Pets Postbiotikum | 70 |
| FOS Chicorée-Wurzelextrakt Präbiotikum | 200 |
| Vitamin B1 | 2 |
| Vitamin B2 | 1 |
| Vitamin B5 | 1 |
| Vitamin B6 | 1 |
| Vitamin B12 | 0,01 |
| Vitamin C | 1,5 |
| Biotin | 4 |
| Folsäure | 0,2 |
| Vitamin E | 18 |
| Heidelbeere Polyphenole | 35 |
| DHA Gold | 120 |
| Zink (chelatiert) | 12 |
| mg pro Portion | |
| Zutaten | |
| TechnoYEAST Hefe | 1058 |
| TechnoMOS Präbiotikum | 250 |
| B.I.O.Ig 20% Kolostrum | 250 |
| Biosprint Probiotikum | 560 |
| Calsporin Probiotikum | 33,3 |
| Enterococcus faecium DSM 10663 (Oralin) | 28,6 |
| HA108 Postbiotikum | 1 |
| EpiCor Pets Postbiotikum | 70 |
| FOS Chicorée-Wurzelextrakt Präbiotikum | 200 |
| Vitamin B1 | 2 |
| Vitamin B2 | 1 |
| Vitamin B5 | 1 |
| Vitamin B6 | 1 |
| Vitamin B12 | 0,01 |
| Vitamin C | 1,5 |
| Biotin | 4 |
| Folsäure | 0,2 |
| Vitamin E | 18 |
| Heidelbeere Polyphenole | 35 |
| DHA Gold | 120 |
| Zink (chelatiert) | 12 |
| mg pro Portion | |
| Zutaten | |
| TechnoYEAST Hefe | 1058 |
| TechnoMOS Präbiotikum | 250 |
| B.I.O.Ig 20% Kolostrum | 250 |
| Biosprint Probiotikum | 560 |
| Calsporin Probiotikum | 33,3 |
| Enterococcus faecium DSM 10663 (Oralin) | 28,6 |
| HA108 Postbiotikum | 1 |
| EpiCor Pets Postbiotikum | 70 |
| FOS Chicorée-Wurzelextrakt Präbiotikum | 200 |
| Vitamin B1 | 2 |
| Vitamin B2 | 1 |
| Vitamin B5 | 1 |
| Vitamin B6 | 1 |
| Vitamin B12 | 0,01 |
| Vitamin C | 1,5 |
| Biotin | 4 |
| Folsäure | 0,2 |
| Vitamin E | 18 |
| Heidelbeere Polyphenole | 35 |
| DHA Gold | 120 |
| Zink (chelatiert) | 12 |
| mg per porzione | |
| Ingredienti | |
| TechnoYEAST lievito | 1058 |
| TechnoMOS prebiotico | 250 |
| Colostro B.I.O.Ig 20% | 250 |
| Biosprint probiotico | 560 |
| Calsporin probiotico | 33,3 |
| Enterococcus faecium DSM 10663 (Oralin) | 28,6 |
| EpiCor Pets postbiotico | 70 |
| HA108 postbiotico | 1 |
| FOS Estratto di radice di cicoria prebiotico | 200 |
| Vitamina B1 | 2 |
| Vitamina B2 | 1 |
| Vitamina B5 | 1 |
| Vitamina B6 | 1 |
| Vitamina B12 | 0,01 |
| Vitamina C | 1,5 |
| Biotina | 4 |
| Acido folico | 0,2 |
| Vitamina E | 18 |
| Polifenoli del mirtillo | 35 |
| DHA Gold | 120 |
| Zinco (chelato) | 12 |
| mg per porzione | |
| Ingredienti | |
| TechnoYEAST lievito | 1058 |
| TechnoMOS prebiotico | 250 |
| Colostro B.I.O.Ig 20% | 250 |
| Biosprint probiotico | 560 |
| Calsporin probiotico | 33,3 |
| Enterococcus faecium DSM 10663 (Oralin) | 28,6 |
| EpiCor Pets postbiotico | 70 |
| HA108 postbiotico | 1 |
| FOS Estratto di radice di cicoria prebiotico | 200 |
| Vitamina B1 | 2 |
| Vitamina B2 | 1 |
| Vitamina B5 | 1 |
| Vitamina B6 | 1 |
| Vitamina B12 | 0,01 |
| Vitamina C | 1,5 |
| Biotina | 4 |
| Acido folico | 0,2 |
| Vitamina E | 18 |
| Polifenoli del mirtillo | 35 |
| DHA Gold | 120 |
| Zinco (chelato) | 12 |
| mg per porzione | |
| Ingredienti | |
| TechnoYEAST lievito | 1058 |
| TechnoMOS prebiotico | 250 |
| Colostro B.I.O.Ig 20% | 250 |
| Biosprint probiotico | 560 |
| Calsporin probiotico | 33,3 |
| Enterococcus faecium DSM 10663 (Oralin) | 28,6 |
| EpiCor Pets postbiotico | 70 |
| HA108 postbiotico | 1 |
| FOS Estratto di radice di cicoria prebiotico | 200 |
| Vitamina B1 | 2 |
| Vitamina B2 | 1 |
| Vitamina B5 | 1 |
| Vitamina B6 | 1 |
| Vitamina B12 | 0,01 |
| Vitamina C | 1,5 |
| Biotina | 4 |
| Acido folico | 0,2 |
| Vitamina E | 18 |
| Polifenoli del mirtillo | 35 |
| DHA Gold | 120 |
| Zinco (chelato) | 12 |
| Ingredients | mg per serving |
| Yeast (dried) TECHNO YEAST Hydrolysed | 1058 |
| MOS (Mannooligosaccharides) TECHNO MOS | 250 |
| Colostrum Powder B.I.O.lg 20% | 250 |
| BIOSPRINT Probiotic Saccharomyces cerevisiae MUCL 39885 (8 Billion CFU) | 560 |
| Bacillus velezensis (Calsporin) (1 Billion CFU) | 33,3 |
| Enterococcus faecium (1 Billion CFU) | 28,6 |
| EpiCor Pets postbiotic | 70 |
| HA108 postbiotic | 1 |
| FOS Chicory Root Extract | 200 |
| Vitamin B1 | 2 |
| Vitamin B2 | 1 |
| Vitamin B5 | 1 |
| Vitamin B6 | 1 |
| Vitamin B12 | 0,01 |
| Biotin | 4 |
| Folic acid | 0,2 |
| Vitamin E (acetate powder) 50% Vit E | 35 |
| Blueberry Polyphenols | 35 |
| DHA Gold (Algal DHA) | 120 |
| Zinc (Zinpro Availa) | 12 |
| Natural tocopherols (antioxidant) | 10 |
| Ingredients | mg per serving |
| Yeast (dried) TECHNO YEAST Hydrolysed | 1058 |
| MOS (Mannooligosaccharides) TECHNO MOS | 250 |
| Colostrum Powder B.I.O.lg 20% | 250 |
| BIOSPRINT Probiotic Saccharomyces cerevisiae MUCL 39885 (8 Billion CFU) | 560 |
| Bacillus velezensis (Calsporin) (1 Billion CFU) | 33,3 |
| Enterococcus faecium (1 Billion CFU) | 28,6 |
| EpiCor Pets postbiotic | 70 |
| HA108 postbiotic | 1 |
| FOS Chicory Root Extract | 200 |
| Vitamin B1 | 2 |
| Vitamin B2 | 1 |
| Vitamin B5 | 1 |
| Vitamin B6 | 1 |
| Vitamin B12 | 0,01 |
| Biotin | 4 |
| Folic acid | 0,2 |
| Vitamin E (acetate powder) 50% Vit E | 35 |
| Blueberry Polyphenols | 35 |
| DHA Gold (Algal DHA) | 120 |
| Zinc (Zinpro Availa) | 12 |
| Natural tocopherols (antioxidant) | 10 |
| Ingredients | mg per serving |
| Yeast (dried) TECHNO YEAST Hydrolysed | 1058 |
| MOS (Mannooligosaccharides) TECHNO MOS | 250 |
| Colostrum Powder B.I.O.lg 20% | 250 |
| BIOSPRINT Probiotic Saccharomyces cerevisiae MUCL 39885 (8 Billion CFU) | 560 |
| Bacillus velezensis (Calsporin) (1 Billion CFU) | 33,3 |
| Enterococcus faecium (1 Billion CFU) | 28,6 |
| EpiCor Pets postbiotic | 70 |
| HA108 postbiotic | 1 |
| FOS Chicory Root Extract | 200 |
| Vitamin B1 | 2 |
| Vitamin B2 | 1 |
| Vitamin B5 | 1 |
| Vitamin B6 | 1 |
| Vitamin B12 | 0,01 |
| Biotin | 4 |
| Folic acid | 0,2 |
| Vitamin E (acetate powder) 50% Vit E | 35 |
| Blueberry Polyphenols | 35 |
| DHA Gold (Algal DHA) | 120 |
| Zinc (Zinpro Availa) | 12 |
| Natural tocopherols (antioxidant) | 10 |
Problema di salute | Uso sicuro? | Informazioni aggiuntive |
| Qualsiasi razza di cane | Sì | gutQR è adatto a tutte le razze di cani |
| Qualsiasi taglia di cane | Sì | gutQR è adatto a tutte le taglie di cani |
| Cuccioli (sotto i 6 mesi) | No | Non adatto ai cani di età inferiore ai 6 mesi |
| Cuccioli (sopra i 6 mesi) | Sì | Adatto ai cani di età superiore ai 6 mesi |
| Shunt portosistemico | Sì | / |
| Pancreatite | Sì | / |
| Disbiosi | Sì | gutQR supporta la salute del microbioma intestinale. |
| Insufficienza epatica pancreatica o altri problemi epatici | Sì | Nessun ingrediente di gutQR danneggia il fegato. |
| Allergie alimentari/Dermatite | Sì | gutQR è ipoallergenico e non contiene allergeni. |
| Leishmaniosi | Sì | Utilizzate regolarmente gutQR per un supporto immunitario a lungo termine. |
| Gastrite cronica | Sì | gutQR favorisce la salute dell'apparato digerente del cane. Controllare l'elenco degli ingredienti per assicurarsi che il cane non abbia intolleranze specifiche agli ingredienti di gutQR. |
| Enterite cronica | Sì | Supporta la salute intestinale e aiuta a risolvere i problemi di digestione. |
| Insufficienza pancreatica | Sì | Aiuta la flora intestinale. Usare regolarmente per una salute a lungo termine. |
| Malassezia | Sì | Supporta l'immunità e la salute intestinale. |
Problema di salute | Uso sicuro? | Informazioni aggiuntive |
| Qualsiasi razza di cane | Sì | gutQR è adatto a tutte le razze di cani |
| Qualsiasi taglia di cane | Sì | gutQR è adatto a tutte le taglie di cani |
| Cuccioli (sotto i 6 mesi) | No | Non adatto ai cani di età inferiore ai 6 mesi |
| Cuccioli (sopra i 6 mesi) | Sì | Adatto ai cani di età superiore ai 6 mesi |
| Shunt portosistemico | Sì | / |
| Pancreatite | Sì | / |
| Disbiosi | Sì | gutQR supporta la salute del microbioma intestinale. |
| Insufficienza epatica pancreatica o altri problemi epatici | Sì | Nessun ingrediente di gutQR danneggia il fegato. |
| Allergie alimentari/Dermatite | Sì | gutQR è ipoallergenico e non contiene allergeni. |
| Leishmaniosi | Sì | Utilizzate regolarmente gutQR per un supporto immunitario a lungo termine. |
| Gastrite cronica | Sì | gutQR favorisce la salute dell'apparato digerente del cane. Controllare l'elenco degli ingredienti per assicurarsi che il cane non abbia intolleranze specifiche agli ingredienti di gutQR. |
| Enterite cronica | Sì | Supporta la salute intestinale e aiuta a risolvere i problemi di digestione. |
| Insufficienza pancreatica | Sì | Aiuta la flora intestinale. Usare regolarmente per una salute a lungo termine. |
| Malassezia | Sì | Supporta l'immunità e la salute intestinale. |
Problema di salute | Uso sicuro? | Informazioni aggiuntive |
| Qualsiasi razza di cane | Sì | gutQR è adatto a tutte le razze di cani |
| Qualsiasi taglia di cane | Sì | gutQR è adatto a tutte le taglie di cani |
| Cuccioli (sotto i 6 mesi) | No | Non adatto ai cani di età inferiore ai 6 mesi |
| Cuccioli (sopra i 6 mesi) | Sì | Adatto ai cani di età superiore ai 6 mesi |
| Shunt portosistemico | Sì | / |
| Pancreatite | Sì | / |
| Disbiosi | Sì | gutQR supporta la salute del microbioma intestinale. |
| Insufficienza epatica pancreatica o altri problemi epatici | Sì | Nessun ingrediente di gutQR danneggia il fegato. |
| Allergie alimentari/Dermatite | Sì | gutQR è ipoallergenico e non contiene allergeni. |
| Leishmaniosi | Sì | Utilizzate regolarmente gutQR per un supporto immunitario a lungo termine. |
| Gastrite cronica | Sì | gutQR favorisce la salute dell'apparato digerente del cane. Controllare l'elenco degli ingredienti per assicurarsi che il cane non abbia intolleranze specifiche agli ingredienti di gutQR. |
| Enterite cronica | Sì | Supporta la salute intestinale e aiuta a risolvere i problemi di digestione. |
| Insufficienza pancreatica | Sì | Aiuta la flora intestinale. Usare regolarmente per una salute a lungo termine. |
| Malassezia | Sì | Supporta l'immunità e la salute intestinale. |
Gesund-heitsproblem | Sicher zu benu-tzen? | Zusätzliche Informationen |
| Jede Hunderasse | Ja | gutQR ist für alle Hunderassen geeignet. |
| Jede Hundegröße | Ja | gutQR ist für alle Hundegrößen geeignet. |
| Welpen (unter 6 Monaten) | Nein | Nicht geeignet für Hunde unter 6 Monaten. |
| Welpen (über 6 Monaten) | Ja | Geeignet für Hunde über 6 Monate. |
| Portosys-temischer Shunt | Ja | / |
| Pankreatitis | Ja | / |
| Dysbiose | Ja | gutQR unterstützt die Gesundheit des Darmmikrobioms. |
| Pankreas-leberin-suffizienz oder andere Leberprobleme | Ja | Keine Inhaltsstoffe in gutQR, die der Leber schädigen könnten. |
| Lebensmittel-allergien/ Dermatitis | Ja | gutQR ist hypoallergen und enthält keine Allergene. |
| Leishmaniose | Ja | Verwende gutQR regelmäßig zur langfristigen Unterstützung des Immunsystems Ihres Hundes. |
| Chronische Gastritis | Ja | gutQR unterstützt die Verdauungsgesundheit Ihres Hundes. Überprüfen Sie die Zutatenliste, um sicherzustellen, dass Ihr Hund keine spezifischen Unverträglichkeiten gegenüber den Inhaltsstoffen von gutQR hat. |
| Chronische Enteritis | Ja | Unterstützt die Darmgesundheit und hilft bei Verdauungsproblemen. |
| Pankreasins-uffizienz | Ja | Hilft der Darmflora. Verwenden Sie es regelmäßig für die langfristige Gesundheit Ihres Hundes. |
| Malassezia | Ja | Unterstützt das Immunsystem und die Darmgesundheit. |
Gesund-heitsproblem | Sicher zu benu-tzen? | Zusätzliche Informationen |
| Jede Hunderasse | Ja | gutQR ist für alle Hunderassen geeignet. |
| Jede Hundegröße | Ja | gutQR ist für alle Hundegrößen geeignet. |
| Welpen (unter 6 Monaten) | Nein | Nicht geeignet für Hunde unter 6 Monaten. |
| Welpen (über 6 Monaten) | Ja | Geeignet für Hunde über 6 Monate. |
| Portosys-temischer Shunt | Ja | / |
| Pankreatitis | Ja | / |
| Dysbiose | Ja | gutQR unterstützt die Gesundheit des Darmmikrobioms. |
| Pankreas-leberin-suffizienz oder andere Leberprobleme | Ja | Keine Inhaltsstoffe in gutQR, die der Leber schädigen könnten. |
| Lebensmittel-allergien/ Dermatitis | Ja | gutQR ist hypoallergen und enthält keine Allergene. |
| Leishmaniose | Ja | Verwende gutQR regelmäßig zur langfristigen Unterstützung des Immunsystems Ihres Hundes. |
| Chronische Gastritis | Ja | gutQR unterstützt die Verdauungsgesundheit Ihres Hundes. Überprüfen Sie die Zutatenliste, um sicherzustellen, dass Ihr Hund keine spezifischen Unverträglichkeiten gegenüber den Inhaltsstoffen von gutQR hat. |
| Chronische Enteritis | Ja | Unterstützt die Darmgesundheit und hilft bei Verdauungsproblemen. |
| Pankreasins-uffizienz | Ja | Hilft der Darmflora. Verwenden Sie es regelmäßig für die langfristige Gesundheit Ihres Hundes. |
| Malassezia | Ja | Unterstützt das Immunsystem und die Darmgesundheit. |
Gesund-heitsproblem | Sicher zu benu-tzen? | Zusätzliche Informationen |
| Jede Hunderasse | Ja | gutQR ist für alle Hunderassen geeignet. |
| Jede Hundegröße | Ja | gutQR ist für alle Hundegrößen geeignet. |
| Welpen (unter 6 Monaten) | Nein | Nicht geeignet für Hunde unter 6 Monaten. |
| Welpen (über 6 Monaten) | Ja | Geeignet für Hunde über 6 Monate. |
| Portosys-temischer Shunt | Ja | / |
| Pankreatitis | Ja | / |
| Dysbiose | Ja | gutQR unterstützt die Gesundheit des Darmmikrobioms. |
| Pankreas-leberin-suffizienz oder andere Leberprobleme | Ja | Keine Inhaltsstoffe in gutQR, die der Leber schädigen könnten. |
| Lebensmittel-allergien/ Dermatitis | Ja | gutQR ist hypoallergen und enthält keine Allergene. |
| Leishmaniose | Ja | Verwende gutQR regelmäßig zur langfristigen Unterstützung des Immunsystems Ihres Hundes. |
| Chronische Gastritis | Ja | gutQR unterstützt die Verdauungsgesundheit Ihres Hundes. Überprüfen Sie die Zutatenliste, um sicherzustellen, dass Ihr Hund keine spezifischen Unverträglichkeiten gegenüber den Inhaltsstoffen von gutQR hat. |
| Chronische Enteritis | Ja | Unterstützt die Darmgesundheit und hilft bei Verdauungsproblemen. |
| Pankreasins-uffizienz | Ja | Hilft der Darmflora. Verwenden Sie es regelmäßig für die langfristige Gesundheit Ihres Hundes. |
| Malassezia | Ja | Unterstützt das Immunsystem und die Darmgesundheit. |
Health Issue | Safe to Use? | Additional Info |
| Any dog breed | Yes | gutQR is suitable for all dog breeds |
| Any dog size | Yes | gutQR is suitable for all dog sizes |
| Puppies (under 6 months) | No | Not suitable for dogs under 6 months |
| Puppies (above 6 months) | Yes | Suitable for dogs over 6 months |
| Portosys-temic Shunt | Yes | / |
| Pancreatitis | Yes | / |
| Dysbiosis | Yes | gutQR supports gut microbiome health. |
| Pancreatic Liver Failure or other liver problems | Yes | No ingredients in gutQR harm the liver. |
| Food Allergies/ Dermatitis | Yes | gutQR is hypoallergenic and doesn't contain any allergens. |
| Leishman-iasis | Yes | Use gutQR regularly for long-term immune support. |
| Chronic Gastritis | Yes | gutQR supports your dog's digestive health. Do review the ingredient list to make sure your dog has no specific intolerances to gutQR ingredients. |
| Chronic Enteritis | Yes | Supports gut health and helps with digestion issues. |
| Pancreatic Insufficiency | Yes | Helps gut flora. Use regularly for long-term health. |
| Malassezia | Yes | Supports immunity and gut health. |
Health Issue | Safe to Use? | Additional Info |
| Any dog breed | Yes | gutQR is suitable for all dog breeds |
| Any dog size | Yes | gutQR is suitable for all dog sizes |
| Puppies (under 6 months) | No | Not suitable for dogs under 6 months |
| Puppies (above 6 months) | Yes | Suitable for dogs over 6 months |
| Portosys-temic Shunt | Yes | / |
| Pancreatitis | Yes | / |
| Dysbiosis | Yes | gutQR supports gut microbiome health. |
| Pancreatic Liver Failure or other liver problems | Yes | No ingredients in gutQR harm the liver. |
| Food Allergies/ Dermatitis | Yes | gutQR is hypoallergenic and doesn't contain any allergens. |
| Leishman-iasis | Yes | Use gutQR regularly for long-term immune support. |
| Chronic Gastritis | Yes | gutQR supports your dog's digestive health. Do review the ingredient list to make sure your dog has no specific intolerances to gutQR ingredients. |
| Chronic Enteritis | Yes | Supports gut health and helps with digestion issues. |
| Pancreatic Insufficiency | Yes | Helps gut flora. Use regularly for long-term health. |
| Malassezia | Yes | Supports immunity and gut health. |
Health Issue | Safe to Use? | Additional Info |
| Any dog breed | Yes | gutQR is suitable for all dog breeds |
| Any dog size | Yes | gutQR is suitable for all dog sizes |
| Puppies (under 6 months) | No | Not suitable for dogs under 6 months |
| Puppies (above 6 months) | Yes | Suitable for dogs over 6 months |
| Portosys-temic Shunt | Yes | / |
| Pancreatitis | Yes | / |
| Dysbiosis | Yes | gutQR supports gut microbiome health. |
| Pancreatic Liver Failure or other liver problems | Yes | No ingredients in gutQR harm the liver. |
| Food Allergies/ Dermatitis | Yes | gutQR is hypoallergenic and doesn't contain any allergens. |
| Leishman-iasis | Yes | Use gutQR regularly for long-term immune support. |
| Chronic Gastritis | Yes | gutQR supports your dog's digestive health. Do review the ingredient list to make sure your dog has no specific intolerances to gutQR ingredients. |
| Chronic Enteritis | Yes | Supports gut health and helps with digestion issues. |
| Pancreatic Insufficiency | Yes | Helps gut flora. Use regularly for long-term health. |
| Malassezia | Yes | Supports immunity and gut health. |
La maggior parte dei prodotti probiotici per cani presenti sul mercato contiene pochi o nessun probiotico vivo.
Veniamo dal mondo dei probiotici per uso umano e sappiamo cosa serve per realizzare un prodotto probiotico valido. Perché solo i probiotici vivi funzionano e hanno un impatto benefico.
La maggior parte dei prodotti probiotici e persino le polveri per cani in circolazione contengono pochi o nessun probiotico vivo.
Cosa distrugge i probiotici vivi?
Sfortunatamente, molte cose.
Calore e pressione nel processo di produzione
Aggiunta di acidi nel processo di produzione
Umidità nel processo di produzione
Altri ingredienti attivi nel prodotto
Umidità dopo la realizzazione del prodotto
Tempo
Perché questo è un problema soprattutto per i bocconcini per cani?
I processi di produzione dei bocconcini per cani richiedono solitamente calore e pressione, fattori che distruggono i probiotici.
Metodi di produzione alternativi a temperature più basse richiedono invece acidi o più umidità, che ugualmente distruggono i probiotici.
Molti produttori e marchi di integratori per cani non comprendono le sfide legate alla produzione di prodotti con probiotici vivi, non introducono le misure necessarie per proteggerli e non testano i loro prodotti per verificare la sopravvivenza dei probiotici.
Non esistono ancora normative che impongano ai produttori di dichiarare quanti probiotici vivi sono presenti nel prodotto fino alla fine della vita di scaffale, come avviene per gli integratori per uso umano, ma piuttosto di dichiarare quanti ne sono stati inseriti prima della produzione. Quindi non si può sapere quanti probiotici vivi riceva effettivamente il cane, ma solo quanti ne siano stati inseriti.
Non tutti gli integratori probiotici presenti sul mercato sono "cattivi", ma molti presentano questi problemi.
Lo sappiamo, ne abbiamo testati molti.
Come proteggiamo i probiotici vivi per essere sicuri di garantire ciò che pagate e che il vostro cane riceva ciò di cui ha bisogno?
gutQR è sotto forma di polvere, che è la forma più sicura per mantenere i probiotici vivi, poiché non c'è calore, pressione o acidi.
Controlliamo l'umidità durante tutte le fasi del processo di produzione, per essere certi di mantenere vivi i probiotici.
Utilizziamo uno speciale barattolo brevettato che protegge i probiotici dall'umidità dopo l'apertura del barattolo.
Testiamo la sopravvivenza dei probiotici dopo il processo di produzione.
Facciamo il massimo per assicurarci che il vostro cane riceva i probiotici di cui ha bisogno per la sua salute!
La maggior parte dei prodotti probiotici per cani presenti sul mercato contiene pochi o nessun probiotico vivo.
Veniamo dal mondo dei probiotici per uso umano e sappiamo cosa serve per realizzare un prodotto probiotico valido. Perché solo i probiotici vivi funzionano e hanno un impatto benefico.
La maggior parte dei prodotti probiotici e persino le polveri per cani in circolazione contengono pochi o nessun probiotico vivo.
Cosa distrugge i probiotici vivi?
Sfortunatamente, molte cose.
Calore e pressione nel processo di produzione
Aggiunta di acidi nel processo di produzione
Umidità nel processo di produzione
Altri ingredienti attivi nel prodotto
Umidità dopo la realizzazione del prodotto
Tempo
Perché questo è un problema soprattutto per i bocconcini per cani?
I processi di produzione dei bocconcini per cani richiedono solitamente calore e pressione, fattori che distruggono i probiotici.
Metodi di produzione alternativi a temperature più basse richiedono invece acidi o più umidità, che ugualmente distruggono i probiotici.
Molti produttori e marchi di integratori per cani non comprendono le sfide legate alla produzione di prodotti con probiotici vivi, non introducono le misure necessarie per proteggerli e non testano i loro prodotti per verificare la sopravvivenza dei probiotici.
Non esistono ancora normative che impongano ai produttori di dichiarare quanti probiotici vivi sono presenti nel prodotto fino alla fine della vita di scaffale, come avviene per gli integratori per uso umano, ma piuttosto di dichiarare quanti ne sono stati inseriti prima della produzione. Quindi non si può sapere quanti probiotici vivi riceva effettivamente il cane, ma solo quanti ne siano stati inseriti.
Non tutti gli integratori probiotici presenti sul mercato sono "cattivi", ma molti presentano questi problemi.
Lo sappiamo, ne abbiamo testati molti.
Come proteggiamo i probiotici vivi per essere sicuri di garantire ciò che pagate e che il vostro cane riceva ciò di cui ha bisogno?
gutQR è sotto forma di polvere, che è la forma più sicura per mantenere i probiotici vivi, poiché non c'è calore, pressione o acidi.
Controlliamo l'umidità durante tutte le fasi del processo di produzione, per essere certi di mantenere vivi i probiotici.
Utilizziamo uno speciale barattolo brevettato che protegge i probiotici dall'umidità dopo l'apertura del barattolo.
Testiamo la sopravvivenza dei probiotici dopo il processo di produzione.
Facciamo il massimo per assicurarci che il vostro cane riceva i probiotici di cui ha bisogno per la sua salute!
La maggior parte dei prodotti probiotici per cani presenti sul mercato contiene pochi o nessun probiotico vivo.
Veniamo dal mondo dei probiotici per uso umano e sappiamo cosa serve per realizzare un prodotto probiotico valido. Perché solo i probiotici vivi funzionano e hanno un impatto benefico.
La maggior parte dei prodotti probiotici e persino le polveri per cani in circolazione contengono pochi o nessun probiotico vivo.
Cosa distrugge i probiotici vivi?
Sfortunatamente, molte cose.
Calore e pressione nel processo di produzione
Aggiunta di acidi nel processo di produzione
Umidità nel processo di produzione
Altri ingredienti attivi nel prodotto
Umidità dopo la realizzazione del prodotto
Tempo
Perché questo è un problema soprattutto per i bocconcini per cani?
I processi di produzione dei bocconcini per cani richiedono solitamente calore e pressione, fattori che distruggono i probiotici.
Metodi di produzione alternativi a temperature più basse richiedono invece acidi o più umidità, che ugualmente distruggono i probiotici.
Molti produttori e marchi di integratori per cani non comprendono le sfide legate alla produzione di prodotti con probiotici vivi, non introducono le misure necessarie per proteggerli e non testano i loro prodotti per verificare la sopravvivenza dei probiotici.
Non esistono ancora normative che impongano ai produttori di dichiarare quanti probiotici vivi sono presenti nel prodotto fino alla fine della vita di scaffale, come avviene per gli integratori per uso umano, ma piuttosto di dichiarare quanti ne sono stati inseriti prima della produzione. Quindi non si può sapere quanti probiotici vivi riceva effettivamente il cane, ma solo quanti ne siano stati inseriti.
Non tutti gli integratori probiotici presenti sul mercato sono "cattivi", ma molti presentano questi problemi.
Lo sappiamo, ne abbiamo testati molti.
Come proteggiamo i probiotici vivi per essere sicuri di garantire ciò che pagate e che il vostro cane riceva ciò di cui ha bisogno?
gutQR è sotto forma di polvere, che è la forma più sicura per mantenere i probiotici vivi, poiché non c'è calore, pressione o acidi.
Controlliamo l'umidità durante tutte le fasi del processo di produzione, per essere certi di mantenere vivi i probiotici.
Utilizziamo uno speciale barattolo brevettato che protegge i probiotici dall'umidità dopo l'apertura del barattolo.
Testiamo la sopravvivenza dei probiotici dopo il processo di produzione.
Facciamo il massimo per assicurarci che il vostro cane riceva i probiotici di cui ha bisogno per la sua salute!
Die meisten probiotischen Produkte für Hunde enthalten wenig oder gar keine lebenden Probiotika
Wir kommen aus der Welt der Humanprobiotika und wissen, was es braucht, um ein wirksames Probiotikum herzustellen. Denn nur lebende Probiotika wirken und haben einen positiven Einfluss.
Die meisten probiotischen Leckerlis und sogar Pulver für Hunde enthalten wenig oder gar keine lebenden Probiotika.
Was tötet lebende Probiotika ab?
Leider viele Dinge:
Hitze und Druck während des Produktionsprozesses
Zugabe von Säuren während des Produktionsprozesses
Feuchtigkeit während des Produktionsprozesses
Andere Wirkstoffe im Produkt
Feuchtigkeit nach der Herstellung
Zeit
Warum ist dies besonders bei Hundesnacks ein Problem?
Bei der Herstellung von Hundesnacks werden in der Regel Hitze und Druck eingesetzt, die die Probiotika abtöten.
Alternative Herstellungsverfahren bei niedrigeren Temperaturen benötigen stattdessen Säuren oder mehr Feuchtigkeit, die ebenfalls Probiotika abtöten.
Viele Hersteller von Ergänzungsfuttermitteln für Hunde sind sich der Herausforderungen bei der Herstellung von Produkten mit lebenden Probiotika nicht bewusst, ergreifen nicht die erforderlichen Schutzmaßnahmen und testen ihre Produkte nicht auf die Überlebensfähigkeit der Probiotika nach der Herstellung.
Es gibt noch keine Vorschriften, die die Hersteller verpflichten, anzugeben, wie viele lebende Probiotika bis zum Ende der Haltbarkeitsdauer im Produkt enthalten sind, wie es bei Nahrungsergänzungsmitteln für Menschen der Fall ist. Es wird nur die Menge angegeben, die vor der Herstellung enthalten war. Sie wissen also nicht genau, wie viele lebende Probiotika Ihr Hund tatsächlich erhält, sondern nur, wie viele ursprünglich zugesetzt wurden.
Nicht alle probiotischen Ergänzungsfuttermittel auf dem Markt sind "schlecht", aber viele haben diese Probleme.
Wir wissen das, weil wir viele getestet haben.
Wie schützen wir die lebenden Probiotika, damit Sie bekommen, wofür Sie bezahlen und Ihr Hund bekommt, was er braucht?
gutQR ist in Pulverform, was die sicherste Form ist, um Probiotika am Leben zu erhalten, da weder Hitze, Druck noch Säuren verwendet werden.
Wir kontrollieren die Feuchtigkeit in allen Phasen des Produktionsprozesses, um sicherzustellen, dass die Probiotika lebendig bleiben.
Wir verwenden einen speziellen patentierten Behälter, der die Probiotika nach dem Öffnen vor Feuchtigkeit schützt.
Wir testen die Überlebensfähigkeit der Probiotika nach dem Produktionsprozess.
Wir gehen die extra Meile", um sicherzustellen, dass Ihr Hund die Probiotika erhält, die er braucht, um gesund zu bleiben!
Die meisten probiotischen Produkte für Hunde enthalten wenig oder gar keine lebenden Probiotika
Wir kommen aus der Welt der Humanprobiotika und wissen, was es braucht, um ein wirksames Probiotikum herzustellen. Denn nur lebende Probiotika wirken und haben einen positiven Einfluss.
Die meisten probiotischen Leckerlis und sogar Pulver für Hunde enthalten wenig oder gar keine lebenden Probiotika.
Was tötet lebende Probiotika ab?
Leider viele Dinge:
Hitze und Druck während des Produktionsprozesses
Zugabe von Säuren während des Produktionsprozesses
Feuchtigkeit während des Produktionsprozesses
Andere Wirkstoffe im Produkt
Feuchtigkeit nach der Herstellung
Zeit
Warum ist dies besonders bei Hundesnacks ein Problem?
Bei der Herstellung von Hundesnacks werden in der Regel Hitze und Druck eingesetzt, die die Probiotika abtöten.
Alternative Herstellungsverfahren bei niedrigeren Temperaturen benötigen stattdessen Säuren oder mehr Feuchtigkeit, die ebenfalls Probiotika abtöten.
Viele Hersteller von Ergänzungsfuttermitteln für Hunde sind sich der Herausforderungen bei der Herstellung von Produkten mit lebenden Probiotika nicht bewusst, ergreifen nicht die erforderlichen Schutzmaßnahmen und testen ihre Produkte nicht auf die Überlebensfähigkeit der Probiotika nach der Herstellung.
Es gibt noch keine Vorschriften, die die Hersteller verpflichten, anzugeben, wie viele lebende Probiotika bis zum Ende der Haltbarkeitsdauer im Produkt enthalten sind, wie es bei Nahrungsergänzungsmitteln für Menschen der Fall ist. Es wird nur die Menge angegeben, die vor der Herstellung enthalten war. Sie wissen also nicht genau, wie viele lebende Probiotika Ihr Hund tatsächlich erhält, sondern nur, wie viele ursprünglich zugesetzt wurden.
Nicht alle probiotischen Ergänzungsfuttermittel auf dem Markt sind "schlecht", aber viele haben diese Probleme.
Wir wissen das, weil wir viele getestet haben.
Wie schützen wir die lebenden Probiotika, damit Sie bekommen, wofür Sie bezahlen und Ihr Hund bekommt, was er braucht?
gutQR ist in Pulverform, was die sicherste Form ist, um Probiotika am Leben zu erhalten, da weder Hitze, Druck noch Säuren verwendet werden.
Wir kontrollieren die Feuchtigkeit in allen Phasen des Produktionsprozesses, um sicherzustellen, dass die Probiotika lebendig bleiben.
Wir verwenden einen speziellen patentierten Behälter, der die Probiotika nach dem Öffnen vor Feuchtigkeit schützt.
Wir testen die Überlebensfähigkeit der Probiotika nach dem Produktionsprozess.
Wir gehen die extra Meile", um sicherzustellen, dass Ihr Hund die Probiotika erhält, die er braucht, um gesund zu bleiben!
Die meisten probiotischen Produkte für Hunde enthalten wenig oder gar keine lebenden Probiotika
Wir kommen aus der Welt der Humanprobiotika und wissen, was es braucht, um ein wirksames Probiotikum herzustellen. Denn nur lebende Probiotika wirken und haben einen positiven Einfluss.
Die meisten probiotischen Leckerlis und sogar Pulver für Hunde enthalten wenig oder gar keine lebenden Probiotika.
Was tötet lebende Probiotika ab?
Leider viele Dinge:
Hitze und Druck während des Produktionsprozesses
Zugabe von Säuren während des Produktionsprozesses
Feuchtigkeit während des Produktionsprozesses
Andere Wirkstoffe im Produkt
Feuchtigkeit nach der Herstellung
Zeit
Warum ist dies besonders bei Hundesnacks ein Problem?
Bei der Herstellung von Hundesnacks werden in der Regel Hitze und Druck eingesetzt, die die Probiotika abtöten.
Alternative Herstellungsverfahren bei niedrigeren Temperaturen benötigen stattdessen Säuren oder mehr Feuchtigkeit, die ebenfalls Probiotika abtöten.
Viele Hersteller von Ergänzungsfuttermitteln für Hunde sind sich der Herausforderungen bei der Herstellung von Produkten mit lebenden Probiotika nicht bewusst, ergreifen nicht die erforderlichen Schutzmaßnahmen und testen ihre Produkte nicht auf die Überlebensfähigkeit der Probiotika nach der Herstellung.
Es gibt noch keine Vorschriften, die die Hersteller verpflichten, anzugeben, wie viele lebende Probiotika bis zum Ende der Haltbarkeitsdauer im Produkt enthalten sind, wie es bei Nahrungsergänzungsmitteln für Menschen der Fall ist. Es wird nur die Menge angegeben, die vor der Herstellung enthalten war. Sie wissen also nicht genau, wie viele lebende Probiotika Ihr Hund tatsächlich erhält, sondern nur, wie viele ursprünglich zugesetzt wurden.
Nicht alle probiotischen Ergänzungsfuttermittel auf dem Markt sind "schlecht", aber viele haben diese Probleme.
Wir wissen das, weil wir viele getestet haben.
Wie schützen wir die lebenden Probiotika, damit Sie bekommen, wofür Sie bezahlen und Ihr Hund bekommt, was er braucht?
gutQR ist in Pulverform, was die sicherste Form ist, um Probiotika am Leben zu erhalten, da weder Hitze, Druck noch Säuren verwendet werden.
Wir kontrollieren die Feuchtigkeit in allen Phasen des Produktionsprozesses, um sicherzustellen, dass die Probiotika lebendig bleiben.
Wir verwenden einen speziellen patentierten Behälter, der die Probiotika nach dem Öffnen vor Feuchtigkeit schützt.
Wir testen die Überlebensfähigkeit der Probiotika nach dem Produktionsprozess.
Wir gehen die extra Meile", um sicherzustellen, dass Ihr Hund die Probiotika erhält, die er braucht, um gesund zu bleiben!
Most probiotic products in the market for dogs contain little to no alive probiotics
We come from the world of human probiotics and understand what it takes to make a viable probiotic product. Because only live probiotics work and have a beneficial impact.
Most probiotic treats and even powders for dogs out there contain little to no alive probiotics.
What kills live probiotics?
Unfortunatelly, many things.
Heat and pressure in production process
Adding acids in production process
Moisture in production process
Other active ingredients in the product
Humidity after the product has been made
Time
Why this is especially a problem for dog treats?
Dog treats production processes usually require heat and pressure, which will kill probiotics.
Alternative production methods at lower temperatures instead require acids or more humidity, which also kills probiotics.
Many dog supplement producers and brands don't understand the challenges of producing products with live probiotics and don't introduce the necessary measure to protect them, and don't test their products for probiotic survivability after.
There are still no regulations that would require producers to state how many alive probiotics are in the product until the end of shelf-life, like for human supplements, but rather just how much was put in before production. So you really don't know how many live probiotics your dog is actually getting, just how many went in.
Not all probiotic supplements on the market are "bad", but many have these problems.
We know, we tested many of them.
How we protect the live probiotics to make sure you get what you pay for and your dog gets what they need?
gutQR is in powder form, which is the safest form to keep probiotics alive, since there is no heat, pressure or acids.
We control for humidity during all phases of the production process, to make sure we keep probiotics alive.
We use a special patented jar that protects the probiotics from humidity after you've opened the jar.
We test for probiotic survivability after the production process.
We go to the "extreme extra mile" to make sure your dog gets the probiotics they need to thrive!
Most probiotic products in the market for dogs contain little to no alive probiotics
We come from the world of human probiotics and understand what it takes to make a viable probiotic product. Because only live probiotics work and have a beneficial impact.
Most probiotic treats and even powders for dogs out there contain little to no alive probiotics.
What kills live probiotics?
Unfortunatelly, many things.
Heat and pressure in production process
Adding acids in production process
Moisture in production process
Other active ingredients in the product
Humidity after the product has been made
Time
Why this is especially a problem for dog treats?
Dog treats production processes usually require heat and pressure, which will kill probiotics.
Alternative production methods at lower temperatures instead require acids or more humidity, which also kills probiotics.
Many dog supplement producers and brands don't understand the challenges of producing products with live probiotics and don't introduce the necessary measure to protect them, and don't test their products for probiotic survivability after.
There are still no regulations that would require producers to state how many alive probiotics are in the product until the end of shelf-life, like for human supplements, but rather just how much was put in before production. So you really don't know how many live probiotics your dog is actually getting, just how many went in.
Not all probiotic supplements on the market are "bad", but many have these problems.
We know, we tested many of them.
How we protect the live probiotics to make sure you get what you pay for and your dog gets what they need?
gutQR is in powder form, which is the safest form to keep probiotics alive, since there is no heat, pressure or acids.
We control for humidity during all phases of the production process, to make sure we keep probiotics alive.
We use a special patented jar that protects the probiotics from humidity after you've opened the jar.
We test for probiotic survivability after the production process.
We go to the "extreme extra mile" to make sure your dog gets the probiotics they need to thrive!
Most probiotic products in the market for dogs contain little to no alive probiotics
We come from the world of human probiotics and understand what it takes to make a viable probiotic product. Because only live probiotics work and have a beneficial impact.
Most probiotic treats and even powders for dogs out there contain little to no alive probiotics.
What kills live probiotics?
Unfortunatelly, many things.
Heat and pressure in production process
Adding acids in production process
Moisture in production process
Other active ingredients in the product
Humidity after the product has been made
Time
Why this is especially a problem for dog treats?
Dog treats production processes usually require heat and pressure, which will kill probiotics.
Alternative production methods at lower temperatures instead require acids or more humidity, which also kills probiotics.
Many dog supplement producers and brands don't understand the challenges of producing products with live probiotics and don't introduce the necessary measure to protect them, and don't test their products for probiotic survivability after.
There are still no regulations that would require producers to state how many alive probiotics are in the product until the end of shelf-life, like for human supplements, but rather just how much was put in before production. So you really don't know how many live probiotics your dog is actually getting, just how many went in.
Not all probiotic supplements on the market are "bad", but many have these problems.
We know, we tested many of them.
How we protect the live probiotics to make sure you get what you pay for and your dog gets what they need?
gutQR is in powder form, which is the safest form to keep probiotics alive, since there is no heat, pressure or acids.
We control for humidity during all phases of the production process, to make sure we keep probiotics alive.
We use a special patented jar that protects the probiotics from humidity after you've opened the jar.
We test for probiotic survivability after the production process.
We go to the "extreme extra mile" to make sure your dog gets the probiotics they need to thrive!
Wie helfen Präbiotika, Probiotika und Postbiotika bei Darm- und Hautproblemen Ihres Hundes
Juckreiz, Kratzen und Lecken an den Pfoten sind häufig Anzeichen für ein Ungleichgewicht im Darmmikrobiom Ihres Hundes, bei dem die schädlichen Bakterien gegenüber den nützlichen überwiegen. Dieses Ungleichgewicht kann zu Entzündungen führen, die sich auf die Haut Ihres Hundes auswirken.
Ein gesunder Darm ist wichtig für die allgemeine Gesundheit und beeinflusst die Verdauung, die Nährstoffaufnahme und die Immunfunktion. Wenn der Darm aus dem Gleichgewicht gerät, kann dies zu Hautproblemen und anderen langfristigen Gesundheitsproblemen führen.
Um das Gleichgewicht wiederherzustellen, ist eine Kombination aus Präbiotika, Probiotika und Postbiotika erforderlich.
1. Präbiotika ernähren die guten Bakterien im Darm und helfen ihnen, zu gedeihen und ein ausgewogenes Milieu zu schaffen.
2. Probiotika bringen lebende, nützliche Bakterien in den Darm, um die Darmgesundheit wiederherzustellen.
3. Postbiotika liefern sofort wirksame Verbindungen, die die Darmfunktion verbessern und Entzündungen reduzieren.
Zusammen wirken diese drei Komponenten synergetisch, um die Darmgesundheit Ihres Hundes zu fördern, was zu einer gesünderen Haut und weniger Unannehmlichkeiten führt.
Wie helfen Präbiotika, Probiotika und Postbiotika bei Darm- und Hautproblemen Ihres Hundes
Juckreiz, Kratzen und Lecken an den Pfoten sind häufig Anzeichen für ein Ungleichgewicht im Darmmikrobiom Ihres Hundes, bei dem die schädlichen Bakterien gegenüber den nützlichen überwiegen. Dieses Ungleichgewicht kann zu Entzündungen führen, die sich auf die Haut Ihres Hundes auswirken.
Ein gesunder Darm ist wichtig für die allgemeine Gesundheit und beeinflusst die Verdauung, die Nährstoffaufnahme und die Immunfunktion. Wenn der Darm aus dem Gleichgewicht gerät, kann dies zu Hautproblemen und anderen langfristigen Gesundheitsproblemen führen.
Um das Gleichgewicht wiederherzustellen, ist eine Kombination aus Präbiotika, Probiotika und Postbiotika erforderlich.
1. Präbiotika ernähren die guten Bakterien im Darm und helfen ihnen, zu gedeihen und ein ausgewogenes Milieu zu schaffen.
2. Probiotika bringen lebende, nützliche Bakterien in den Darm, um die Darmgesundheit wiederherzustellen.
3. Postbiotika liefern sofort wirksame Verbindungen, die die Darmfunktion verbessern und Entzündungen reduzieren.
Zusammen wirken diese drei Komponenten synergetisch, um die Darmgesundheit Ihres Hundes zu fördern, was zu einer gesünderen Haut und weniger Unannehmlichkeiten führt.
Wie helfen Präbiotika, Probiotika und Postbiotika bei Darm- und Hautproblemen Ihres Hundes
Juckreiz, Kratzen und Lecken an den Pfoten sind häufig Anzeichen für ein Ungleichgewicht im Darmmikrobiom Ihres Hundes, bei dem die schädlichen Bakterien gegenüber den nützlichen überwiegen. Dieses Ungleichgewicht kann zu Entzündungen führen, die sich auf die Haut Ihres Hundes auswirken.
Ein gesunder Darm ist wichtig für die allgemeine Gesundheit und beeinflusst die Verdauung, die Nährstoffaufnahme und die Immunfunktion. Wenn der Darm aus dem Gleichgewicht gerät, kann dies zu Hautproblemen und anderen langfristigen Gesundheitsproblemen führen.
Um das Gleichgewicht wiederherzustellen, ist eine Kombination aus Präbiotika, Probiotika und Postbiotika erforderlich.
1. Präbiotika ernähren die guten Bakterien im Darm und helfen ihnen, zu gedeihen und ein ausgewogenes Milieu zu schaffen.
2. Probiotika bringen lebende, nützliche Bakterien in den Darm, um die Darmgesundheit wiederherzustellen.
3. Postbiotika liefern sofort wirksame Verbindungen, die die Darmfunktion verbessern und Entzündungen reduzieren.
Zusammen wirken diese drei Komponenten synergetisch, um die Darmgesundheit Ihres Hundes zu fördern, was zu einer gesünderen Haut und weniger Unannehmlichkeiten führt.
Come i prebiotici, i probiotici e i postbiotici aiutano a risolvere i problemi intestinali e cutanei del cane
Prurito, grattamento e leccamento delle zampe sono spesso segni di squilibri nel microbioma intestinale del cane, dove i batteri nocivi superano quelli benefici. Questo squilibrio può provocare infiammazioni che si manifestano sulla pelle del cane.
Un intestino sano è fondamentale per la salute generale, in quanto influisce sulla digestione, sull'assorbimento dei nutrienti e sulla funzione immunitaria. Quando l'intestino non è in equilibrio, può portare a problemi di pelle e ad altri problemi di salute a lungo termine.
Per ripristinare l'equilibrio, è essenziale una combinazione di prebiotici, probiotici e postbiotici.
Prebiotici nutrono i batteri buoni dell'intestino, aiutandoli a crescere e a creare un ambiente equilibrato.
Probiotici introducono batteri benefici vivi per ripristinare la salute intestinale.
Postbiotici forniscono composti benefici pronti all'uso che migliorano la funzione intestinale e riducono l'infiammazione.
Insieme, questi tre componenti agiscono in modo sinergico per migliorare la salute intestinale del cane, con conseguente miglioramento della pelle e riduzione del disagio.
Come i prebiotici, i probiotici e i postbiotici aiutano a risolvere i problemi intestinali e cutanei del cane
Prurito, grattamento e leccamento delle zampe sono spesso segni di squilibri nel microbioma intestinale del cane, dove i batteri nocivi superano quelli benefici. Questo squilibrio può provocare infiammazioni che si manifestano sulla pelle del cane.
Un intestino sano è fondamentale per la salute generale, in quanto influisce sulla digestione, sull'assorbimento dei nutrienti e sulla funzione immunitaria. Quando l'intestino non è in equilibrio, può portare a problemi di pelle e ad altri problemi di salute a lungo termine.
Per ripristinare l'equilibrio, è essenziale una combinazione di prebiotici, probiotici e postbiotici.
Prebiotici nutrono i batteri buoni dell'intestino, aiutandoli a crescere e a creare un ambiente equilibrato.
Probiotici introducono batteri benefici vivi per ripristinare la salute intestinale.
Postbiotici forniscono composti benefici pronti all'uso che migliorano la funzione intestinale e riducono l'infiammazione.
Insieme, questi tre componenti agiscono in modo sinergico per migliorare la salute intestinale del cane, con conseguente miglioramento della pelle e riduzione del disagio.
Come i prebiotici, i probiotici e i postbiotici aiutano a risolvere i problemi intestinali e cutanei del cane
Prurito, grattamento e leccamento delle zampe sono spesso segni di squilibri nel microbioma intestinale del cane, dove i batteri nocivi superano quelli benefici. Questo squilibrio può provocare infiammazioni che si manifestano sulla pelle del cane.
Un intestino sano è fondamentale per la salute generale, in quanto influisce sulla digestione, sull'assorbimento dei nutrienti e sulla funzione immunitaria. Quando l'intestino non è in equilibrio, può portare a problemi di pelle e ad altri problemi di salute a lungo termine.
Per ripristinare l'equilibrio, è essenziale una combinazione di prebiotici, probiotici e postbiotici.
Prebiotici nutrono i batteri buoni dell'intestino, aiutandoli a crescere e a creare un ambiente equilibrato.
Probiotici introducono batteri benefici vivi per ripristinare la salute intestinale.
Postbiotici forniscono composti benefici pronti all'uso che migliorano la funzione intestinale e riducono l'infiammazione.
Insieme, questi tre componenti agiscono in modo sinergico per migliorare la salute intestinale del cane, con conseguente miglioramento della pelle e riduzione del disagio.
How Prebiotics, Probiotics, and Postbiotics Help with Your Dog's Gut & Skin Issues
Itching, scratching, and paw licking are often signs of imbalances in your dog's gut microbiome, where harmful bacteria outnumber the beneficial ones. This imbalance can trigger inflammation that affects your dog's skin.
A healthy gut is crucial for overall health, affecting digestion, nutrient absorption, and immune function. When the gut is out of balance, it can lead to skin issues and other long-term health problems.
To restore balance, a combination of prebiotics, probiotics, and postbiotics is essential.
Prebiotics feed the good bacteria in the gut, helping them thrive and create a balanced environment.
Probiotics introduce live beneficial bacteria to restore gut health.
Postbiotics provide ready-to-use beneficial compounds that enhance gut function and reduce inflammation.
Together, these three components work synergistically to improve your dog's gut health, leading to healthier skin and reduced discomfort.
How Prebiotics, Probiotics, and Postbiotics Help with Your Dog's Gut & Skin Issues
Itching, scratching, and paw licking are often signs of imbalances in your dog's gut microbiome, where harmful bacteria outnumber the beneficial ones. This imbalance can trigger inflammation that affects your dog's skin.
A healthy gut is crucial for overall health, affecting digestion, nutrient absorption, and immune function. When the gut is out of balance, it can lead to skin issues and other long-term health problems.
To restore balance, a combination of prebiotics, probiotics, and postbiotics is essential.
Prebiotics feed the good bacteria in the gut, helping them thrive and create a balanced environment.
Probiotics introduce live beneficial bacteria to restore gut health.
Postbiotics provide ready-to-use beneficial compounds that enhance gut function and reduce inflammation.
Together, these three components work synergistically to improve your dog's gut health, leading to healthier skin and reduced discomfort.
How Prebiotics, Probiotics, and Postbiotics Help with Your Dog's Gut & Skin Issues
Itching, scratching, and paw licking are often signs of imbalances in your dog's gut microbiome, where harmful bacteria outnumber the beneficial ones. This imbalance can trigger inflammation that affects your dog's skin.
A healthy gut is crucial for overall health, affecting digestion, nutrient absorption, and immune function. When the gut is out of balance, it can lead to skin issues and other long-term health problems.
To restore balance, a combination of prebiotics, probiotics, and postbiotics is essential.
Prebiotics feed the good bacteria in the gut, helping them thrive and create a balanced environment.
Probiotics introduce live beneficial bacteria to restore gut health.
Postbiotics provide ready-to-use beneficial compounds that enhance gut function and reduce inflammation.
Together, these three components work synergistically to improve your dog's gut health, leading to healthier skin and reduced discomfort.
Potreste aver provato altri integratori o bocconcini, ma non hanno funzionato. Perché?
1. Un minimo di probiotici vivi
La maggior parte dei bocconcini per cani contiene pochissimi probiotici vivi, perché vengono distrutti dai processi di produzione aggressivi. gutQR è in polvere e garantisce al vostro cane i probiotici vivi necessari per sostenere la salute intestinale. Contiene 4,5 miliardi di UFC di probiotici vivi per porzione, mentre la maggior parte degli altri prodotti contiene meno di 1 miliardo di probiotici vivi.
2. Solo prebiotici e probiotici
La maggior parte degli integratori per la salute intestinale include solo prebiotici e probiotici, ma non postbiotici. I postbiotici sono i sottoprodotti dei batteri probiotici e agiscono immediatamente, mentre i probiotici richiedono tempo per creare un ambiente positivo per la flora intestinale. Ecco perché è meglio usarli entrambi.
3. Principi attivi generici non supportati da studi clinici
A differenza della maggior parte dei prodotti presenti sul mercato, gutQR utilizza solo gli ingredienti più avanzati e clinicamente validati, con i migliori studi a supporto. Gli ingredienti contenuti in gutQR sono stati dimostrati come i migliori della categoria.
4. Nessun supporto diretto al nutrimento della pelle
I prodotti per la salute intestinale sono in grado di supportare il microbioma intestinale del cane, ma non nutrono direttamente anche la pelle e il pelo. Fornendo un supporto diretto alla pelle e al pelo del cane con biotina, acido folico, polifenoli del mirtillo, omega e vitamine essenziali, gutQR risolve il problema in modo olistico.
5. Mancanza di supporto immunitario
Grattamento, infezioni da lievito, allergie stagionali e infiammazioni sono spesso il risultato di risposte inadeguate del sistema immunitario agli attacchi esterni e interni. gutQR rafforza il sistema immunitario del cane con una combinazione unica di colostro brevettato e del postbiotico EpiCor Pets, clinicamente testato.
6. Dosi inadeguate di sostanze attive
gutQR dosa tutti gli ingredienti attivi a livelli adeguati, in modo che funzionino davvero. È una formula pura al 100%, senza riempitivi, additivi o aromi artificiali, in cui ogni singolo ingrediente svolge un ruolo benefico per la salute del cane.
Potreste aver provato altri integratori o bocconcini, ma non hanno funzionato. Perché?
1. Un minimo di probiotici vivi
La maggior parte dei bocconcini per cani contiene pochissimi probiotici vivi, perché vengono distrutti dai processi di produzione aggressivi. gutQR è in polvere e garantisce al vostro cane i probiotici vivi necessari per sostenere la salute intestinale. Contiene 4,5 miliardi di UFC di probiotici vivi per porzione, mentre la maggior parte degli altri prodotti contiene meno di 1 miliardo di probiotici vivi.
2. Solo prebiotici e probiotici
La maggior parte degli integratori per la salute intestinale include solo prebiotici e probiotici, ma non postbiotici. I postbiotici sono i sottoprodotti dei batteri probiotici e agiscono immediatamente, mentre i probiotici richiedono tempo per creare un ambiente positivo per la flora intestinale. Ecco perché è meglio usarli entrambi.
3. Principi attivi generici non supportati da studi clinici
A differenza della maggior parte dei prodotti presenti sul mercato, gutQR utilizza solo gli ingredienti più avanzati e clinicamente validati, con i migliori studi a supporto. Gli ingredienti contenuti in gutQR sono stati dimostrati come i migliori della categoria.
4. Nessun supporto diretto al nutrimento della pelle
I prodotti per la salute intestinale sono in grado di supportare il microbioma intestinale del cane, ma non nutrono direttamente anche la pelle e il pelo. Fornendo un supporto diretto alla pelle e al pelo del cane con biotina, acido folico, polifenoli del mirtillo, omega e vitamine essenziali, gutQR risolve il problema in modo olistico.
5. Mancanza di supporto immunitario
Grattamento, infezioni da lievito, allergie stagionali e infiammazioni sono spesso il risultato di risposte inadeguate del sistema immunitario agli attacchi esterni e interni. gutQR rafforza il sistema immunitario del cane con una combinazione unica di colostro brevettato e del postbiotico EpiCor Pets, clinicamente testato.
6. Dosi inadeguate di sostanze attive
gutQR dosa tutti gli ingredienti attivi a livelli adeguati, in modo che funzionino davvero. È una formula pura al 100%, senza riempitivi, additivi o aromi artificiali, in cui ogni singolo ingrediente svolge un ruolo benefico per la salute del cane.
Potreste aver provato altri integratori o bocconcini, ma non hanno funzionato. Perché?
1. Un minimo di probiotici vivi
La maggior parte dei bocconcini per cani contiene pochissimi probiotici vivi, perché vengono distrutti dai processi di produzione aggressivi. gutQR è in polvere e garantisce al vostro cane i probiotici vivi necessari per sostenere la salute intestinale. Contiene 4,5 miliardi di UFC di probiotici vivi per porzione, mentre la maggior parte degli altri prodotti contiene meno di 1 miliardo di probiotici vivi.
2. Solo prebiotici e probiotici
La maggior parte degli integratori per la salute intestinale include solo prebiotici e probiotici, ma non postbiotici. I postbiotici sono i sottoprodotti dei batteri probiotici e agiscono immediatamente, mentre i probiotici richiedono tempo per creare un ambiente positivo per la flora intestinale. Ecco perché è meglio usarli entrambi.
3. Principi attivi generici non supportati da studi clinici
A differenza della maggior parte dei prodotti presenti sul mercato, gutQR utilizza solo gli ingredienti più avanzati e clinicamente validati, con i migliori studi a supporto. Gli ingredienti contenuti in gutQR sono stati dimostrati come i migliori della categoria.
4. Nessun supporto diretto al nutrimento della pelle
I prodotti per la salute intestinale sono in grado di supportare il microbioma intestinale del cane, ma non nutrono direttamente anche la pelle e il pelo. Fornendo un supporto diretto alla pelle e al pelo del cane con biotina, acido folico, polifenoli del mirtillo, omega e vitamine essenziali, gutQR risolve il problema in modo olistico.
5. Mancanza di supporto immunitario
Grattamento, infezioni da lievito, allergie stagionali e infiammazioni sono spesso il risultato di risposte inadeguate del sistema immunitario agli attacchi esterni e interni. gutQR rafforza il sistema immunitario del cane con una combinazione unica di colostro brevettato e del postbiotico EpiCor Pets, clinicamente testato.
6. Dosi inadeguate di sostanze attive
gutQR dosa tutti gli ingredienti attivi a livelli adeguati, in modo che funzionino davvero. È una formula pura al 100%, senza riempitivi, additivi o aromi artificiali, in cui ogni singolo ingrediente svolge un ruolo benefico per la salute del cane.
Vielleicht haben Sie schon andere Nahrungsergänzungsmittel oder Leckerlis ausprobiert, aber sie haben nicht geholfen. Sie fragen sich, warum?
1. Geringe Mengen lebender Probiotika
Die meisten Leckerlis für Hunde enthalten wenig oder gar keine lebenden Probiotika, da diese durch aggressive Produktionsprozesse abgetötet werden. gutQR ist in Pulverform und stellt sicher, dass Ihr Hund die lebenden Probiotika erhält, die er zur Unterstützung der Darmgesundheit benötigt. Es enthält laborgetestete und nachgewiesene 4,5 Milliarden KBE lebender Probiotika pro Portion, während die meisten anderen Produkte weniger als 1 Milliarde lebender Probiotika enthalten.
2. Nur Präbiotika und Probiotika
Die meisten Nahrungsergänzungsmittel für die Darmgesundheit enthalten nur Präbiotika und Probiotika, aber keine Postbiotika. Postbiotika sind Nebenprodukte probiotischer Bakterien und wirken sofort, während Probiotika Zeit brauchen, um eine positive Darmflora aufzubauen. Daher ist es am besten, beide zu verwenden.
3. Generische Wirkstoffe ohne klinische Studien
Im Gegensatz zu den meisten Produkten auf dem Markt verwendet gutQR nur die fortschrittlichsten und klinisch validierten Inhaltsstoffe mit den besten unterstützenden Studien. Die Inhaltsstoffe von gutQR sind nachweislich die besten ihrer Art.
4. Keine direkte Unterstützung der Hautpflege
Produkte für die Darmgesundheit unterstützen das Mikrobiom des Hundes, pflegen aber nicht direkt Haut und Fell. Durch die direkte Unterstützung von Haut und Fell Ihres Hundes mit Biotin, Folsäure, Heidelbeer-Polyphenolen, Omega-Fettsäuren und essentiellen Vitaminen löst gutQR das Problem ganzheitlich.
5. Mangelnde Unterstützung des Immunsystems
Juckreiz, Hefepilzinfektionen, saisonale Allergien und Entzündungen sind oft die Folge einer unzureichenden Reaktion des Immunsystems auf äußere und innere Angriffe. gutQR stärkt das Immunsystem Ihres Hundes mit einer einzigartigen Kombination aus patentiertem Kolostrum und dem klinisch bewährten Postbiotikum EpiCor Pets.
6. Unzureichende Dosierung der Wirkstoffe
gutQR dosiert alle Wirkstoffe in der richtigen Menge, damit sie auch wirklich wirken. Es ist eine 100 % reine Formel ohne Füllstoffe, Zusatzstoffe oder künstliche Aromen, bei der jeder einzelne Inhaltsstoff für die Gesundheit Ihres Hundes wichtig ist.
Vielleicht haben Sie schon andere Nahrungsergänzungsmittel oder Leckerlis ausprobiert, aber sie haben nicht geholfen. Sie fragen sich, warum?
1. Geringe Mengen lebender Probiotika
Die meisten Leckerlis für Hunde enthalten wenig oder gar keine lebenden Probiotika, da diese durch aggressive Produktionsprozesse abgetötet werden. gutQR ist in Pulverform und stellt sicher, dass Ihr Hund die lebenden Probiotika erhält, die er zur Unterstützung der Darmgesundheit benötigt. Es enthält laborgetestete und nachgewiesene 4,5 Milliarden KBE lebender Probiotika pro Portion, während die meisten anderen Produkte weniger als 1 Milliarde lebender Probiotika enthalten.
2. Nur Präbiotika und Probiotika
Die meisten Nahrungsergänzungsmittel für die Darmgesundheit enthalten nur Präbiotika und Probiotika, aber keine Postbiotika. Postbiotika sind Nebenprodukte probiotischer Bakterien und wirken sofort, während Probiotika Zeit brauchen, um eine positive Darmflora aufzubauen. Daher ist es am besten, beide zu verwenden.
3. Generische Wirkstoffe ohne klinische Studien
Im Gegensatz zu den meisten Produkten auf dem Markt verwendet gutQR nur die fortschrittlichsten und klinisch validierten Inhaltsstoffe mit den besten unterstützenden Studien. Die Inhaltsstoffe von gutQR sind nachweislich die besten ihrer Art.
4. Keine direkte Unterstützung der Hautpflege
Produkte für die Darmgesundheit unterstützen das Mikrobiom des Hundes, pflegen aber nicht direkt Haut und Fell. Durch die direkte Unterstützung von Haut und Fell Ihres Hundes mit Biotin, Folsäure, Heidelbeer-Polyphenolen, Omega-Fettsäuren und essentiellen Vitaminen löst gutQR das Problem ganzheitlich.
5. Mangelnde Unterstützung des Immunsystems
Juckreiz, Hefepilzinfektionen, saisonale Allergien und Entzündungen sind oft die Folge einer unzureichenden Reaktion des Immunsystems auf äußere und innere Angriffe. gutQR stärkt das Immunsystem Ihres Hundes mit einer einzigartigen Kombination aus patentiertem Kolostrum und dem klinisch bewährten Postbiotikum EpiCor Pets.
6. Unzureichende Dosierung der Wirkstoffe
gutQR dosiert alle Wirkstoffe in der richtigen Menge, damit sie auch wirklich wirken. Es ist eine 100 % reine Formel ohne Füllstoffe, Zusatzstoffe oder künstliche Aromen, bei der jeder einzelne Inhaltsstoff für die Gesundheit Ihres Hundes wichtig ist.
Vielleicht haben Sie schon andere Nahrungsergänzungsmittel oder Leckerlis ausprobiert, aber sie haben nicht geholfen. Sie fragen sich, warum?
1. Geringe Mengen lebender Probiotika
Die meisten Leckerlis für Hunde enthalten wenig oder gar keine lebenden Probiotika, da diese durch aggressive Produktionsprozesse abgetötet werden. gutQR ist in Pulverform und stellt sicher, dass Ihr Hund die lebenden Probiotika erhält, die er zur Unterstützung der Darmgesundheit benötigt. Es enthält laborgetestete und nachgewiesene 4,5 Milliarden KBE lebender Probiotika pro Portion, während die meisten anderen Produkte weniger als 1 Milliarde lebender Probiotika enthalten.
2. Nur Präbiotika und Probiotika
Die meisten Nahrungsergänzungsmittel für die Darmgesundheit enthalten nur Präbiotika und Probiotika, aber keine Postbiotika. Postbiotika sind Nebenprodukte probiotischer Bakterien und wirken sofort, während Probiotika Zeit brauchen, um eine positive Darmflora aufzubauen. Daher ist es am besten, beide zu verwenden.
3. Generische Wirkstoffe ohne klinische Studien
Im Gegensatz zu den meisten Produkten auf dem Markt verwendet gutQR nur die fortschrittlichsten und klinisch validierten Inhaltsstoffe mit den besten unterstützenden Studien. Die Inhaltsstoffe von gutQR sind nachweislich die besten ihrer Art.
4. Keine direkte Unterstützung der Hautpflege
Produkte für die Darmgesundheit unterstützen das Mikrobiom des Hundes, pflegen aber nicht direkt Haut und Fell. Durch die direkte Unterstützung von Haut und Fell Ihres Hundes mit Biotin, Folsäure, Heidelbeer-Polyphenolen, Omega-Fettsäuren und essentiellen Vitaminen löst gutQR das Problem ganzheitlich.
5. Mangelnde Unterstützung des Immunsystems
Juckreiz, Hefepilzinfektionen, saisonale Allergien und Entzündungen sind oft die Folge einer unzureichenden Reaktion des Immunsystems auf äußere und innere Angriffe. gutQR stärkt das Immunsystem Ihres Hundes mit einer einzigartigen Kombination aus patentiertem Kolostrum und dem klinisch bewährten Postbiotikum EpiCor Pets.
6. Unzureichende Dosierung der Wirkstoffe
gutQR dosiert alle Wirkstoffe in der richtigen Menge, damit sie auch wirklich wirken. Es ist eine 100 % reine Formel ohne Füllstoffe, Zusatzstoffe oder künstliche Aromen, bei der jeder einzelne Inhaltsstoff für die Gesundheit Ihres Hundes wichtig ist.
You might have tried other supplements or treats, but they didn't work. Why?
1. Minimum Live Probiotics
Most dog treats contain little to no live probiotics, because they're killed by the aggressive production processes. gutQR is in powder form, assuring that your dog gets the live probiotics needed to support their gut health. It contains lab tested & proven 4,5 Billion CFU live probiotics per serving, while most other products contain less than 1 Billion live probiotics.
2. Only Prebiotics and Probiotics
Most gut health supplements only include prebiotics and probiotics, but no postbiotics. Postbiotics are the byproducts of probiotic bacteria and work immediately, while probiotics take time to build up a positive gut flora environment. That's why it's best to use both.
3. Generic Active Ingredients Not Supported by Clinical Studies
Opposite to most products in the market, gutQR uses only the most advanced and clinically validated ingredients with the best supporting studies. The ingredients that go into gutQR are proven to be best-in-breed.
4. No Direct Skin Nourishment Support
Gut health products work to support your dog's gut microbiome, but don't directly also nourish their skin & coat. By providing direct support to your dog's skin & coat with biotin, folic acid, blueberry polyphenols, omegas and essential vitamins, gutQR solves the problem holistically.
5. Lacking Immunity Support
Scratching, yeast infections, seasonal allergies and inflammations are often the result of inadequate immune system responses to external and internal attacks. gutQR builds up your dog's immune system with a unique combination of patented colostrum and clinically proven EpiCor Pets postbiotic.
6. Inadequate Active Ingredients Doses
gutQR doses all active ingredients to appropriate levels so that they actually work. It's a 100% clean formula with no fillers, additives or artificial flavors where every single ingredient plays a beneficial role in your dog's health.
You might have tried other supplements or treats, but they didn't work. Why?
1. Minimum Live Probiotics
Most dog treats contain little to no live probiotics, because they're killed by the aggressive production processes. gutQR is in powder form, assuring that your dog gets the live probiotics needed to support their gut health. It contains lab tested & proven 4,5 Billion CFU live probiotics per serving, while most other products contain less than 1 Billion live probiotics.
2. Only Prebiotics and Probiotics
Most gut health supplements only include prebiotics and probiotics, but no postbiotics. Postbiotics are the byproducts of probiotic bacteria and work immediately, while probiotics take time to build up a positive gut flora environment. That's why it's best to use both.
3. Generic Active Ingredients Not Supported by Clinical Studies
Opposite to most products in the market, gutQR uses only the most advanced and clinically validated ingredients with the best supporting studies. The ingredients that go into gutQR are proven to be best-in-breed.
4. No Direct Skin Nourishment Support
Gut health products work to support your dog's gut microbiome, but don't directly also nourish their skin & coat. By providing direct support to your dog's skin & coat with biotin, folic acid, blueberry polyphenols, omegas and essential vitamins, gutQR solves the problem holistically.
5. Lacking Immunity Support
Scratching, yeast infections, seasonal allergies and inflammations are often the result of inadequate immune system responses to external and internal attacks. gutQR builds up your dog's immune system with a unique combination of patented colostrum and clinically proven EpiCor Pets postbiotic.
6. Inadequate Active Ingredients Doses
gutQR doses all active ingredients to appropriate levels so that they actually work. It's a 100% clean formula with no fillers, additives or artificial flavors where every single ingredient plays a beneficial role in your dog's health.
You might have tried other supplements or treats, but they didn't work. Why?
1. Minimum Live Probiotics
Most dog treats contain little to no live probiotics, because they're killed by the aggressive production processes. gutQR is in powder form, assuring that your dog gets the live probiotics needed to support their gut health. It contains lab tested & proven 4,5 Billion CFU live probiotics per serving, while most other products contain less than 1 Billion live probiotics.
2. Only Prebiotics and Probiotics
Most gut health supplements only include prebiotics and probiotics, but no postbiotics. Postbiotics are the byproducts of probiotic bacteria and work immediately, while probiotics take time to build up a positive gut flora environment. That's why it's best to use both.
3. Generic Active Ingredients Not Supported by Clinical Studies
Opposite to most products in the market, gutQR uses only the most advanced and clinically validated ingredients with the best supporting studies. The ingredients that go into gutQR are proven to be best-in-breed.
4. No Direct Skin Nourishment Support
Gut health products work to support your dog's gut microbiome, but don't directly also nourish their skin & coat. By providing direct support to your dog's skin & coat with biotin, folic acid, blueberry polyphenols, omegas and essential vitamins, gutQR solves the problem holistically.
5. Lacking Immunity Support
Scratching, yeast infections, seasonal allergies and inflammations are often the result of inadequate immune system responses to external and internal attacks. gutQR builds up your dog's immune system with a unique combination of patented colostrum and clinically proven EpiCor Pets postbiotic.
6. Inadequate Active Ingredients Doses
gutQR doses all active ingredients to appropriate levels so that they actually work. It's a 100% clean formula with no fillers, additives or artificial flavors where every single ingredient plays a beneficial role in your dog's health.
Come somministrare il gutQR al vostro cane? È facile!
Ecco le opzioni...
Cospargere sul cibo
È sufficiente cospargerlo sul cibo del cane e mescolarlo delicatamente. Si può anche mescolarlo al cibo umido poco prima del consumo.
Mescolare con un po' d'acqua per il cibo secco
Se al cane non piace che venga cosparso sopra il cibo secco, è sufficiente mescolarlo con un po' d'acqua e poi unirlo alle crocchette.
Somministrare direttamente
Alcuni cani adorano il sapore del lievito, quindi potete anche provare a somministrarlo direttamente.
Siete ancora preoccupati che il vostro cane non lo mangi?
Nessun problema! Provatelo e se il cane non lo gradisce fatecelo sapere e vi rimborseremo completamente.
Come somministrare il gutQR al vostro cane? È facile!
Ecco le opzioni...
Cospargere sul cibo
È sufficiente cospargerlo sul cibo del cane e mescolarlo delicatamente. Si può anche mescolarlo al cibo umido poco prima del consumo.
Mescolare con un po' d'acqua per il cibo secco
Se al cane non piace che venga cosparso sopra il cibo secco, è sufficiente mescolarlo con un po' d'acqua e poi unirlo alle crocchette.
Somministrare direttamente
Alcuni cani adorano il sapore del lievito, quindi potete anche provare a somministrarlo direttamente.
Siete ancora preoccupati che il vostro cane non lo mangi?
Nessun problema! Provatelo e se il cane non lo gradisce fatecelo sapere e vi rimborseremo completamente.
Come somministrare il gutQR al vostro cane? È facile!
Ecco le opzioni...
Cospargere sul cibo
È sufficiente cospargerlo sul cibo del cane e mescolarlo delicatamente. Si può anche mescolarlo al cibo umido poco prima del consumo.
Mescolare con un po' d'acqua per il cibo secco
Se al cane non piace che venga cosparso sopra il cibo secco, è sufficiente mescolarlo con un po' d'acqua e poi unirlo alle crocchette.
Somministrare direttamente
Alcuni cani adorano il sapore del lievito, quindi potete anche provare a somministrarlo direttamente.
Siete ancora preoccupati che il vostro cane non lo mangi?
Nessun problema! Provatelo e se il cane non lo gradisce fatecelo sapere e vi rimborseremo completamente.
Wie füttern Sie Ihren Hund gutQR? Ganz einfach!
Hier sind Ihre Möglichkeiten ...
Über das Futter streuen
Streuen Sie es einfach über das Trockenfutter Ihres Hundes und mischen Sie es leicht unter. Sie können es auch kurz vor dem Verzehr unter das Nassfutter mischen.
Trockenfutter mit etwas Wasser anrühren
Wenn Ihr Hund es nicht mag, wenn Sie es über das Trockenfutter streuen, mischen Sie es einfach mit etwas Wasser und mischen Sie es unter das Trockenfutter.
Direkt füttern
Manche Hunde lieben einfach den Geschmack von Hefe, deshalb kann man sie auch direkt füttern.
Immer noch besorgt, dass Ihr Hund es nicht frisst?
Kein Problem! Probieren Sie es aus, und wenn Ihr Hund es nicht mag, lassen Sie es uns wissen, und wir erstatten Ihnen den vollen Kaufpreis.
Wie füttern Sie Ihren Hund gutQR? Ganz einfach!
Hier sind Ihre Möglichkeiten ...
Über das Futter streuen
Streuen Sie es einfach über das Trockenfutter Ihres Hundes und mischen Sie es leicht unter. Sie können es auch kurz vor dem Verzehr unter das Nassfutter mischen.
Trockenfutter mit etwas Wasser anrühren
Wenn Ihr Hund es nicht mag, wenn Sie es über das Trockenfutter streuen, mischen Sie es einfach mit etwas Wasser und mischen Sie es unter das Trockenfutter.
Direkt füttern
Manche Hunde lieben einfach den Geschmack von Hefe, deshalb kann man sie auch direkt füttern.
Immer noch besorgt, dass Ihr Hund es nicht frisst?
Kein Problem! Probieren Sie es aus, und wenn Ihr Hund es nicht mag, lassen Sie es uns wissen, und wir erstatten Ihnen den vollen Kaufpreis.
Wie füttern Sie Ihren Hund gutQR? Ganz einfach!
Hier sind Ihre Möglichkeiten ...
Über das Futter streuen
Streuen Sie es einfach über das Trockenfutter Ihres Hundes und mischen Sie es leicht unter. Sie können es auch kurz vor dem Verzehr unter das Nassfutter mischen.
Trockenfutter mit etwas Wasser anrühren
Wenn Ihr Hund es nicht mag, wenn Sie es über das Trockenfutter streuen, mischen Sie es einfach mit etwas Wasser und mischen Sie es unter das Trockenfutter.
Direkt füttern
Manche Hunde lieben einfach den Geschmack von Hefe, deshalb kann man sie auch direkt füttern.
Immer noch besorgt, dass Ihr Hund es nicht frisst?
Kein Problem! Probieren Sie es aus, und wenn Ihr Hund es nicht mag, lassen Sie es uns wissen, und wir erstatten Ihnen den vollen Kaufpreis.
How to feed gutQR to your dog? It's easy!
Here are your options …
Spinkle on top of food
Simply sprinkle it on top of the your dog's food and gently mix it in. You can also mix it into wet food shortly before consumption.
Mix with a bit of water for dry food
If your dog doesn't like ti sprinkled on top of dry food, just mix it with a bit of water and then mix it into kibble.
Feed it directly
Some dogs just adore the flavor of yeast, so you can also try feeding it directly.
Still concerned your dog won't eat it?
No problem! Just try it and if the dog doesn't like it let us know and we'll refund you in full.
How to feed gutQR to your dog? It's easy!
Here are your options …
Spinkle on top of food
Simply sprinkle it on top of the your dog's food and gently mix it in. You can also mix it into wet food shortly before consumption.
Mix with a bit of water for dry food
If your dog doesn't like ti sprinkled on top of dry food, just mix it with a bit of water and then mix it into kibble.
Feed it directly
Some dogs just adore the flavor of yeast, so you can also try feeding it directly.
Still concerned your dog won't eat it?
No problem! Just try it and if the dog doesn't like it let us know and we'll refund you in full.
How to feed gutQR to your dog? It's easy!
Here are your options …
Spinkle on top of food
Simply sprinkle it on top of the your dog's food and gently mix it in. You can also mix it into wet food shortly before consumption.
Mix with a bit of water for dry food
If your dog doesn't like ti sprinkled on top of dry food, just mix it with a bit of water and then mix it into kibble.
Feed it directly
Some dogs just adore the flavor of yeast, so you can also try feeding it directly.
Still concerned your dog won't eat it?
No problem! Just try it and if the dog doesn't like it let us know and we'll refund you in full.
gutQR ist ein Ergänzungsfuttermittel in Pulverform
Pulver ist besser für Ihren Hund!
100% reine Rezeptur ohne Füllstoffe, Zusatzstoffe oder künstliche Aromen. Jede einzelne Zutat in gutQR trägt zur Gesundheit Ihres Hundes bei. 100% nur Inhaltsstoffe, die Ihrem Hund helfen.
Erhaltung lebender Probiotika. Aggressive Herstellungsverfahren von Hundesnacks töten die meisten lebenden Probiotika ab. Durch die Zufuhr von Probiotika in Pulverform bleiben sie am Leben.
Ermöglicht eine hochwirksame Rezeptur. Nur in Pulverform ist es möglich, eine so vollständige und hochwirksame Formel mit diesen starken Inhaltsstoffen zu liefern.
Kostet weniger in der Herstellung. Diese Ersparnis geben wir an Sie weiter. Sie zahlen nur für die aktiven Inhaltsstoffe und nicht für die Füllstoffe", die nichts für die Gesundheit Ihres Hundes tun.
Schmeckt trotzdem fantastisch! Hunde lieben die 100% natürliche Hefe von TechnoYEAST, die für einen tollen Geschmack sorgt.
Was, wenn Ihr Hund es nicht mag? Kein Problem! Wir erstatten Ihnen den vollen Kaufpreis zurück, Sie gehen also kein Risiko ein.
gutQR ist ein Ergänzungsfuttermittel in Pulverform
Pulver ist besser für Ihren Hund!
100% reine Rezeptur ohne Füllstoffe, Zusatzstoffe oder künstliche Aromen. Jede einzelne Zutat in gutQR trägt zur Gesundheit Ihres Hundes bei. 100% nur Inhaltsstoffe, die Ihrem Hund helfen.
Erhaltung lebender Probiotika. Aggressive Herstellungsverfahren von Hundesnacks töten die meisten lebenden Probiotika ab. Durch die Zufuhr von Probiotika in Pulverform bleiben sie am Leben.
Ermöglicht eine hochwirksame Rezeptur. Nur in Pulverform ist es möglich, eine so vollständige und hochwirksame Formel mit diesen starken Inhaltsstoffen zu liefern.
Kostet weniger in der Herstellung. Diese Ersparnis geben wir an Sie weiter. Sie zahlen nur für die aktiven Inhaltsstoffe und nicht für die Füllstoffe", die nichts für die Gesundheit Ihres Hundes tun.
Schmeckt trotzdem fantastisch! Hunde lieben die 100% natürliche Hefe von TechnoYEAST, die für einen tollen Geschmack sorgt.
Was, wenn Ihr Hund es nicht mag? Kein Problem! Wir erstatten Ihnen den vollen Kaufpreis zurück, Sie gehen also kein Risiko ein.
gutQR ist ein Ergänzungsfuttermittel in Pulverform
Pulver ist besser für Ihren Hund!
100% reine Rezeptur ohne Füllstoffe, Zusatzstoffe oder künstliche Aromen. Jede einzelne Zutat in gutQR trägt zur Gesundheit Ihres Hundes bei. 100% nur Inhaltsstoffe, die Ihrem Hund helfen.
Erhaltung lebender Probiotika. Aggressive Herstellungsverfahren von Hundesnacks töten die meisten lebenden Probiotika ab. Durch die Zufuhr von Probiotika in Pulverform bleiben sie am Leben.
Ermöglicht eine hochwirksame Rezeptur. Nur in Pulverform ist es möglich, eine so vollständige und hochwirksame Formel mit diesen starken Inhaltsstoffen zu liefern.
Kostet weniger in der Herstellung. Diese Ersparnis geben wir an Sie weiter. Sie zahlen nur für die aktiven Inhaltsstoffe und nicht für die Füllstoffe", die nichts für die Gesundheit Ihres Hundes tun.
Schmeckt trotzdem fantastisch! Hunde lieben die 100% natürliche Hefe von TechnoYEAST, die für einen tollen Geschmack sorgt.
Was, wenn Ihr Hund es nicht mag? Kein Problem! Wir erstatten Ihnen den vollen Kaufpreis zurück, Sie gehen also kein Risiko ein.
gutQR è un integratore in polvere
La polvere è meglio per il vostro cane!
Formula pura al 100%, senza riempitivi, additivi o aromi artificiali. Ogni singolo ingrediente di gutQR svolge un ruolo benefico per la salute. 100% solo ingredienti per aiutare il tuo cane.
Mantiene vivi i probiotici. I processi di produzione dei bocconcini per cani distruggono la maggior parte dei probiotici vivi. La somministrazione di probiotici in polvere li mantiene in vita.
Permette una formula ad alta potenza. Solo una polvere può essere utilizzata per fornire una formula completa ad alta potenza con questi potenti ingredienti.
La produzione costa meno. Il risparmio viene trasferito a voi. Pagate solo gli ingredienti attivi e non i "riempitivi" che non fanno nulla per la salute del vostro cane.
Il sapore è ancora sorprendente! I cani amano il lievito TechnoYEAST, naturale al 100%, che rende il sapore straordinario.
E se al vostro cane non piacesse? Nessun problema! Vi rimborseremo interamente, quindi non c'è alcun rischio.
gutQR è un integratore in polvere
La polvere è meglio per il vostro cane!
Formula pura al 100%, senza riempitivi, additivi o aromi artificiali. Ogni singolo ingrediente di gutQR svolge un ruolo benefico per la salute. 100% solo ingredienti per aiutare il tuo cane.
Mantiene vivi i probiotici. I processi di produzione dei bocconcini per cani distruggono la maggior parte dei probiotici vivi. La somministrazione di probiotici in polvere li mantiene in vita.
Permette una formula ad alta potenza. Solo una polvere può essere utilizzata per fornire una formula completa ad alta potenza con questi potenti ingredienti.
La produzione costa meno. Il risparmio viene trasferito a voi. Pagate solo gli ingredienti attivi e non i "riempitivi" che non fanno nulla per la salute del vostro cane.
Il sapore è ancora sorprendente! I cani amano il lievito TechnoYEAST, naturale al 100%, che rende il sapore straordinario.
E se al vostro cane non piacesse? Nessun problema! Vi rimborseremo interamente, quindi non c'è alcun rischio.
gutQR è un integratore in polvere
La polvere è meglio per il vostro cane!
Formula pura al 100%, senza riempitivi, additivi o aromi artificiali. Ogni singolo ingrediente di gutQR svolge un ruolo benefico per la salute. 100% solo ingredienti per aiutare il tuo cane.
Mantiene vivi i probiotici. I processi di produzione dei bocconcini per cani distruggono la maggior parte dei probiotici vivi. La somministrazione di probiotici in polvere li mantiene in vita.
Permette una formula ad alta potenza. Solo una polvere può essere utilizzata per fornire una formula completa ad alta potenza con questi potenti ingredienti.
La produzione costa meno. Il risparmio viene trasferito a voi. Pagate solo gli ingredienti attivi e non i "riempitivi" che non fanno nulla per la salute del vostro cane.
Il sapore è ancora sorprendente! I cani amano il lievito TechnoYEAST, naturale al 100%, che rende il sapore straordinario.
E se al vostro cane non piacesse? Nessun problema! Vi rimborseremo interamente, quindi non c'è alcun rischio.
gutQR is a Powder Supplement
A powder is better for your dog!
100% clean formula with no fillers, additives or artificial flavors. Every single ingredient in gutQR plays a beneficial health role. 100% only ingredients to help your dog.
It keeps probiotics alive. Aggressive dog treat production processes kill the majority of live probiotics. Delivering probiotics in powder form keeps them alive.
Allowing for a high potency formula. Only a powder can be used to deliver such a complete high potency formula with these powerful ingredients.
It costs you less, for a better result. We pass on the savings to you. You only pay for the active ingredients, and not the "fillers" that do nothing for your dog's health.
It still tastes amazing! Dogs love the 100% natural TechnoYEAST yeast, which makes it taste amazing.
What if your dog doesn't like it? No problem! We'll refund you in full, so there's absolutely no risk.
gutQR is a Powder Supplement
A powder is better for your dog!
100% clean formula with no fillers, additives or artificial flavors. Every single ingredient in gutQR plays a beneficial health role. 100% only ingredients to help your dog.
It keeps probiotics alive. Aggressive dog treat production processes kill the majority of live probiotics. Delivering probiotics in powder form keeps them alive.
Allowing for a high potency formula. Only a powder can be used to deliver such a complete high potency formula with these powerful ingredients.
It costs you less, for a better result. We pass on the savings to you. You only pay for the active ingredients, and not the "fillers" that do nothing for your dog's health.
It still tastes amazing! Dogs love the 100% natural TechnoYEAST yeast, which makes it taste amazing.
What if your dog doesn't like it? No problem! We'll refund you in full, so there's absolutely no risk.
gutQR is a Powder Supplement
A powder is better for your dog!
100% clean formula with no fillers, additives or artificial flavors. Every single ingredient in gutQR plays a beneficial health role. 100% only ingredients to help your dog.
It keeps probiotics alive. Aggressive dog treat production processes kill the majority of live probiotics. Delivering probiotics in powder form keeps them alive.
Allowing for a high potency formula. Only a powder can be used to deliver such a complete high potency formula with these powerful ingredients.
It costs you less, for a better result. We pass on the savings to you. You only pay for the active ingredients, and not the "fillers" that do nothing for your dog's health.
It still tastes amazing! Dogs love the 100% natural TechnoYEAST yeast, which makes it taste amazing.
What if your dog doesn't like it? No problem! We'll refund you in full, so there's absolutely no risk.
Composizione
Manzo (60%), Patata dolce, Glicerolo vegetale, Patata, Omega 3, Lievito di birra, Alga ascophyllum nodosum, Acido ialuronico, Zucca, Aceto di sidro di mele, Olio di semi di lino
Additivi sensoriali
Curcuma
Additivi nutrizionali
Vitamina C, Vitamina E, Biotina
Additivi zootecnici
Cellule inattivate di Bifidobacterium longum (ES1®) 1,25 x 10¹⁰ CFU/kg
Componenti analitici
Proteina grezza 16,6%, Grasso grezzo 18,33%, Cenere grezza 4,21%, Fibra grezza 2,9%, Umidità 22,42%
Composizione
Manzo (60%), Patata dolce, Glicerolo vegetale, Patata, Omega 3, Lievito di birra, Alga ascophyllum nodosum, Acido ialuronico, Zucca, Aceto di sidro di mele, Olio di semi di lino
Additivi sensoriali
Curcuma
Additivi nutrizionali
Vitamina C, Vitamina E, Biotina
Additivi zootecnici
Cellule inattivate di Bifidobacterium longum (ES1®) 1,25 x 10¹⁰ CFU/kg
Componenti analitici
Proteina grezza 16,6%, Grasso grezzo 18,33%, Cenere grezza 4,21%, Fibra grezza 2,9%, Umidità 22,42%
Composizione
Manzo (60%), Patata dolce, Glicerolo vegetale, Patata, Omega 3, Lievito di birra, Alga ascophyllum nodosum, Acido ialuronico, Zucca, Aceto di sidro di mele, Olio di semi di lino
Additivi sensoriali
Curcuma
Additivi nutrizionali
Vitamina C, Vitamina E, Biotina
Additivi zootecnici
Cellule inattivate di Bifidobacterium longum (ES1®) 1,25 x 10¹⁰ CFU/kg
Componenti analitici
Proteina grezza 16,6%, Grasso grezzo 18,33%, Cenere grezza 4,21%, Fibra grezza 2,9%, Umidità 22,42%
Zusamemnsetzung
Rindfleisch (60%), Süßkartoffel, pflanzliches Glycerin, Kartoffel, Omega 3, Bierhefe, Seetang Ascophyllum Nodosum, Hyaluronsäure, Kürbis, Apfelessig, Leinöl
Sensorische Zusätze
Kurkuma
Zootechnische Zusatzstoffe
Inaktivierte Zellen von Bifidobacterium longum (ES1®) 1,25 x 10¹⁰ KBE/kg
Ernährungsphysiologische Zusatzstoffe
Vitamin C, Vitamin E, Biotin
Analytische Bestandteile
Rohprotein 16,6%, Rohfett 18,33%, Rohasche 4,21%,Rohfaser 2,9%, Feuchtigkeit 22,42%
Zusamemnsetzung
Rindfleisch (60%), Süßkartoffel, pflanzliches Glycerin, Kartoffel, Omega 3, Bierhefe, Seetang Ascophyllum Nodosum, Hyaluronsäure, Kürbis, Apfelessig, Leinöl
Sensorische Zusätze
Kurkuma
Zootechnische Zusatzstoffe
Inaktivierte Zellen von Bifidobacterium longum (ES1®) 1,25 x 10¹⁰ KBE/kg
Ernährungsphysiologische Zusatzstoffe
Vitamin C, Vitamin E, Biotin
Analytische Bestandteile
Rohprotein 16,6%, Rohfett 18,33%, Rohasche 4,21%,Rohfaser 2,9%, Feuchtigkeit 22,42%
Zusamemnsetzung
Rindfleisch (60%), Süßkartoffel, pflanzliches Glycerin, Kartoffel, Omega 3, Bierhefe, Seetang Ascophyllum Nodosum, Hyaluronsäure, Kürbis, Apfelessig, Leinöl
Sensorische Zusätze
Kurkuma
Zootechnische Zusatzstoffe
Inaktivierte Zellen von Bifidobacterium longum (ES1®) 1,25 x 10¹⁰ KBE/kg
Ernährungsphysiologische Zusatzstoffe
Vitamin C, Vitamin E, Biotin
Analytische Bestandteile
Rohprotein 16,6%, Rohfett 18,33%, Rohasche 4,21%,Rohfaser 2,9%, Feuchtigkeit 22,42%
Composition
Beef (60%), Sweet potato, Vegetable glycerol, Potato, Omega 3, Brewers Yeast, Seaweed ascophyllum nodosum, Hyalouronic Acid, Pumpkin, Apple cider vinegar, Linseed oil
Sensory Additives
Turmeric
Zootechnical Additives
Inactivated cells from Bifidobacterium longum (ES1®) 1.25 x 10¹⁰ CFU/kg
Nutritional Additives
Vitamin C, Vitamin E, Biotin
Analytical Constituents
Crude Protein 16,6%, Crude Fat 18,33%, Crude Ash 4,21%, Crude Fibre 2,9%, Moisture 22,42%
Composition
Beef (60%), Sweet potato, Vegetable glycerol, Potato, Omega 3, Brewers Yeast, Seaweed ascophyllum nodosum, Hyalouronic Acid, Pumpkin, Apple cider vinegar, Linseed oil
Sensory Additives
Turmeric
Zootechnical Additives
Inactivated cells from Bifidobacterium longum (ES1®) 1.25 x 10¹⁰ CFU/kg
Nutritional Additives
Vitamin C, Vitamin E, Biotin
Analytical Constituents
Crude Protein 16,6%, Crude Fat 18,33%, Crude Ash 4,21%, Crude Fibre 2,9%, Moisture 22,42%
Composition
Beef (60%), Sweet potato, Vegetable glycerol, Potato, Omega 3, Brewers Yeast, Seaweed ascophyllum nodosum, Hyalouronic Acid, Pumpkin, Apple cider vinegar, Linseed oil
Sensory Additives
Turmeric
Zootechnical Additives
Inactivated cells from Bifidobacterium longum (ES1®) 1.25 x 10¹⁰ CFU/kg
Nutritional Additives
Vitamin C, Vitamin E, Biotin
Analytical Constituents
Crude Protein 16,6%, Crude Fat 18,33%, Crude Ash 4,21%, Crude Fibre 2,9%, Moisture 22,42%
Health Issue | Safe to Use? | Additional Info |
| Any dog breed | Yes | Skin & Coat Hero is suitable for all dog breeds |
| Any dog size | Yes | Skin & Coat Hero is suitable for all dog sizes |
| Puppies (under 6 months) | No | Not suitable for dogs under 6 months |
| Puppies (above 6 months) | Yes | Suitable for dogs over 6 months |
| Portosys-temic Shunt | Yes | Adjust diet to account for salmon content. |
| Pancreatitis | Yes | Skin & Coat Hero contains 18,33% fat. Ensure total fat content from food does not exceed 15%. |
| Dysbiosis | Yes | Skin & Coat Hero supports gut microbiome health. |
| Pancreatic Liver Failure or other liver problems | Yes | No ingredients in Skin & Coat Hero harm the liver. |
| Food Allergies/ Dermatitis | Yes | Skin & Coat Hero is hypoallergenic and doesn't contain any allergens. |
| Leishman-iasis | Yes | Use Skin & Coat Hero regularly for long-term immune support. |
| Chronic Gastritis | Yes | Skin & Coat Hero supports your dog's digestive health. Do review the ingredient list to make sure your dog has no specific intolerances to Skin & Coat Hero ingredients. |
| Chronic Enteritis | Yes | Supports gut health and helps with digestion issues. |
| Pancreatic Insufficiency | Yes | Helps gut flora. Use regularly for long-term health. |
| Malassezia | Yes | Supports immunity and gut health. |
Health Issue | Safe to Use? | Additional Info |
| Any dog breed | Yes | Skin & Coat Hero is suitable for all dog breeds |
| Any dog size | Yes | Skin & Coat Hero is suitable for all dog sizes |
| Puppies (under 6 months) | No | Not suitable for dogs under 6 months |
| Puppies (above 6 months) | Yes | Suitable for dogs over 6 months |
| Portosys-temic Shunt | Yes | Adjust diet to account for salmon content. |
| Pancreatitis | Yes | Skin & Coat Hero contains 18,33% fat. Ensure total fat content from food does not exceed 15%. |
| Dysbiosis | Yes | Skin & Coat Hero supports gut microbiome health. |
| Pancreatic Liver Failure or other liver problems | Yes | No ingredients in Skin & Coat Hero harm the liver. |
| Food Allergies/ Dermatitis | Yes | Skin & Coat Hero is hypoallergenic and doesn't contain any allergens. |
| Leishman-iasis | Yes | Use Skin & Coat Hero regularly for long-term immune support. |
| Chronic Gastritis | Yes | Skin & Coat Hero supports your dog's digestive health. Do review the ingredient list to make sure your dog has no specific intolerances to Skin & Coat Hero ingredients. |
| Chronic Enteritis | Yes | Supports gut health and helps with digestion issues. |
| Pancreatic Insufficiency | Yes | Helps gut flora. Use regularly for long-term health. |
| Malassezia | Yes | Supports immunity and gut health. |
Health Issue | Safe to Use? | Additional Info |
| Any dog breed | Yes | Skin & Coat Hero is suitable for all dog breeds |
| Any dog size | Yes | Skin & Coat Hero is suitable for all dog sizes |
| Puppies (under 6 months) | No | Not suitable for dogs under 6 months |
| Puppies (above 6 months) | Yes | Suitable for dogs over 6 months |
| Portosys-temic Shunt | Yes | Adjust diet to account for salmon content. |
| Pancreatitis | Yes | Skin & Coat Hero contains 18,33% fat. Ensure total fat content from food does not exceed 15%. |
| Dysbiosis | Yes | Skin & Coat Hero supports gut microbiome health. |
| Pancreatic Liver Failure or other liver problems | Yes | No ingredients in Skin & Coat Hero harm the liver. |
| Food Allergies/ Dermatitis | Yes | Skin & Coat Hero is hypoallergenic and doesn't contain any allergens. |
| Leishman-iasis | Yes | Use Skin & Coat Hero regularly for long-term immune support. |
| Chronic Gastritis | Yes | Skin & Coat Hero supports your dog's digestive health. Do review the ingredient list to make sure your dog has no specific intolerances to Skin & Coat Hero ingredients. |
| Chronic Enteritis | Yes | Supports gut health and helps with digestion issues. |
| Pancreatic Insufficiency | Yes | Helps gut flora. Use regularly for long-term health. |
| Malassezia | Yes | Supports immunity and gut health. |
Gesund-heitsproblem | Sicher zu benu-tzen? | Zusätzliche Informationen |
| Jede Hunderasse | Ja | Skin & Coat Hero ist für alle Hunderassen geeignet. |
| Jede Hundegröße | Ja | Skin & Coat Hero ist für alle Hundegrößen geeignet. |
| Welpen (unter 6 Monaten) | Nein | Nicht geeignet für Hunde unter 6 Monaten. |
| Welpen (über 6 Monaten) | Ja | Geeignet für Hunde über 6 Monate. |
| Portosys-temischer Shunt | Ja | Passen Sie die Ernährung an, um den Lachsgehalt zu berücksichtigen. |
| Pankreatitis | Ja | Skin & Coat Hero enthält 18,33 % Fett. Stellen Sie sicher, dass der gesamte Fettgehalt aus der ganzen Nahrung die 15 % nicht überschreitet. |
| Dysbiose | Ja | Skin & Coat Hero unterstützt die Gesundheit des Darmmikrobioms. |
| Pankreas-leberin-suffizienz oder andere Leberprobleme | Ja | Keine Inhaltsstoffe in Skin & Coat Hero, die der Leber schädigen könnten. |
| Lebensmittel-allergien/ Dermatitis | Ja | Skin & Coat Hero ist hypoallergen und enthält keine Allergene. |
| Leishmaniose | Ja | Verwende Skin & Coat Hero regelmäßig zur langfristigen Unterstützung des Immunsystems Ihres Hundes. |
| Chronische Gastritis | Ja | Skin & Coat Hero unterstützt die Verdauungsgesundheit Ihres Hundes. Überprüfen Sie die Zutatenliste, um sicherzustellen, dass Ihr Hund keine spezifischen Unverträglichkeiten gegenüber den Inhaltsstoffen von Skin & Coat Hero hat. |
| Chronische Enteritis | Ja | Unterstützt die Darmgesundheit und hilft bei Verdauungsproblemen. |
| Pankreasins-uffizienz | Ja | Hilft der Darmflora. Verwenden Sie es regelmäßig für die langfristige Gesundheit Ihres Hundes. |
| Malassezia | Ja | Unterstützt das Immunsystem und die Darmgesundheit. |
Gesund-heitsproblem | Sicher zu benu-tzen? | Zusätzliche Informationen |
| Jede Hunderasse | Ja | Skin & Coat Hero ist für alle Hunderassen geeignet. |
| Jede Hundegröße | Ja | Skin & Coat Hero ist für alle Hundegrößen geeignet. |
| Welpen (unter 6 Monaten) | Nein | Nicht geeignet für Hunde unter 6 Monaten. |
| Welpen (über 6 Monaten) | Ja | Geeignet für Hunde über 6 Monate. |
| Portosys-temischer Shunt | Ja | Passen Sie die Ernährung an, um den Lachsgehalt zu berücksichtigen. |
| Pankreatitis | Ja | Skin & Coat Hero enthält 18,33 % Fett. Stellen Sie sicher, dass der gesamte Fettgehalt aus der ganzen Nahrung die 15 % nicht überschreitet. |
| Dysbiose | Ja | Skin & Coat Hero unterstützt die Gesundheit des Darmmikrobioms. |
| Pankreas-leberin-suffizienz oder andere Leberprobleme | Ja | Keine Inhaltsstoffe in Skin & Coat Hero, die der Leber schädigen könnten. |
| Lebensmittel-allergien/ Dermatitis | Ja | Skin & Coat Hero ist hypoallergen und enthält keine Allergene. |
| Leishmaniose | Ja | Verwende Skin & Coat Hero regelmäßig zur langfristigen Unterstützung des Immunsystems Ihres Hundes. |
| Chronische Gastritis | Ja | Skin & Coat Hero unterstützt die Verdauungsgesundheit Ihres Hundes. Überprüfen Sie die Zutatenliste, um sicherzustellen, dass Ihr Hund keine spezifischen Unverträglichkeiten gegenüber den Inhaltsstoffen von Skin & Coat Hero hat. |
| Chronische Enteritis | Ja | Unterstützt die Darmgesundheit und hilft bei Verdauungsproblemen. |
| Pankreasins-uffizienz | Ja | Hilft der Darmflora. Verwenden Sie es regelmäßig für die langfristige Gesundheit Ihres Hundes. |
| Malassezia | Ja | Unterstützt das Immunsystem und die Darmgesundheit. |
Gesund-heitsproblem | Sicher zu benu-tzen? | Zusätzliche Informationen |
| Jede Hunderasse | Ja | Skin & Coat Hero ist für alle Hunderassen geeignet. |
| Jede Hundegröße | Ja | Skin & Coat Hero ist für alle Hundegrößen geeignet. |
| Welpen (unter 6 Monaten) | Nein | Nicht geeignet für Hunde unter 6 Monaten. |
| Welpen (über 6 Monaten) | Ja | Geeignet für Hunde über 6 Monate. |
| Portosys-temischer Shunt | Ja | Passen Sie die Ernährung an, um den Lachsgehalt zu berücksichtigen. |
| Pankreatitis | Ja | Skin & Coat Hero enthält 18,33 % Fett. Stellen Sie sicher, dass der gesamte Fettgehalt aus der ganzen Nahrung die 15 % nicht überschreitet. |
| Dysbiose | Ja | Skin & Coat Hero unterstützt die Gesundheit des Darmmikrobioms. |
| Pankreas-leberin-suffizienz oder andere Leberprobleme | Ja | Keine Inhaltsstoffe in Skin & Coat Hero, die der Leber schädigen könnten. |
| Lebensmittel-allergien/ Dermatitis | Ja | Skin & Coat Hero ist hypoallergen und enthält keine Allergene. |
| Leishmaniose | Ja | Verwende Skin & Coat Hero regelmäßig zur langfristigen Unterstützung des Immunsystems Ihres Hundes. |
| Chronische Gastritis | Ja | Skin & Coat Hero unterstützt die Verdauungsgesundheit Ihres Hundes. Überprüfen Sie die Zutatenliste, um sicherzustellen, dass Ihr Hund keine spezifischen Unverträglichkeiten gegenüber den Inhaltsstoffen von Skin & Coat Hero hat. |
| Chronische Enteritis | Ja | Unterstützt die Darmgesundheit und hilft bei Verdauungsproblemen. |
| Pankreasins-uffizienz | Ja | Hilft der Darmflora. Verwenden Sie es regelmäßig für die langfristige Gesundheit Ihres Hundes. |
| Malassezia | Ja | Unterstützt das Immunsystem und die Darmgesundheit. |
Problema di salute | Uso sicuro? | Informazioni aggiuntive |
| Qualsiasi razza di cane | Sì | Skin & Coat Hero è adatto a tutte le razze di cani |
| Qualsiasi taglia di cane | Sì | Skin & Coat Heroè adatto a tutte le taglie di cani |
| Cuccioli (sotto i 6 mesi) | No | Non adatto ai cani di età inferiore ai 6 mesi |
| Cuccioli (sopra i 6 mesi) | Sì | Adatto ai cani di età superiore ai 6 mesi |
| Shunt portosistemico | Sì | Adattare la dieta per tenere conto del contenuto di salmone. |
| Pancreatite | Sì | Skin & Coat Hero contiene il 18,33% di grassi. Assicurarsi che il contenuto totale di grassi nell'alimento non superi il 15%. |
| Disbiosi | Sì | Skin & Coat Hero supporta la salute del microbioma intestinale. |
| Insufficienza epatica pancreatica o altri problemi epatici | Sì | Nessun ingrediente di Skin & Coat Hero danneggia il fegato. |
| Allergie alimentari/Dermatite | Sì | Skin & Coat Hero è ipoallergenico e non contiene allergeni. |
| Leishmaniosi | Sì | Utilizzate regolarmente Skin & Coat Hero per un supporto immunitario a lungo termine. |
| Gastrite cronica | Sì | Skin & Coat Hero favorisce la salute dell'apparato digerente del cane. Controllare l'elenco degli ingredienti per assicurarsi che il cane non abbia intolleranze specifiche agli ingredienti di Skin & Coat Hero. |
| Enterite cronica | Sì | Supporta la salute intestinale e aiuta a risolvere i problemi di digestione. |
| Insufficienza pancreatica | Sì | Aiuta la flora intestinale. Usare regolarmente per una salute a lungo termine. |
| Malassezia | Sì | Supporta l'immunità e la salute intestinale. |
Problema di salute | Uso sicuro? | Informazioni aggiuntive |
| Qualsiasi razza di cane | Sì | Skin & Coat Hero è adatto a tutte le razze di cani |
| Qualsiasi taglia di cane | Sì | Skin & Coat Heroè adatto a tutte le taglie di cani |
| Cuccioli (sotto i 6 mesi) | No | Non adatto ai cani di età inferiore ai 6 mesi |
| Cuccioli (sopra i 6 mesi) | Sì | Adatto ai cani di età superiore ai 6 mesi |
| Shunt portosistemico | Sì | Adattare la dieta per tenere conto del contenuto di salmone. |
| Pancreatite | Sì | Skin & Coat Hero contiene il 18,33% di grassi. Assicurarsi che il contenuto totale di grassi nell'alimento non superi il 15%. |
| Disbiosi | Sì | Skin & Coat Hero supporta la salute del microbioma intestinale. |
| Insufficienza epatica pancreatica o altri problemi epatici | Sì | Nessun ingrediente di Skin & Coat Hero danneggia il fegato. |
| Allergie alimentari/Dermatite | Sì | Skin & Coat Hero è ipoallergenico e non contiene allergeni. |
| Leishmaniosi | Sì | Utilizzate regolarmente Skin & Coat Hero per un supporto immunitario a lungo termine. |
| Gastrite cronica | Sì | Skin & Coat Hero favorisce la salute dell'apparato digerente del cane. Controllare l'elenco degli ingredienti per assicurarsi che il cane non abbia intolleranze specifiche agli ingredienti di Skin & Coat Hero. |
| Enterite cronica | Sì | Supporta la salute intestinale e aiuta a risolvere i problemi di digestione. |
| Insufficienza pancreatica | Sì | Aiuta la flora intestinale. Usare regolarmente per una salute a lungo termine. |
| Malassezia | Sì | Supporta l'immunità e la salute intestinale. |
Problema di salute | Uso sicuro? | Informazioni aggiuntive |
| Qualsiasi razza di cane | Sì | Skin & Coat Hero è adatto a tutte le razze di cani |
| Qualsiasi taglia di cane | Sì | Skin & Coat Heroè adatto a tutte le taglie di cani |
| Cuccioli (sotto i 6 mesi) | No | Non adatto ai cani di età inferiore ai 6 mesi |
| Cuccioli (sopra i 6 mesi) | Sì | Adatto ai cani di età superiore ai 6 mesi |
| Shunt portosistemico | Sì | Adattare la dieta per tenere conto del contenuto di salmone. |
| Pancreatite | Sì | Skin & Coat Hero contiene il 18,33% di grassi. Assicurarsi che il contenuto totale di grassi nell'alimento non superi il 15%. |
| Disbiosi | Sì | Skin & Coat Hero supporta la salute del microbioma intestinale. |
| Insufficienza epatica pancreatica o altri problemi epatici | Sì | Nessun ingrediente di Skin & Coat Hero danneggia il fegato. |
| Allergie alimentari/Dermatite | Sì | Skin & Coat Hero è ipoallergenico e non contiene allergeni. |
| Leishmaniosi | Sì | Utilizzate regolarmente Skin & Coat Hero per un supporto immunitario a lungo termine. |
| Gastrite cronica | Sì | Skin & Coat Hero favorisce la salute dell'apparato digerente del cane. Controllare l'elenco degli ingredienti per assicurarsi che il cane non abbia intolleranze specifiche agli ingredienti di Skin & Coat Hero. |
| Enterite cronica | Sì | Supporta la salute intestinale e aiuta a risolvere i problemi di digestione. |
| Insufficienza pancreatica | Sì | Aiuta la flora intestinale. Usare regolarmente per una salute a lungo termine. |
| Malassezia | Sì | Supporta l'immunità e la salute intestinale. |
Cosa sono i postbiotici
I postbiotici sono i sottoprodotti benefici prodotti dai batteri buoni durante la fermentazione. A differenza dei probiotici, che sono batteri vivi, i postbiotici forniscono i composti salutari direttamente all'intestino, garantendo la massima efficacia e stabilità.
Migliori dei probiotici: I postbiotici forniscono metaboliti benefici direttamente all'intestino del cane, evitando la necessità di batteri vivi.
Sopravvivenza: A differenza dei probiotici, i postbiotici sopravvivono ai succhi gastrici e non richiedono una conservazione speciale.
Benefici per la salute costanti: I postbiotici offrono benefici prevedibili per la salute, migliorando la riparazione intestinale e l'immunità indipendentemente dal microbiota del cane.
Salute intestinale avanzata: I postbiotici aiutano a riequilibrare la flora intestinale del cane, promuovendo il benessere generale.
Cosa sono i postbiotici
I postbiotici sono i sottoprodotti benefici prodotti dai batteri buoni durante la fermentazione. A differenza dei probiotici, che sono batteri vivi, i postbiotici forniscono i composti salutari direttamente all'intestino, garantendo la massima efficacia e stabilità.
Migliori dei probiotici: I postbiotici forniscono metaboliti benefici direttamente all'intestino del cane, evitando la necessità di batteri vivi.
Sopravvivenza: A differenza dei probiotici, i postbiotici sopravvivono ai succhi gastrici e non richiedono una conservazione speciale.
Benefici per la salute costanti: I postbiotici offrono benefici prevedibili per la salute, migliorando la riparazione intestinale e l'immunità indipendentemente dal microbiota del cane.
Salute intestinale avanzata: I postbiotici aiutano a riequilibrare la flora intestinale del cane, promuovendo il benessere generale.
Cosa sono i postbiotici
I postbiotici sono i sottoprodotti benefici prodotti dai batteri buoni durante la fermentazione. A differenza dei probiotici, che sono batteri vivi, i postbiotici forniscono i composti salutari direttamente all'intestino, garantendo la massima efficacia e stabilità.
Migliori dei probiotici: I postbiotici forniscono metaboliti benefici direttamente all'intestino del cane, evitando la necessità di batteri vivi.
Sopravvivenza: A differenza dei probiotici, i postbiotici sopravvivono ai succhi gastrici e non richiedono una conservazione speciale.
Benefici per la salute costanti: I postbiotici offrono benefici prevedibili per la salute, migliorando la riparazione intestinale e l'immunità indipendentemente dal microbiota del cane.
Salute intestinale avanzata: I postbiotici aiutano a riequilibrare la flora intestinale del cane, promuovendo il benessere generale.
What are postbiotics
Postbiotics are the beneficial byproducts produced by good bacteria during fermentation. Unlike probiotics, which are live bacteria, postbiotics deliver the health-boosting compounds directly to the gut, ensuring maximum efficacy and stability.
Better Than Probiotics: Postbiotics deliver beneficial metabolites directly to your dog's gut, bypassing the need for live bacteria.
Survivability: Unlike probiotics, postbiotics survive stomach acid and don’t require special storage.
Consistent Health Benefits: Postbiotics offer predictable health benefits, enhancing gut repair and immunity regardless of your dog's microbiota.
Advanced Gut Health: Postbiotics help re-balance your dog's gut flora, promoting overall well-being.
What are postbiotics
Postbiotics are the beneficial byproducts produced by good bacteria during fermentation. Unlike probiotics, which are live bacteria, postbiotics deliver the health-boosting compounds directly to the gut, ensuring maximum efficacy and stability.
Better Than Probiotics: Postbiotics deliver beneficial metabolites directly to your dog's gut, bypassing the need for live bacteria.
Survivability: Unlike probiotics, postbiotics survive stomach acid and don’t require special storage.
Consistent Health Benefits: Postbiotics offer predictable health benefits, enhancing gut repair and immunity regardless of your dog's microbiota.
Advanced Gut Health: Postbiotics help re-balance your dog's gut flora, promoting overall well-being.
What are postbiotics
Postbiotics are the beneficial byproducts produced by good bacteria during fermentation. Unlike probiotics, which are live bacteria, postbiotics deliver the health-boosting compounds directly to the gut, ensuring maximum efficacy and stability.
Better Than Probiotics: Postbiotics deliver beneficial metabolites directly to your dog's gut, bypassing the need for live bacteria.
Survivability: Unlike probiotics, postbiotics survive stomach acid and don’t require special storage.
Consistent Health Benefits: Postbiotics offer predictable health benefits, enhancing gut repair and immunity regardless of your dog's microbiota.
Advanced Gut Health: Postbiotics help re-balance your dog's gut flora, promoting overall well-being.
Was sind Postbiotika
Postbiotika sind die nützlichen Nebenprodukte, die von guten Bakterien während der Fermentation produziert werden. Im Gegensatz zu Probiotika, die lebende Bakterien sind, liefern Postbiotika die gesundheitsfördernden Verbindungen direkt in den Darm und sorgen so für maximale Wirksamkeit und Stabilität.
Besser als Probiotika: Postbiotika liefern nützliche Metaboliten direkt in den Darm Ihres Hundes und umgehen dabei die Notwendigkeit für lebende Bakterien.
Überlebensfähigkeit: Im Gegensatz zu Probiotika überleben Postbiotika die Magensäure und erfordern keine spezielle Lagerung.
Konstante gesundheitliche Vorteile: Postbiotika bieten vorhersehbare gesundheitliche Vorteile, fördern die Darmreparatur und stärken das Immunsystem unabhängig von der Mikrobiota Ihres Hundes.
Fortschrittliche Darmgesundheit: Postbiotika helfen, die Darmflora Ihres Hundes wieder ins Gleichgewicht zu bringen, und fördern das allgemeine Wohlbefinden Ihres Hundes.
Was sind Postbiotika
Postbiotika sind die nützlichen Nebenprodukte, die von guten Bakterien während der Fermentation produziert werden. Im Gegensatz zu Probiotika, die lebende Bakterien sind, liefern Postbiotika die gesundheitsfördernden Verbindungen direkt in den Darm und sorgen so für maximale Wirksamkeit und Stabilität.
Besser als Probiotika: Postbiotika liefern nützliche Metaboliten direkt in den Darm Ihres Hundes und umgehen dabei die Notwendigkeit für lebende Bakterien.
Überlebensfähigkeit: Im Gegensatz zu Probiotika überleben Postbiotika die Magensäure und erfordern keine spezielle Lagerung.
Konstante gesundheitliche Vorteile: Postbiotika bieten vorhersehbare gesundheitliche Vorteile, fördern die Darmreparatur und stärken das Immunsystem unabhängig von der Mikrobiota Ihres Hundes.
Fortschrittliche Darmgesundheit: Postbiotika helfen, die Darmflora Ihres Hundes wieder ins Gleichgewicht zu bringen, und fördern das allgemeine Wohlbefinden Ihres Hundes.
Was sind Postbiotika
Postbiotika sind die nützlichen Nebenprodukte, die von guten Bakterien während der Fermentation produziert werden. Im Gegensatz zu Probiotika, die lebende Bakterien sind, liefern Postbiotika die gesundheitsfördernden Verbindungen direkt in den Darm und sorgen so für maximale Wirksamkeit und Stabilität.
Besser als Probiotika: Postbiotika liefern nützliche Metaboliten direkt in den Darm Ihres Hundes und umgehen dabei die Notwendigkeit für lebende Bakterien.
Überlebensfähigkeit: Im Gegensatz zu Probiotika überleben Postbiotika die Magensäure und erfordern keine spezielle Lagerung.
Konstante gesundheitliche Vorteile: Postbiotika bieten vorhersehbare gesundheitliche Vorteile, fördern die Darmreparatur und stärken das Immunsystem unabhängig von der Mikrobiota Ihres Hundes.
Fortschrittliche Darmgesundheit: Postbiotika helfen, die Darmflora Ihres Hundes wieder ins Gleichgewicht zu bringen, und fördern das allgemeine Wohlbefinden Ihres Hundes.
Problema di salute | Uso sicuro? | Informazioni aggiuntive |
| Qualsiasi razza di cane | Sì | Belly Champ è adatto a tutte le razze di cani |
| Qualsiasi taglia di cane | Sì | Belly Champ è adatto a tutte le taglie di cani |
| Cuccioli (sotto i 6 mesi) | No | Non adatto ai cani di età inferiore ai 6 mesi |
| Cuccioli (sopra i 6 mesi) | Sì | Adatto ai cani di età superiore ai 6 mesi |
| Shunt portosistemico | Sì | Adattare la dieta per tenere conto del contenuto di salmone. |
| Pancreatite | Sì | Belly Champ contiene il 12% di grassi (circa 0,96g/bocconcino). Assicurarsi che il contenuto totale di grassi nell'alimento non superi il 15%. |
| Disbiosi | Sì | Belly Champ supporta la salute del microbioma intestinale. |
| Insufficienza epatica pancreatica o altri problemi epatici | Sì | Nessun ingrediente di Belly Champ danneggia il fegato. |
| Allergie alimentari/Dermatite | Sì | Belly Champ è ipoallergenico e non contiene allergeni. |
| Leishmaniosi | Sì | Utilizzate regolarmente Belly Champ per un supporto immunitario a lungo termine. |
| Gastrite cronica | Sì | Belly Champ favorisce la salute dell'apparato digerente del cane. Controllare l'elenco degli ingredienti per assicurarsi che il cane non abbia intolleranze specifiche agli ingredienti di Belly Champ. |
| Enterite cronica | Sì | Supporta la salute intestinale e aiuta a risolvere i problemi di digestione. |
| Insufficienza pancreatica | Sì | Aiuta la flora intestinale. Usare regolarmente per una salute a lungo termine. |
| Malassezia | Sì | Supporta l'immunità e la salute intestinale. |
Problema di salute | Uso sicuro? | Informazioni aggiuntive |
| Qualsiasi razza di cane | Sì | Belly Champ è adatto a tutte le razze di cani |
| Qualsiasi taglia di cane | Sì | Belly Champ è adatto a tutte le taglie di cani |
| Cuccioli (sotto i 6 mesi) | No | Non adatto ai cani di età inferiore ai 6 mesi |
| Cuccioli (sopra i 6 mesi) | Sì | Adatto ai cani di età superiore ai 6 mesi |
| Shunt portosistemico | Sì | Adattare la dieta per tenere conto del contenuto di salmone. |
| Pancreatite | Sì | Belly Champ contiene il 12% di grassi (circa 0,96g/bocconcino). Assicurarsi che il contenuto totale di grassi nell'alimento non superi il 15%. |
| Disbiosi | Sì | Belly Champ supporta la salute del microbioma intestinale. |
| Insufficienza epatica pancreatica o altri problemi epatici | Sì | Nessun ingrediente di Belly Champ danneggia il fegato. |
| Allergie alimentari/Dermatite | Sì | Belly Champ è ipoallergenico e non contiene allergeni. |
| Leishmaniosi | Sì | Utilizzate regolarmente Belly Champ per un supporto immunitario a lungo termine. |
| Gastrite cronica | Sì | Belly Champ favorisce la salute dell'apparato digerente del cane. Controllare l'elenco degli ingredienti per assicurarsi che il cane non abbia intolleranze specifiche agli ingredienti di Belly Champ. |
| Enterite cronica | Sì | Supporta la salute intestinale e aiuta a risolvere i problemi di digestione. |
| Insufficienza pancreatica | Sì | Aiuta la flora intestinale. Usare regolarmente per una salute a lungo termine. |
| Malassezia | Sì | Supporta l'immunità e la salute intestinale. |
Problema di salute | Uso sicuro? | Informazioni aggiuntive |
| Qualsiasi razza di cane | Sì | Belly Champ è adatto a tutte le razze di cani |
| Qualsiasi taglia di cane | Sì | Belly Champ è adatto a tutte le taglie di cani |
| Cuccioli (sotto i 6 mesi) | No | Non adatto ai cani di età inferiore ai 6 mesi |
| Cuccioli (sopra i 6 mesi) | Sì | Adatto ai cani di età superiore ai 6 mesi |
| Shunt portosistemico | Sì | Adattare la dieta per tenere conto del contenuto di salmone. |
| Pancreatite | Sì | Belly Champ contiene il 12% di grassi (circa 0,96g/bocconcino). Assicurarsi che il contenuto totale di grassi nell'alimento non superi il 15%. |
| Disbiosi | Sì | Belly Champ supporta la salute del microbioma intestinale. |
| Insufficienza epatica pancreatica o altri problemi epatici | Sì | Nessun ingrediente di Belly Champ danneggia il fegato. |
| Allergie alimentari/Dermatite | Sì | Belly Champ è ipoallergenico e non contiene allergeni. |
| Leishmaniosi | Sì | Utilizzate regolarmente Belly Champ per un supporto immunitario a lungo termine. |
| Gastrite cronica | Sì | Belly Champ favorisce la salute dell'apparato digerente del cane. Controllare l'elenco degli ingredienti per assicurarsi che il cane non abbia intolleranze specifiche agli ingredienti di Belly Champ. |
| Enterite cronica | Sì | Supporta la salute intestinale e aiuta a risolvere i problemi di digestione. |
| Insufficienza pancreatica | Sì | Aiuta la flora intestinale. Usare regolarmente per una salute a lungo termine. |
| Malassezia | Sì | Supporta l'immunità e la salute intestinale. |
Gesund-heitsproblem | Sicher zu benu-tzen? | Zusätzliche Informationen |
| Jede Hunderasse | Ja | Belly Champ ist für alle Hunderassen geeignet. |
| Jede Hundegröße | Ja | Belly Champ ist für alle Hundegrößen geeignet. |
| Welpen (unter 6 Monaten) | Nein | Nicht geeignet für Hunde unter 6 Monaten. |
| Welpen (über 6 Monaten) | Ja | Geeignet für Hunde über 6 Monate. |
| Portosys-temischer Shunt | Ja | Passen Sie die Ernährung an, um den Lachsgehalt zu berücksichtigen. |
| Pankreatitis | Ja | Belly Champ enthält 12 % Fett (ca. 0,96 g/Leckerli). Stellen Sie sicher, dass der gesamte Fettgehalt aus der ganzen Nahrung die 15 % nicht überschreitet. |
| Dysbiose | Ja | Belly Champ unterstützt die Gesundheit des Darmmikrobioms. |
| Pankreas-leberin-suffizienz oder andere Leberprobleme | Ja | Keine Inhaltsstoffe in Belly Champ oder Wunder Dog, die der Leber schädigen könnten. |
| Lebensmittel-allergien/ Dermatitis | Ja | Belly Champ ist hypoallergen und enthält keine Allergene. |
| Leishmaniose | Ja | Verwende Belly Champ regelmäßig zur langfristigen Unterstützung des Immunsystems Ihres Hundes. |
| Chronische Gastritis | Ja | Belly Champ unterstützt die Verdauungsgesundheit Ihres Hundes. Überprüfen Sie die Zutatenliste, um sicherzustellen, dass Ihr Hund keine spezifischen Unverträglichkeiten gegenüber den Inhaltsstoffen von Belly Champ hat. |
| Chronische Enteritis | Ja | Unterstützt die Darmgesundheit und hilft bei Verdauungsproblemen. |
| Pankreasins-uffizienz | Ja | Hilft der Darmflora. Verwenden Sie es regelmäßig für die langfristige Gesundheit Ihres Hundes. |
| Malassezia | Ja | Unterstützt das Immunsystem und die Darmgesundheit. |
Gesund-heitsproblem | Sicher zu benu-tzen? | Zusätzliche Informationen |
| Jede Hunderasse | Ja | Belly Champ ist für alle Hunderassen geeignet. |
| Jede Hundegröße | Ja | Belly Champ ist für alle Hundegrößen geeignet. |
| Welpen (unter 6 Monaten) | Nein | Nicht geeignet für Hunde unter 6 Monaten. |
| Welpen (über 6 Monaten) | Ja | Geeignet für Hunde über 6 Monate. |
| Portosys-temischer Shunt | Ja | Passen Sie die Ernährung an, um den Lachsgehalt zu berücksichtigen. |
| Pankreatitis | Ja | Belly Champ enthält 12 % Fett (ca. 0,96 g/Leckerli). Stellen Sie sicher, dass der gesamte Fettgehalt aus der ganzen Nahrung die 15 % nicht überschreitet. |
| Dysbiose | Ja | Belly Champ unterstützt die Gesundheit des Darmmikrobioms. |
| Pankreas-leberin-suffizienz oder andere Leberprobleme | Ja | Keine Inhaltsstoffe in Belly Champ oder Wunder Dog, die der Leber schädigen könnten. |
| Lebensmittel-allergien/ Dermatitis | Ja | Belly Champ ist hypoallergen und enthält keine Allergene. |
| Leishmaniose | Ja | Verwende Belly Champ regelmäßig zur langfristigen Unterstützung des Immunsystems Ihres Hundes. |
| Chronische Gastritis | Ja | Belly Champ unterstützt die Verdauungsgesundheit Ihres Hundes. Überprüfen Sie die Zutatenliste, um sicherzustellen, dass Ihr Hund keine spezifischen Unverträglichkeiten gegenüber den Inhaltsstoffen von Belly Champ hat. |
| Chronische Enteritis | Ja | Unterstützt die Darmgesundheit und hilft bei Verdauungsproblemen. |
| Pankreasins-uffizienz | Ja | Hilft der Darmflora. Verwenden Sie es regelmäßig für die langfristige Gesundheit Ihres Hundes. |
| Malassezia | Ja | Unterstützt das Immunsystem und die Darmgesundheit. |
Gesund-heitsproblem | Sicher zu benu-tzen? | Zusätzliche Informationen |
| Jede Hunderasse | Ja | Belly Champ ist für alle Hunderassen geeignet. |
| Jede Hundegröße | Ja | Belly Champ ist für alle Hundegrößen geeignet. |
| Welpen (unter 6 Monaten) | Nein | Nicht geeignet für Hunde unter 6 Monaten. |
| Welpen (über 6 Monaten) | Ja | Geeignet für Hunde über 6 Monate. |
| Portosys-temischer Shunt | Ja | Passen Sie die Ernährung an, um den Lachsgehalt zu berücksichtigen. |
| Pankreatitis | Ja | Belly Champ enthält 12 % Fett (ca. 0,96 g/Leckerli). Stellen Sie sicher, dass der gesamte Fettgehalt aus der ganzen Nahrung die 15 % nicht überschreitet. |
| Dysbiose | Ja | Belly Champ unterstützt die Gesundheit des Darmmikrobioms. |
| Pankreas-leberin-suffizienz oder andere Leberprobleme | Ja | Keine Inhaltsstoffe in Belly Champ oder Wunder Dog, die der Leber schädigen könnten. |
| Lebensmittel-allergien/ Dermatitis | Ja | Belly Champ ist hypoallergen und enthält keine Allergene. |
| Leishmaniose | Ja | Verwende Belly Champ regelmäßig zur langfristigen Unterstützung des Immunsystems Ihres Hundes. |
| Chronische Gastritis | Ja | Belly Champ unterstützt die Verdauungsgesundheit Ihres Hundes. Überprüfen Sie die Zutatenliste, um sicherzustellen, dass Ihr Hund keine spezifischen Unverträglichkeiten gegenüber den Inhaltsstoffen von Belly Champ hat. |
| Chronische Enteritis | Ja | Unterstützt die Darmgesundheit und hilft bei Verdauungsproblemen. |
| Pankreasins-uffizienz | Ja | Hilft der Darmflora. Verwenden Sie es regelmäßig für die langfristige Gesundheit Ihres Hundes. |
| Malassezia | Ja | Unterstützt das Immunsystem und die Darmgesundheit. |
Health Issue | Safe to Use? | Additional Info |
| Any dog breed | Yes | Belly Champ is suitable for all dog breeds |
| Any dog size | Yes | Belly Champ is suitable for all dog sizes |
| Puppies (under 6 months) | No | Not suitable for dogs under 6 months |
| Puppies (above 6 months) | Yes | Suitable for dogs over 6 months |
| Portosys-temic Shunt | Yes | Adjust diet to account for salmon content. |
| Pancreatitis | Yes | Belly Champ contains 12% fat (app. 0.96g/treat). Ensure total fat content from food does not exceed 15%. |
| Dysbiosis | Yes | Belly Champ supports gut microbiome health. |
| Pancreatic Liver Failure or other liver problems | Yes | No ingredients in Belly Champ or Wunder Dog harm the liver. |
| Food Allergies/ Dermatitis | Yes | Belly Champ is hypoallergenic and doesn't contain any allergens. |
| Leishman-iasis | Yes | Use Belly Champ regularly for long-term immune support. |
| Chronic Gastritis | Yes | Belly Champ supports your dog's digestive health. Do review the ingredient list to make sure your dog has no specific intolerances to Belly Champ ingredients. |
| Chronic Enteritis | Yes | Supports gut health and helps with digestion issues. |
| Pancreatic Insufficiency | Yes | Helps gut flora. Use regularly for long-term health. |
| Malassezia | Yes | Supports immunity and gut health. |
Health Issue | Safe to Use? | Additional Info |
| Any dog breed | Yes | Belly Champ is suitable for all dog breeds |
| Any dog size | Yes | Belly Champ is suitable for all dog sizes |
| Puppies (under 6 months) | No | Not suitable for dogs under 6 months |
| Puppies (above 6 months) | Yes | Suitable for dogs over 6 months |
| Portosys-temic Shunt | Yes | Adjust diet to account for salmon content. |
| Pancreatitis | Yes | Belly Champ contains 12% fat (app. 0.96g/treat). Ensure total fat content from food does not exceed 15%. |
| Dysbiosis | Yes | Belly Champ supports gut microbiome health. |
| Pancreatic Liver Failure or other liver problems | Yes | No ingredients in Belly Champ or Wunder Dog harm the liver. |
| Food Allergies/ Dermatitis | Yes | Belly Champ is hypoallergenic and doesn't contain any allergens. |
| Leishman-iasis | Yes | Use Belly Champ regularly for long-term immune support. |
| Chronic Gastritis | Yes | Belly Champ supports your dog's digestive health. Do review the ingredient list to make sure your dog has no specific intolerances to Belly Champ ingredients. |
| Chronic Enteritis | Yes | Supports gut health and helps with digestion issues. |
| Pancreatic Insufficiency | Yes | Helps gut flora. Use regularly for long-term health. |
| Malassezia | Yes | Supports immunity and gut health. |
Health Issue | Safe to Use? | Additional Info |
| Any dog breed | Yes | Belly Champ is suitable for all dog breeds |
| Any dog size | Yes | Belly Champ is suitable for all dog sizes |
| Puppies (under 6 months) | No | Not suitable for dogs under 6 months |
| Puppies (above 6 months) | Yes | Suitable for dogs over 6 months |
| Portosys-temic Shunt | Yes | Adjust diet to account for salmon content. |
| Pancreatitis | Yes | Belly Champ contains 12% fat (app. 0.96g/treat). Ensure total fat content from food does not exceed 15%. |
| Dysbiosis | Yes | Belly Champ supports gut microbiome health. |
| Pancreatic Liver Failure or other liver problems | Yes | No ingredients in Belly Champ or Wunder Dog harm the liver. |
| Food Allergies/ Dermatitis | Yes | Belly Champ is hypoallergenic and doesn't contain any allergens. |
| Leishman-iasis | Yes | Use Belly Champ regularly for long-term immune support. |
| Chronic Gastritis | Yes | Belly Champ supports your dog's digestive health. Do review the ingredient list to make sure your dog has no specific intolerances to Belly Champ ingredients. |
| Chronic Enteritis | Yes | Supports gut health and helps with digestion issues. |
| Pancreatic Insufficiency | Yes | Helps gut flora. Use regularly for long-term health. |
| Malassezia | Yes | Supports immunity and gut health. |
Come posso richiedere un rimborso?
Se si desidera richiedere un rimborso, è sufficiente inviare un'e-mail all'indirizzo support@pawital.com indicando il motivo della richiesta. Il rimborso verrà elaborato entro 3 giorni lavorativi.
A Pawital siamo convinti della qualità dei nostri prodotti e vogliamo che voi e il vostro amico peloso siate completamente soddisfatti del vostro acquisto. Siamo consapevoli che ogni cane è unico e che ciò che funziona per uno può non funzionare per un altro. Ecco perché offriamo una politica di rimborso semplice e senza problemi.
Per richiedere un rimborso, seguite questi semplici passi:
1. Motivo del rimborso: Inviateci un'e-mail all'indirizzo support@pawital.com entro 30 giorni dall'acquisto, indicando il motivo della vostra insoddisfazione. I motivi possono includere:
2. La restituzione non è necessaria: Se avete ordinato un singolo prodotto, non è necessario restituirlo per richiedere il rimborso. Tuttavia, vi chiederemo di restituire le confezioni non utilizzate.
I rimborsi vengono elaborati entro 3 giorni lavorativi dalla data della richiesta, in modo da garantire che riceviate il vostro denaro senza ritardi.
Come posso richiedere un rimborso?
Se si desidera richiedere un rimborso, è sufficiente inviare un'e-mail all'indirizzo support@pawital.com indicando il motivo della richiesta. Il rimborso verrà elaborato entro 3 giorni lavorativi.
A Pawital siamo convinti della qualità dei nostri prodotti e vogliamo che voi e il vostro amico peloso siate completamente soddisfatti del vostro acquisto. Siamo consapevoli che ogni cane è unico e che ciò che funziona per uno può non funzionare per un altro. Ecco perché offriamo una politica di rimborso semplice e senza problemi.
Per richiedere un rimborso, seguite questi semplici passi:
1. Motivo del rimborso: Inviateci un'e-mail all'indirizzo support@pawital.com entro 30 giorni dall'acquisto, indicando il motivo della vostra insoddisfazione. I motivi possono includere:
2. La restituzione non è necessaria: Se avete ordinato un singolo prodotto, non è necessario restituirlo per richiedere il rimborso. Tuttavia, vi chiederemo di restituire le confezioni non utilizzate.
I rimborsi vengono elaborati entro 3 giorni lavorativi dalla data della richiesta, in modo da garantire che riceviate il vostro denaro senza ritardi.
Come posso richiedere un rimborso?
Se si desidera richiedere un rimborso, è sufficiente inviare un'e-mail all'indirizzo support@pawital.com indicando il motivo della richiesta. Il rimborso verrà elaborato entro 3 giorni lavorativi.
A Pawital siamo convinti della qualità dei nostri prodotti e vogliamo che voi e il vostro amico peloso siate completamente soddisfatti del vostro acquisto. Siamo consapevoli che ogni cane è unico e che ciò che funziona per uno può non funzionare per un altro. Ecco perché offriamo una politica di rimborso semplice e senza problemi.
Per richiedere un rimborso, seguite questi semplici passi:
1. Motivo del rimborso: Inviateci un'e-mail all'indirizzo support@pawital.com entro 30 giorni dall'acquisto, indicando il motivo della vostra insoddisfazione. I motivi possono includere:
2. La restituzione non è necessaria: Se avete ordinato un singolo prodotto, non è necessario restituirlo per richiedere il rimborso. Tuttavia, vi chiederemo di restituire le confezioni non utilizzate.
I rimborsi vengono elaborati entro 3 giorni lavorativi dalla data della richiesta, in modo da garantire che riceviate il vostro denaro senza ritardi.
How can I request a refund?
If you want to request a refund, simply email at support@pawital.com and state the reason for your request. We will process your refund within 3 business days.
At Pawital, we stand behind the quality of our products and want you and your furry friend to be completely satisfied with your purchase. We understand that every dog is unique, and what works for one may not work for another. That's why we offer a straightforward, hassle-free refund policy.
To request a refund, please follow these simple steps:
1. Reason for Refund: Email us at support@pawital.com within 30 days of purchase, stating why you are dissatisfied. Reasons might include:
a) No noticeable improvement in your dog’s health or behavior.
b) Your dog dislikes the taste of the product.
c) Any other reason for dissatisfaction.
2. No Return Necessary: If you ordered a single product, there is no need to return it to claim your refund. We will ask you to return the unused packs, though.
Refunds are processed within 3 business days from the date of your request, ensuring that you receive your money back without delay.
How can I request a refund?
If you want to request a refund, simply email at support@pawital.com and state the reason for your request. We will process your refund within 3 business days.
At Pawital, we stand behind the quality of our products and want you and your furry friend to be completely satisfied with your purchase. We understand that every dog is unique, and what works for one may not work for another. That's why we offer a straightforward, hassle-free refund policy.
To request a refund, please follow these simple steps:
1. Reason for Refund: Email us at support@pawital.com within 30 days of purchase, stating why you are dissatisfied. Reasons might include:
a) No noticeable improvement in your dog’s health or behavior.
b) Your dog dislikes the taste of the product.
c) Any other reason for dissatisfaction.
2. No Return Necessary: If you ordered a single product, there is no need to return it to claim your refund. We will ask you to return the unused packs, though.
Refunds are processed within 3 business days from the date of your request, ensuring that you receive your money back without delay.
How can I request a refund?
If you want to request a refund, simply email at support@pawital.com and state the reason for your request. We will process your refund within 3 business days.
At Pawital, we stand behind the quality of our products and want you and your furry friend to be completely satisfied with your purchase. We understand that every dog is unique, and what works for one may not work for another. That's why we offer a straightforward, hassle-free refund policy.
To request a refund, please follow these simple steps:
1. Reason for Refund: Email us at support@pawital.com within 30 days of purchase, stating why you are dissatisfied. Reasons might include:
a) No noticeable improvement in your dog’s health or behavior.
b) Your dog dislikes the taste of the product.
c) Any other reason for dissatisfaction.
2. No Return Necessary: If you ordered a single product, there is no need to return it to claim your refund. We will ask you to return the unused packs, though.
Refunds are processed within 3 business days from the date of your request, ensuring that you receive your money back without delay.
Wie kann ich eine Rückerstattung anfordern?
Wenn Sie eine Rückerstattung anfordern möchten, senden Sie einfach eine E-Mail an support@pawital.com und geben Sie den Grund für Ihre Anfrage an. Wir werden Ihre Rückerstattung innerhalb von 3 Werktagen bearbeiten.
Bei Pawital stehen wir hinter der Qualität unserer Produkte und möchten, dass Sie und Ihr pelziger Freund mit Ihrem Kauf vollständig zufrieden sind. Wir verstehen, dass jeder Hund einzigartig ist und das, was für den einen funktioniert, möglicherweise tut es für den anderen nicht. Deshalb bieten wir eine einfache und unkomplizierte Rückerstattungspolitik an.
Um eine Rückerstattung zu beantragen, befolgen Sie bitte diese einfachen Schritte:
1. Grund für die Rückerstattung: Senden Sie uns innerhalb von 30 Tagen nach dem Kauf eine E-Mail an support@pawital.com und geben Sie an, warum Sie unzufrieden sind. Gründe könnten sein:
2. Keine Rücksendung erforderlich: Wenn Sie ein einzelnes Produkt bestellt haben, brauchen Sie es nicht zurücksenden, um Ihre Rückerstattung zu beanspruchen. Wir bitten Sie jedoch, die unbenutzten und verschlossenen Packungen zurückzusenden.
Rückerstattung wird innerhalb von 3 Werktagen nach Eingang Ihrer Anfrage bearbeitet, sodass Sie Ihr Geld ohne Verzögerungen zurückerhalten.
Wie kann ich eine Rückerstattung anfordern?
Wenn Sie eine Rückerstattung anfordern möchten, senden Sie einfach eine E-Mail an support@pawital.com und geben Sie den Grund für Ihre Anfrage an. Wir werden Ihre Rückerstattung innerhalb von 3 Werktagen bearbeiten.
Bei Pawital stehen wir hinter der Qualität unserer Produkte und möchten, dass Sie und Ihr pelziger Freund mit Ihrem Kauf vollständig zufrieden sind. Wir verstehen, dass jeder Hund einzigartig ist und das, was für den einen funktioniert, möglicherweise tut es für den anderen nicht. Deshalb bieten wir eine einfache und unkomplizierte Rückerstattungspolitik an.
Um eine Rückerstattung zu beantragen, befolgen Sie bitte diese einfachen Schritte:
1. Grund für die Rückerstattung: Senden Sie uns innerhalb von 30 Tagen nach dem Kauf eine E-Mail an support@pawital.com und geben Sie an, warum Sie unzufrieden sind. Gründe könnten sein:
2. Keine Rücksendung erforderlich: Wenn Sie ein einzelnes Produkt bestellt haben, brauchen Sie es nicht zurücksenden, um Ihre Rückerstattung zu beanspruchen. Wir bitten Sie jedoch, die unbenutzten und verschlossenen Packungen zurückzusenden.
Rückerstattung wird innerhalb von 3 Werktagen nach Eingang Ihrer Anfrage bearbeitet, sodass Sie Ihr Geld ohne Verzögerungen zurückerhalten.
Wie kann ich eine Rückerstattung anfordern?
Wenn Sie eine Rückerstattung anfordern möchten, senden Sie einfach eine E-Mail an support@pawital.com und geben Sie den Grund für Ihre Anfrage an. Wir werden Ihre Rückerstattung innerhalb von 3 Werktagen bearbeiten.
Bei Pawital stehen wir hinter der Qualität unserer Produkte und möchten, dass Sie und Ihr pelziger Freund mit Ihrem Kauf vollständig zufrieden sind. Wir verstehen, dass jeder Hund einzigartig ist und das, was für den einen funktioniert, möglicherweise tut es für den anderen nicht. Deshalb bieten wir eine einfache und unkomplizierte Rückerstattungspolitik an.
Um eine Rückerstattung zu beantragen, befolgen Sie bitte diese einfachen Schritte:
1. Grund für die Rückerstattung: Senden Sie uns innerhalb von 30 Tagen nach dem Kauf eine E-Mail an support@pawital.com und geben Sie an, warum Sie unzufrieden sind. Gründe könnten sein:
2. Keine Rücksendung erforderlich: Wenn Sie ein einzelnes Produkt bestellt haben, brauchen Sie es nicht zurücksenden, um Ihre Rückerstattung zu beanspruchen. Wir bitten Sie jedoch, die unbenutzten und verschlossenen Packungen zurückzusenden.
Rückerstattung wird innerhalb von 3 Werktagen nach Eingang Ihrer Anfrage bearbeitet, sodass Sie Ihr Geld ohne Verzögerungen zurückerhalten.
| Bocconcino | |
| Composizione | |
| Salmone | 2,8g |
| Pesce bianco | 2,4g |
| Glicerina vegetale (100% Brassica napus) | 1,39g |
| Patata dolce | 1,07g |
| Zucca | 800mg |
| Buccia di psillio | 270mg |
| Aceto di sidro di mele | 100mg |
| EpiCor® Pets (fermentato di lievito essiccato prodotto con Saccharomyces cerevisiae) | 8750 mg/kg |
| Polvere di alghe marine | 40mg |
| Cicoria | 25mg |
| Cellule inattivate di Bifidobacterium animalis sottospecie lactis (BPL1®) | 17mg |
| Cellule inattivate di Bifidobacterium longum (ES1®) | 17mg |
| Additivi sensoriali | |
| Curcuma | 240mg |
| Additivi tecnologici | |
| 1a330 Acido citrico | 5,5 mg/kg |
| Componenti analitici | |
| Proteina grezza | 22,12% |
| Grasso grezzo | 8,43% |
| Ceneri grezze | 3,03% |
| Fibra grezza | 4,01% |
| Umidità | 25,84% |
| Bocconcino | |
| Composizione | |
| Salmone | 2,8g |
| Pesce bianco | 2,4g |
| Glicerina vegetale (100% Brassica napus) | 1,39g |
| Patata dolce | 1,07g |
| Zucca | 800mg |
| Buccia di psillio | 270mg |
| Aceto di sidro di mele | 100mg |
| EpiCor® Pets (fermentato di lievito essiccato prodotto con Saccharomyces cerevisiae) | 8750 mg/kg |
| Polvere di alghe marine | 40mg |
| Cicoria | 25mg |
| Cellule inattivate di Bifidobacterium animalis sottospecie lactis (BPL1®) | 17mg |
| Cellule inattivate di Bifidobacterium longum (ES1®) | 17mg |
| Additivi sensoriali | |
| Curcuma | 240mg |
| Additivi tecnologici | |
| 1a330 Acido citrico | 5,5 mg/kg |
| Componenti analitici | |
| Proteina grezza | 22,12% |
| Grasso grezzo | 8,43% |
| Ceneri grezze | 3,03% |
| Fibra grezza | 4,01% |
| Umidità | 25,84% |
| Bocconcino | |
| Composizione | |
| Salmone | 2,8g |
| Pesce bianco | 2,4g |
| Glicerina vegetale (100% Brassica napus) | 1,39g |
| Patata dolce | 1,07g |
| Zucca | 800mg |
| Buccia di psillio | 270mg |
| Aceto di sidro di mele | 100mg |
| EpiCor® Pets (fermentato di lievito essiccato prodotto con Saccharomyces cerevisiae) | 8750 mg/kg |
| Polvere di alghe marine | 40mg |
| Cicoria | 25mg |
| Cellule inattivate di Bifidobacterium animalis sottospecie lactis (BPL1®) | 17mg |
| Cellule inattivate di Bifidobacterium longum (ES1®) | 17mg |
| Additivi sensoriali | |
| Curcuma | 240mg |
| Additivi tecnologici | |
| 1a330 Acido citrico | 5,5 mg/kg |
| Componenti analitici | |
| Proteina grezza | 22,12% |
| Grasso grezzo | 8,43% |
| Ceneri grezze | 3,03% |
| Fibra grezza | 4,01% |
| Umidità | 25,84% |
| Leckerei | |
| Zusamemnsetzung | |
| Lachs | 2,8 g |
| Weißfisch | 2,4 g |
| Pflanzliches Glycerin (100% Raps) | 1,39 g |
| Süßkartoffel | 1,07 g |
| Kürbis | 800 mg |
| Flohsamenschalen | 270 mg |
| Apfelessig | 100 mg |
| EpiCor® Pets (getrocknetes Hefefermentat aus Saccharomyces cerevisiae) | 8750 mg/kg |
| Meeresalgenpulver | 40 mg |
| Chicorée | 25 mg |
| Inaktivierte Zellen von Bifidobacterium animalis Unterart lactis (BPL1®) | 17 mg |
| Inaktivierte Zellen von Bifidobacterium longum (ES1®) | 4 mg |
| Sensorische Zusätze | |
| Kurkuma | 240 mg |
| Technologische Additive | |
| 1a330 Zitronensäure | 5,5 mg/kg |
| Analytische Bestandteile | |
| Rohprotein | 22,12% |
| Rohfett | 8,43% |
| Rohasche | 3,03% |
| Rohfaser | 4,01% |
| Feuchtigkeit | 25,84% |
| Leckerei | |
| Zusamemnsetzung | |
| Lachs | 2,8 g |
| Weißfisch | 2,4 g |
| Pflanzliches Glycerin (100% Raps) | 1,39 g |
| Süßkartoffel | 1,07 g |
| Kürbis | 800 mg |
| Flohsamenschalen | 270 mg |
| Apfelessig | 100 mg |
| EpiCor® Pets (getrocknetes Hefefermentat aus Saccharomyces cerevisiae) | 8750 mg/kg |
| Meeresalgenpulver | 40 mg |
| Chicorée | 25 mg |
| Inaktivierte Zellen von Bifidobacterium animalis Unterart lactis (BPL1®) | 17 mg |
| Inaktivierte Zellen von Bifidobacterium longum (ES1®) | 4 mg |
| Sensorische Zusätze | |
| Kurkuma | 240 mg |
| Technologische Additive | |
| 1a330 Zitronensäure | 5,5 mg/kg |
| Analytische Bestandteile | |
| Rohprotein | 22,12% |
| Rohfett | 8,43% |
| Rohasche | 3,03% |
| Rohfaser | 4,01% |
| Feuchtigkeit | 25,84% |
| Leckerei | |
| Zusamemnsetzung | |
| Lachs | 2,8 g |
| Weißfisch | 2,4 g |
| Pflanzliches Glycerin (100% Raps) | 1,39 g |
| Süßkartoffel | 1,07 g |
| Kürbis | 800 mg |
| Flohsamenschalen | 270 mg |
| Apfelessig | 100 mg |
| EpiCor® Pets (getrocknetes Hefefermentat aus Saccharomyces cerevisiae) | 8750 mg/kg |
| Meeresalgenpulver | 40 mg |
| Chicorée | 25 mg |
| Inaktivierte Zellen von Bifidobacterium animalis Unterart lactis (BPL1®) | 17 mg |
| Inaktivierte Zellen von Bifidobacterium longum (ES1®) | 4 mg |
| Sensorische Zusätze | |
| Kurkuma | 240 mg |
| Technologische Additive | |
| 1a330 Zitronensäure | 5,5 mg/kg |
| Analytische Bestandteile | |
| Rohprotein | 22,12% |
| Rohfett | 8,43% |
| Rohasche | 3,03% |
| Rohfaser | 4,01% |
| Feuchtigkeit | 25,84% |
| per treat | |
| Composition | |
| Salmon | 2,8g |
| White fish | 2,4g |
| Vegetable Glycerin (100% rapeseed) | 1,39g |
| Sweet Potato | 1,07g |
| Pumpkin | 800mg |
| Psyllium Husk | 270mg |
| Apple Cider Vinegar | 100mg |
| EpiCor® Pets (Dried yeast fermentate made using Saccharomyces cerevisiae) | 8750 mg/kg |
| Sea kelp powder | 40mg |
| Chicory | 25mg |
| Inactivated cells from Bifidobacterium animalis (BPL1®) | 17mg |
| Inactivated cells from Bifidobacterium longum (ES1®) | 5mg |
| Sensory Additives | |
| Turmeric | 240mg |
| Technological Additives | |
| 1a330 Citric acid | 5,5 mg/kg |
| Analytical Constituents | |
| Crude Protein | 22,12% |
| Crude Fat | 8,43% |
| Crude Ash | 3,03% |
| Crude Fibre | 4,01% |
| Moisture | 25,84% |
| per treat | |
| Composition | |
| Salmon | 2,8g |
| White fish | 2,4g |
| Vegetable Glycerin (100% rapeseed) | 1,39g |
| Sweet Potato | 1,07g |
| Pumpkin | 800mg |
| Psyllium Husk | 270mg |
| Apple Cider Vinegar | 100mg |
| EpiCor® Pets (Dried yeast fermentate made using Saccharomyces cerevisiae) | 8750 mg/kg |
| Sea kelp powder | 40mg |
| Chicory | 25mg |
| Inactivated cells from Bifidobacterium animalis (BPL1®) | 17mg |
| Inactivated cells from Bifidobacterium longum (ES1®) | 5mg |
| Sensory Additives | |
| Turmeric | 240mg |
| Technological Additives | |
| 1a330 Citric acid | 5,5 mg/kg |
| Analytical Constituents | |
| Crude Protein | 22,12% |
| Crude Fat | 8,43% |
| Crude Ash | 3,03% |
| Crude Fibre | 4,01% |
| Moisture | 25,84% |
| per treat | |
| Composition | |
| Salmon | 2,8g |
| White fish | 2,4g |
| Vegetable Glycerin (100% rapeseed) | 1,39g |
| Sweet Potato | 1,07g |
| Pumpkin | 800mg |
| Psyllium Husk | 270mg |
| Apple Cider Vinegar | 100mg |
| EpiCor® Pets (Dried yeast fermentate made using Saccharomyces cerevisiae) | 8750 mg/kg |
| Sea kelp powder | 40mg |
| Chicory | 25mg |
| Inactivated cells from Bifidobacterium animalis (BPL1®) | 17mg |
| Inactivated cells from Bifidobacterium longum (ES1®) | 5mg |
| Sensory Additives | |
| Turmeric | 240mg |
| Technological Additives | |
| 1a330 Citric acid | 5,5 mg/kg |
| Analytical Constituents | |
| Crude Protein | 22,12% |
| Crude Fat | 8,43% |
| Crude Ash | 3,03% |
| Crude Fibre | 4,01% |
| Moisture | 25,84% |
Was sind Postbiotika
Postbiotika sind die nützlichen Nebenprodukte, die von guten Bakterien während der Fermentation produziert werden. Im Gegensatz zu Probiotika, die lebende Bakterien sind, liefern Postbiotika die gesundheitsfördernden Verbindungen direkt in den Darm und sorgen so für maximale Wirksamkeit und Stabilität.
Besser als Probiotika: Postbiotika liefern nützliche Metaboliten direkt in den Darm Ihres Hundes und umgehen dabei die Notwendigkeit für lebende Bakterien.
Klinisch bewiesen: Belly Champ Postbiotika (BPL1, ES1, EpiCor Pets) werden durch über 18 klinische Studien unterstützt.
Überlebensfähigkeit: Im Gegensatz zu Probiotika überleben Postbiotika die Magensäure und erfordern keine spezielle Lagerung.
Konstante gesundheitliche Vorteile: Postbiotika bieten vorhersehbare gesundheitliche Vorteile, fördern die Darmreparatur und stärken das Immunsystem unabhängig von der Mikrobiota Ihres Hundes.
Fortschrittliche Darmgesundheit: Postbiotika helfen, die Darmflora Ihres Hundes wieder ins Gleichgewicht zu bringen, und fördern das allgemeine Wohlbefinden Ihres Hundes.
Was sind Postbiotika
Postbiotika sind die nützlichen Nebenprodukte, die von guten Bakterien während der Fermentation produziert werden. Im Gegensatz zu Probiotika, die lebende Bakterien sind, liefern Postbiotika die gesundheitsfördernden Verbindungen direkt in den Darm und sorgen so für maximale Wirksamkeit und Stabilität.
Besser als Probiotika: Postbiotika liefern nützliche Metaboliten direkt in den Darm Ihres Hundes und umgehen dabei die Notwendigkeit für lebende Bakterien.
Klinisch bewiesen: Belly Champ Postbiotika (BPL1, ES1, EpiCor Pets) werden durch über 18 klinische Studien unterstützt.
Überlebensfähigkeit: Im Gegensatz zu Probiotika überleben Postbiotika die Magensäure und erfordern keine spezielle Lagerung.
Konstante gesundheitliche Vorteile: Postbiotika bieten vorhersehbare gesundheitliche Vorteile, fördern die Darmreparatur und stärken das Immunsystem unabhängig von der Mikrobiota Ihres Hundes.
Fortschrittliche Darmgesundheit: Postbiotika helfen, die Darmflora Ihres Hundes wieder ins Gleichgewicht zu bringen, und fördern das allgemeine Wohlbefinden Ihres Hundes.
Was sind Postbiotika
Postbiotika sind die nützlichen Nebenprodukte, die von guten Bakterien während der Fermentation produziert werden. Im Gegensatz zu Probiotika, die lebende Bakterien sind, liefern Postbiotika die gesundheitsfördernden Verbindungen direkt in den Darm und sorgen so für maximale Wirksamkeit und Stabilität.
Besser als Probiotika: Postbiotika liefern nützliche Metaboliten direkt in den Darm Ihres Hundes und umgehen dabei die Notwendigkeit für lebende Bakterien.
Klinisch bewiesen: Belly Champ Postbiotika (BPL1, ES1, EpiCor Pets) werden durch über 18 klinische Studien unterstützt.
Überlebensfähigkeit: Im Gegensatz zu Probiotika überleben Postbiotika die Magensäure und erfordern keine spezielle Lagerung.
Konstante gesundheitliche Vorteile: Postbiotika bieten vorhersehbare gesundheitliche Vorteile, fördern die Darmreparatur und stärken das Immunsystem unabhängig von der Mikrobiota Ihres Hundes.
Fortschrittliche Darmgesundheit: Postbiotika helfen, die Darmflora Ihres Hundes wieder ins Gleichgewicht zu bringen, und fördern das allgemeine Wohlbefinden Ihres Hundes.
What are postbiotics
Postbiotics are the beneficial byproducts produced by good bacteria during fermentation. Unlike probiotics, which are live bacteria, postbiotics deliver the health-boosting compounds directly to the gut, ensuring maximum efficacy and stability.
Better Than Probiotics: Postbiotics deliver beneficial metabolites directly to your dog's gut, bypassing the need for live bacteria.
Clinically Proven: Belly Champ postbiotics (BPL1, ES1, EpiCor Pets) are backed by over 18 clinical studies.
Survivability: Unlike probiotics, postbiotics survive stomach acid and don’t require special storage.
Consistent Health Benefits: Postbiotics offer predictable health benefits, enhancing gut repair and immunity regardless of your dog's microbiota.
Advanced Gut Health: Postbiotics help re-balance your dog's gut flora, promoting overall well-being.
What are postbiotics
Postbiotics are the beneficial byproducts produced by good bacteria during fermentation. Unlike probiotics, which are live bacteria, postbiotics deliver the health-boosting compounds directly to the gut, ensuring maximum efficacy and stability.
Better Than Probiotics: Postbiotics deliver beneficial metabolites directly to your dog's gut, bypassing the need for live bacteria.
Clinically Proven: Belly Champ postbiotics (BPL1, ES1, EpiCor Pets) are backed by over 18 clinical studies.
Survivability: Unlike probiotics, postbiotics survive stomach acid and don’t require special storage.
Consistent Health Benefits: Postbiotics offer predictable health benefits, enhancing gut repair and immunity regardless of your dog's microbiota.
Advanced Gut Health: Postbiotics help re-balance your dog's gut flora, promoting overall well-being.
What are postbiotics
Postbiotics are the beneficial byproducts produced by good bacteria during fermentation. Unlike probiotics, which are live bacteria, postbiotics deliver the health-boosting compounds directly to the gut, ensuring maximum efficacy and stability.
Better Than Probiotics: Postbiotics deliver beneficial metabolites directly to your dog's gut, bypassing the need for live bacteria.
Clinically Proven: Belly Champ postbiotics (BPL1, ES1, EpiCor Pets) are backed by over 18 clinical studies.
Survivability: Unlike probiotics, postbiotics survive stomach acid and don’t require special storage.
Consistent Health Benefits: Postbiotics offer predictable health benefits, enhancing gut repair and immunity regardless of your dog's microbiota.
Advanced Gut Health: Postbiotics help re-balance your dog's gut flora, promoting overall well-being.
Cosa sono i postbiotici
I postbiotici sono i sottoprodotti benefici prodotti dai batteri buoni durante la fermentazione. A differenza dei probiotici, che sono batteri vivi, i postbiotici forniscono i composti salutari direttamente all'intestino, garantendo la massima efficacia e stabilità.
Migliori dei probiotici: I postbiotici forniscono metaboliti benefici direttamente all'intestino del cane, evitando la necessità di batteri vivi.
Clinicamente provati: I postbiotici Belly Champ (BPL1, ES1, EpiCor Pets) sono supportati da oltre 18 studi clinici.
Sopravvivenza: A differenza dei probiotici, i postbiotici sopravvivono ai succhi gastrici e non richiedono una conservazione speciale.
Benefici per la salute costanti: I postbiotici offrono benefici prevedibili per la salute, migliorando la riparazione intestinale e l'immunità indipendentemente dal microbiota del cane.
Salute intestinale avanzata: I postbiotici aiutano a riequilibrare la flora intestinale del cane, promuovendo il benessere generale.
Cosa sono i postbiotici
I postbiotici sono i sottoprodotti benefici prodotti dai batteri buoni durante la fermentazione. A differenza dei probiotici, che sono batteri vivi, i postbiotici forniscono i composti salutari direttamente all'intestino, garantendo la massima efficacia e stabilità.
Migliori dei probiotici: I postbiotici forniscono metaboliti benefici direttamente all'intestino del cane, evitando la necessità di batteri vivi.
Clinicamente provati: I postbiotici Belly Champ (BPL1, ES1, EpiCor Pets) sono supportati da oltre 18 studi clinici.
Sopravvivenza: A differenza dei probiotici, i postbiotici sopravvivono ai succhi gastrici e non richiedono una conservazione speciale.
Benefici per la salute costanti: I postbiotici offrono benefici prevedibili per la salute, migliorando la riparazione intestinale e l'immunità indipendentemente dal microbiota del cane.
Salute intestinale avanzata: I postbiotici aiutano a riequilibrare la flora intestinale del cane, promuovendo il benessere generale.
Cosa sono i postbiotici
I postbiotici sono i sottoprodotti benefici prodotti dai batteri buoni durante la fermentazione. A differenza dei probiotici, che sono batteri vivi, i postbiotici forniscono i composti salutari direttamente all'intestino, garantendo la massima efficacia e stabilità.
Migliori dei probiotici: I postbiotici forniscono metaboliti benefici direttamente all'intestino del cane, evitando la necessità di batteri vivi.
Clinicamente provati: I postbiotici Belly Champ (BPL1, ES1, EpiCor Pets) sono supportati da oltre 18 studi clinici.
Sopravvivenza: A differenza dei probiotici, i postbiotici sopravvivono ai succhi gastrici e non richiedono una conservazione speciale.
Benefici per la salute costanti: I postbiotici offrono benefici prevedibili per la salute, migliorando la riparazione intestinale e l'immunità indipendentemente dal microbiota del cane.
Salute intestinale avanzata: I postbiotici aiutano a riequilibrare la flora intestinale del cane, promuovendo il benessere generale.

